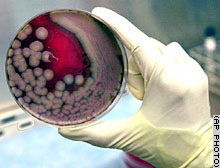

ЕЖЕДНЕВНЫЕ
НОВОСТИ ИСКУССТВА@ARTINFO
В МИРЕ В МОСКВЕ В РОССИИ В ПИТЕРЕ В ИНТЕРНЕТЕ ТЕКСТЫ НАВИГАТОР ОРГАНАЙЗЕР ВЕЛИКАНОВ ЯРМАРКИ ТЕТЕРИН НЬЮС ПЕРИОДИКА ФОТОРЕПОРТАЖИ УЧЕБА РАБОТА КОЛЛЕГИ АРХИВ
АРТ ПЕРИОДИКА - 3 часть <вернуться к 1-й> <вернуться ко 2-й> <перейти к 4-й> <перейти к 5-й>
<<<Cписок on-line версий периодических изданий по искусству и on-line изданий>
| <<Очередной альманах "Азиатско-Тихоокеанское искусство 2008", энциклопедическое 300-страничное издание на английском языке содержит информацию о ведущих галереях, музеях, аукционах, ярмарках, студиях художников в регионе от Израиля до Океании. |
 |
<<Artforum за декабрь 2007. О главных событиях в искусстве в 2007 году. Benjamin H. D. Buchloh выбирает проект Gerhard Richter в Кёльнском соборе (новые витражи на месте разбитых во время войны, фрагмент справа). Tacita Dean - Block Beuys в германском Дармштате (инсталляция Бойса в Hessen’s County Museum). David Rimanelli - Carol Bove. Linda Norden - Robert Gober, ретроспективная выставка в Базеле - один из залов, инсталляция "untitled" - фото внизу> |
 |
 |
<<"Цифровой магазин" Бостонского музея изящных искусств с сентября торгует картинками для мобильных телефонов. В лидерах продаж "Белые лилии" Клода Моне. NYTimes пишет о новом шаге сделанном музеями в освоении новых коммерческих механизмов. В данном случае Бостонский музей, обладающий 350-тысячным банком изображений, включился в мобильный сервис торговли изображениями через так называемый короткий номер - набрал, выбрал, скачал, немножко денег автоматически сняли с твоего счёта у оператора мобильной связи. Как кстати эта публикация - в пятницу 6 декабря мне делать доклад на конференции EVA, об информационных интерактивных сервисах мобильной связи и их использовании на арт сцене, шире - в сфере искусства. |
| Пока еще в таких сервисах практически только "простейшее и простейшие". Но вот вопрос: перевод музейных изображений на столь доступный уровень благо или бедствие для музеев? Помните историю. Услышав 40-ю симфонию Моцарта, подросток говорит: я знаю этого парня, он пишет музыку для мобил. Следует иметь в виду, что доходы в таких сервисах уже считают на десятки миллионов. Ю.П.> |
| <<Андрей Ерофеев о ситуации вокруг выставок "Соц-арт" и "Запретное искусство-2006": "Эта история, публичный скандал вскрыли целый ряд проблем, которые не могут решиться в рамках одной выставки. С одной стороны, международное сообщество интересуется современным российским искусством. Российское общество начало интересоваться современным искусством тоже. Происходящие по вине госчиновников скандалы, схватки не способствуют процессу сближения актуального искусства и зрителей. Запрос на современное российское искусство, увы, не получает сегодня должной поддержки у государственных институций. Мы имеем общество, желающее понимать актуальное искусство, и почти не имеем институций, обслуживающих это искусство" - "Время новостей". Интервью провел С. Хачатуров> |
 |
<<Основной проект 3-й Московской биеннале современного
искусства в 2009 году будет курировать 63-летний Жан-Юбер Мартен, куратор
Национальных музеев Франции, бывший директор парижского Центра Помпиду. Однако в
текущей ситуации вероятно важней, что Мартен входит в состав жюри
Премии Кандинского, в
связи с чем зачастил в Москву, по условиям Премии познакомился с изрядным
количеством работ наших художников. Во время такого приезда
комиссар биеннале Иосиф Бакштейн и предложил ему единолично заняться выставками
нашего главного фестиваля. Может статься, что это главная удача за недолгую пока
историю Московской биеннале - наконец-то прийти к творческому единовластию, да
еще заполучит на эту роль специалиста не только заметного на международной арт
сцене, но и хоть немного знающего нашу. <Ирина Кулик в "Коммерсанте" за 23 ноября 2007 сообщает, что "Третья Московская биеннале, возможно, не единственный проект Жан-Юбера Мартена, который сможет увидеть российская публика... под эгидой Московской биеннале запускается проект "Классика современного искусства", проходящий в очередь с собственно биеннале. В 2008 году первой выставкой из этого цикла должна стать экспозиция, посвященная истории концептуального искусства, курировать которую будут Иосиф Бакштейн и Жан-Юбер Мартен"> |
 |
<<Могут ли музеи и коммерческие
галереи породить коррумпированность современного арт сообщества? -
примерно таким вопрос задается
NY Times, 18 ноября 2007 года. Не
секрет, что галереи стоят в очередь в музеи современного искусства, чтобы на
свои деньги сделать в них персональные выставки своих художников. Именно так
наращивается сейчас символический капитал, а следом - цены на работы
продвигаемых через музейные турне художников. В статье поставлен радикальный
вопрос: могут ли вообще музеи брать деньги от галеристов.
Зачастую проформа формально соблюдается, когда организаторами таких выставок
выступают фонды. Но есть и соответствующая тенденция - за сильной галереей всё
чаще имеется фонд. <“Oval Buddha”, фрагмент огромной выставки Такеши Мураками в музее современного искусства Лос-Анжелеса, финансировавшейся его дилерами из Нью-Йорка, Лос-Анжелеса и Парижа> |
|
<<Появился блог Анны Матвеевой
artopsy.blogpost.com.
Совсем не давно, но уже есть интересные посты: - "Говорят, царь не настоящий!" - о подделках в стокгольмском Moderna Museet, сделанных по указанию его бывшего директора, всемирно известного искусствоведа Понтюса Хюльтена, для выставки в Эрмитаже :) - "Саачи-прокат в Эрмитаже, премия Тернера в ММСИ"; этот материал грех не дать полностью. Выставка американского искусства "USA Today" из коллекции Саачи в Эрмитаже пройдет вовсе не бесследно. В Эрмитаже будет открыт зал Саачи, где будут выставляться работы из его коллекции. Причем Саачи не дарит Эрмитажу какое-то число работ, а будет "давать поносить" напрокат вещи из своей коллекции , и экспозиция в зале Саачи будет регулярно обновляться. Об этом пресс-атташе Саачи сообщил газете Art Newspaper; Эрмитаж пока не дает комментариев этой новости. Вообще мы вступаем в эпоху массированного импорта современного искусства на уровне музеев. В феврале в московский Музей современного искусства прямиком из Тейт приедет ретроспектива главной британской премии в области современного искусства – Turner Prize. В 2008 году в Эрмитаж привезут последнюю нашумевшую работу Дэмиена Херста For The Love Of God – череп, усыпанный бриллиантами только себестоимостью в двадцать миллионов долларов (по сплетням, череп приедет искать себе покупателя – в Европе на невероятно дорогую и, прямо сказать, не лучшую работу Херста желающих не нашлось, а лопающимся от бабла и любящим все броское русским нуворишам он может прийтись по вкусу). |
 |
<<Flash Art International # 257 за ноябрь-декабрь 2007. Тема номера - перформанс в визуальном искусстве. В центре внимания конечно маститые: Mike Kelley, Bas Jan Ader, Vito Acconci, Bruce Nauman, Chris Burden, Guy de Cointet, Paul McCarthy, Tino Sehgal, Catherine Sullivan, но есть кое что и о достижениях нынешних молодых. Есть интервью с Маурицио Каттеланом и старый 80-го текст легендарного Jeffrey Deitch, в котором он рассуждает о соотношении влияния (власти) художников, критиков, дилеров, коллекционеров, - "Who Has The Power?"> |
 |
<<Центр культуры имени Жоржа Помпиду или попросту Бобур вот уже 30 лет возвышается над старинным кварталом Бобур. "Образ Центра Помпиду в релевантных общественных кругах не столь ясен, сфокусирован и понятен, как подобает творческому центру" - говорит 49-летняя Agnès Saal, сменившая на посту генерального директора Центра Bruno Maquart в августе 2007 года. Она считает, что Центру предстоит решить задачу "возвращения себе роли ведущего игрока в современном культурном ландшафте". Выпускница топовой французской школы администраторов Ecole Nationale d'Administration, работавшая советником двух министров культуры Франции, вероятно знает, о чём говорит. |
 |
<<Artforum за ноябрь 2007. Номер ориентированный на персоналии: живописца Mary Heilmann, архитектора Le Corbusier> |
 |
<<В октябре вышел из печати №1 нового журнала о современной фотографии "Ф.". Инициатором его создания и издателем выступил Информационный центр/Бюро «ФотоДепартамент», Санкт-Петербург. Журнал издается на трех языках, что подтверждает его международную направленность и ориентацию на мировые процессы в фотографии и арт-бизнесе. Заказать журнал с доставкой можно на сайте ФотоДепартамента. |
| <<Art Review Power 100 - ноябрьский выпуск, который можно получить бесплатно, представляет 100 наиболее влиятельных персонажей современной арт сцены. |
 |
<<Flash Art International # 256 за октябрь 2007. Тема номера - современное искусство Гпеции. |
 |
<<Artforum
за октябрь 2007 посвящен
арт-аутсорсингу и имеет заголовок Art of Production. Уже
общеизвестен факт, что многие современные художники являются лишь авторами неких
идей, которые воплощают в материалы и инсталляции разнообразные студии,
мастерские и просто нанятые специалисты.
Jeffrey
Deitch считает, что непрерывно
возрастающий "производственный вклад"
заслоняет содержание произведений> <Здесь, на artinfo есть перевод статьи NYTimes об одном из самых востребованных исполнителей, чьими услугами пользуются звезды современного искусства, Константине Божанове. Ю. П. <Wave UFO Марико Мори, поражавшая воображение молодых посетителей 51-й Венецианской биеннале, была изготовлена на нескольких промышленных предприятиях, с привлечением архитекторов, инженеров, композиторов и компьютерных специалистов> |
|
<<"Крылышками
плям-плям", впечатляющая рецензия Никиты Алексеева на
выставку "Новый Ангелариум" в ММСИ
на Ермолавском. Эта выставка, если задуматься, удивительно похожа на тематические советские выставки типа "Комсомол – молодость планеты". Это – "сочинение на заданную тему", которое пишет толпа допущенных к этому мероприятию участников. <Мне несказанно жаль, что Никита Алексеев пишет на gif.ru и на art-times.ru, но не нам. Где ж они, молодые, способные соответствовать? Ю. П.> |
 |
<<67-й номер журнала texte zer kunst. Обсуждение 12-й Документы и новой популярности современного искусства. Формат интервью в теории и на практике. Интервью как критический жанр. Репортажи: Кассель, Мюнстер, Берлин, Нью-Йорк, Лос Анжелес, Лондон, Вена, Цюрих, Гамбург, Кёльн, Базель, Карлсруэ и Оберхаузен. Розалинда Крауз о вытсавке Ричарда Серра в Мома> |
 |
<<109-й номер журнала
Frieze
имеет заголовок "Венеция, Документа,
Мюнстер. 11 реакций". Diedrich Diederichsen,
Jennifer Doyle, Kodwo Eshun, Alex Farquharson, Jorg Heiser, CaoimhМn Mac Giolla
Leth, Helen Molesworth, Olu Oguibe, Daniel Palmer, Polly Staple and Tirdad
Zolghadr. |
 |
<<Artforum
за сентябрь 2007. "Летний фестивальный тур":
Венеция, Кассель, Мюнстер. По этому поводу высказываются куратор прошлой
Документы Okwui Enwezor, редактор Katy Siegel, кураторы Tate Modern
Jessica Morgan и Mark Godfrey, куратор Венецианской биеннале 2003 года Francesco
Bonami, Daniel Birnbaum и другие. Энвезор задается вопросами, не трансформируется ли мир искусства в глобальную арт ярмарку? Не размывается ли кураторская оригинальность и непочтительность под денежным дождем? Язвительная и даже неприязненная реакция части профессионалов на Венецианскую биеннале, Документу и Мюнстерский скульптурный проект - некий сигнал, что парадигма крупномасштабных проектов натолкнулась на айсберг? Утонет ли?> |
 |
<<ArtReview: The Annual - специальный 96-страничный выпуск с работой Thomas Hirschhorn содержить календарь наиболее значимых выставок и фестивалей до июля 2008 года> |
 |
<<100 выпуск ежекартальника, выпускаемого Помпиду центром, посвящен 30-летию Центра. Специально для этого выпуска ряд художников сделали 16-страничный печатный проект> |
 |
<<Flash Art International # 255 июль - сентябрь 2007. Тема номера - современное искусство Южной Кореи. Кроме того, Marina Abramovic, Vanessa Beecroft и Shirin Neshat объясняют, почему они ощущают себя аутсайдерами. И конечно материалы о 52-й Венецианской биеннале и 12-й Документе. |
 |
<<Джозеф Нешватал о книге Жака Рансьера "Jacques Rancière, The Politics of Aesthetics", с послесловием Славоя Жижека. - Continuum Press, London, New York. В блоге на thing.net> |
|
<<Отчет
о торгах современным искусством Сотбис и Кристи в конце июня 2007 г.> Francis Bacon, Self Portrait £21,580,000 Damien Hirst, Lullaby Spring £9,652,000 Lucian Freud, Bruce Bernard £7,860,000 Andy Warhol, Three Marilyns £5,620,000 Francis Bacon, Two Men Working in a Field £5,060,000 Jean-Michel Basquiat, Grillo £4,948,000 Francis Bacon, Landscape with Car £4,276,000 Roy Lichtenstein, Still Life with Stretcher, Mirror, Bowl of Fruit £4,052,000 Jean-Michel Basquiat, Warrior £2,820,000 Gerhard Richter, Teyde-Landschaft (Teyde-Landscape) £2,596,000 |
| <<100 номер журнала BOMB. За 26 лет опубликовано 750 интервью и бесед об искусстве с художниками, писателями, музыкантами, архитекторами. Июнь 2007 года> |
| <<108 номер журнала Frieze (июнь - август 2007) посвящен экологии> |
 |
<<Flash Art International # 254 май - июнь 2007. Специальный репортаж - международные ярмарки Art Basel/ Art Basel Miami Beach, Frieze Art Fair, The Armory Show, ARCO, FIAC. Таким образом обозначены наиболее престижные ярмарки. Есть отклик на 2-ю Московскую биеннале, весьма краткий однако, в ревю...> |
 |
<<Artforum - май 2007. Оп арт на примере 2 выставок: европейской в Schirn Kunsthalle, Frankfurt и американской в Columbus Museum of Art, Ohio. |

|
<<Artforum - март 2007. Жак Рансьер и современное искусство. Известный не только разделением полиции и политики, но и исследованиями взаимоотношений искусства и политики, находящий сходство в разделении чувственного (разделении как разделении участи, но не делении на части) в политическом и эстетическом. "Голос лишенных голоса" практически солирует в этом номере. С ним беседуют Fulvia Carnevale и John Kelsey, приводится его знаменитая лекция 2004 года на открытии 5-й Летней Академии искусств во Франкфурте. Комментируются его идеи, обозреваются публикации. Напомним, что лекцию Жака Рансьера можно было услышать 17 ноября 2006 года в Москве> |

|
 |
<<105 мартовский номер журнала Frieze Тема номера - Феминизм> |
 |
<<Flash Art International # 253, март-апрель не заявляет феминистской темы, но его материалы почти все о женщинах в искусстве. Пожалуй, главное исключение - рассуждения Джерри Зальца об арт рынке> |

|
<<Похоже, что число любителей съездить в Арабские Эмираты может пополнится теми, кому сейчас такая поездка не приходить в голову. Для строительства амбициознейших музейных и выставочных сооружений привлечены звезды первой величины. Guggenheim Museum спроектировал Frank Gehry, классический музей - Jean Nouvel, арт центр - Zaha Hadid, морской музей - Tadao Ando. $27-миллиардный бюджет позволяет многое... Достаточно ли одних денег, чтобы превратить Абу Даби в значимый культурный центр? Поживем увидим. Ю. П. Подробнее о султанских планах - NYTimes> |

|
<<Flash Art № 252 за январь-февраль 2007. В фокусе Китай: художники, галереи, Шанхайская биеннале. Вместе с тем биеннале в Сингапуре, Тайпее и Гуанжоу. Репортаж с 27-й биеннале в Сан-Пауло> |
 <<Президент Центра Жоржа Помпиду Брюно Расин поделился планами глобальной экспансии второго по величине в мире музея современного искусства. "Бобур" отпразднует свое 30-летие 31 января 2007 года. М. Трофименков откомментировал и планы и событие> |
| <<Сергей Хачатуров в газете "Время новостей" подвел итоги 2006 года. К 5 лучшим событиям он отнес выставку "Павел Филонов. Очевидец незримого", новую версию постоянной экспозиции ХХ века в Третьяковской галерее на Крымском валу, персональную выставку Эрика Булатова, тоже в ГТГ на Крымском, конференцию "Создавая мыслящие миры", предваряющую 2-ю Московскую биеннале, с довеском подвальных бесед при свечах на Винзаводе, тоже предваряющих биеннальную выставку "Верю", придуманную Олегом Куликом, и 10-летний юбилей Московского дома фотографии. |
| <В качестве комментария не могу не отметить два обстоятельства. Отсутствие и среди персоналий и среди выставок современных российских художников. Кроме Эрика Булатова, разумеется, но я его отношу к советским и русским, но не российским художникам. Второе - Михаил Пиотровский среди персоналий. Честно скажу, не ведал и не ведаю причин, по которым многие специалисты - подчеркиваю это - именно специалисты по современному искусству называют Пиотровского, когда речь заходит о вкладе музейных работников в систему современного искусства. На мой взгляд, это симптом коллективной болезни. Хотя, надо признать, Хачатуров умница - он и здесь вывернулся, включив в итоги Рембрандта. Тем самым запутав читателя - может итоги-то не современного искусства, а в мировом масштабе и тотально во времени? Но я-то знаю, что все-таки в современном. Была же единственная выставка к 400-летию великого голландца, и куратором ее был Сергей Хачатуров. На FАБRИКЕ. Хорошая выставка, которую как-то почти не заметили. Впрочем как и юбилей Рембрандта. Такие у нас в большинстве своем профессионалы. Сергей - из числа составляющих исключение, и упоминание собственной выставки можно извинить. Конференции я в его итогах не принимаю категорически. Вместо них замечательная выставка Виктора Пивоварова в ММСИ. Вместо Рембрандта и Фостера - и тоже категорически - Владимир Куприянов и Владимир Архипов, успешно представлявшие российское искусство на биеннале в Сингапуре и Сан-Пауло. Ибо если мы не будем отмечать успехи своих на крупнейших фестивалях, грош нам цена. И еще добавляю одну позицию - лучший арт критик Сергей Хачатуров. Добавил бы еще Дмитрия Барабанова, но, увы, с января по август он не вел АРТикуляцию, о чем я жалею больше всех. Ю. П.> |

|
<<В ArtInterview online - выпуск 6 - появилось интервью с Олегом Куликом> |

|
<<Telegraph
о волне интереса к так называемым русским
торгам крупнейших аукционных домов. И
шире - о буме на рынке русского искусства.
Впечатляет, например, десятикратное (!)
превышение эстимэйта на "Русскую
пастораль" Константина Сомова (фото
слева), до 2.7 млн. фунтов стерлингов. Вместе с
тем, со ссылкой не экспертов, таких как
Денис Лукашин, внимание акцентируется на
невероятно высоком проценте подделок в
общем объеме покупок, сделанных новыми
российскими коллекционерами. За последние 2
года доля подделок в общем объеме продаж
достигла 70 процентов. <"Русская пастораль". К. Сомов. 1922> |
|
<<Вышел декабрьский номер журнала ArtForum. Каждый декабрьский номер содержит результаты опроса ведущих художников, критиков, кураторов, которые называют самые значительные события прошедшего года. Всех перечислять не станем, но вот, например, Дэниель Бирнбаум выбрал Cerith Wyn Evans - And if I don’t meet you no more in this world / Then I’ll, I’ll meet you in the next one / And don’t be late, don’t be late, 2006, negative neon, 15 3/4 x 94 1/2" (на фото слева) - Institute of Contemporary Arts, London и Musée d’Art Moderne de la Ville de Paris. С Бирнбаумом отчасти солидарно жюри премии Vincent 2006 включившее Эванса в число номинантов. Chrissie Iles отметила "интеллектуальное шоу "Последние дни британского андеграунда 1978-88" в Kunstverein München. Francesco Bonami - ретроспективу "Fischli & Weiss: Flowers & Questions" в Tate Modern. Все результаты здесь> |

|
<<"Кремлевский распил.
Радикальный российский десант на
крупнейшую ярмарку современного искусства
в Майями". Сергей Хачатуров. "Время
Новостей". 14 декабря 2006 года> <Андрей Филиппов перед своей "Пилой". Майями. 7 - 10 декабря 2006 года> |
|
<<"Внук
скульптора будет отвечать за павильон
России на Венецианской биеннале" - Ирина
Кулик. Коммерсантъ, 27 ноября 2006 - КОММЕРСАНТЪ
№ 221/П (№ 3552) от 27.11.2006. Назначен новый комиссар павильона России на Венецианской художественной биеннале. По решению Федерального агентства по культуре и кинематографии (ФАКК) эту должность занял Василий Церетели, исполнительный директор Московского музея современного искусства, внук президента Российской академии художеств Зураба Церетели. Василий Церетели родился в 1978 году. В 2000 году он окончил Высшую школу визуального искусства в Нью-Йорке и получил степень бакалавра изобразительных искусств. По возвращении в Москву он был в 2002 году назначен исполнительным директором Музея современного искусства, которым руководит его дед Зураб Церетели. Деятельность господина Церетели-младшего, по мнению многих экспертов, была плодотворной. "За последние годы музей эволюционировал в положительную сторону,– заявил Ъ комиссар Московской биеннале современного искусства Иосиф Бакштейн.– Выставки, организованные в музее за последние годы, соответствуют мировым представлениям о художественном процессе. В этом несомненная заслуга и Василия Церетели". На посту комиссара российского павильона в Венеции господин Церетели-младший сменил Евгения Зяблова, директора Государственного музейно-выставочного центра РОСИЗО. Василий Церетели назначен комиссаром пока что только на один год – на ближайшую Биеннале современного искусства, которая открывается в Венеции в июне следующего <2007> года. Венецианская биеннале – старейшая в мире регулярная международная художественная выставка. Она проходит каждые два года начиная с 1898-го (эта периодичность нарушалась только в годы первой и второй мировых войн). С 1980 года проводятся и архитектурные биеннале. Биеннале устроена по принципу национальных представительств. Павильон России появился в Венеции одним из первых – в 1914 году. По словам заместителя начальника управления современного искусства ФАКК Александра Заволокина, "Евгений Зяблов попросил, чтобы его освободили от обязанностей комиссара российского павильона в связи с большой занятостью: в ближайшее время он в качестве директора Государственного музейно-выставочного центра РОСИЗО будет заниматься программой "Года Китая в России". К тому же господин Зяблов должен завершить процесс перевода российского павильона в управление ФАКК: ранее павильон находился в ведении МИДа и "Росзагрансобственности". Александр Заволокин сказал Ъ, что одним из решающих факторов назначения Василия Церетели комиссаром было то, что тот обещал найти спонсорские средства, достаточные для осуществления качественного выставочного проекта. Государство способно выделить на российскую экспозицию €50-70 тыс. Что недостаточно: например, для проекта, представленного на прошлой Венецианской биеннале (напомним, что его кураторами были Любовь Сапрыкина и Ольга Лопухова, представившие мультимедийные инсталляции московской группы "Эскейп" и нижегородского объединения "Промыза"), потребовались еще спонсорские €160 тыс. Василий Церетели не будет совмещать обязанности комиссара и куратора. Утверждение куратора и участников проекта также входит в полномочия ФАКК. Однако известно, что новый комиссар уже предложил свою кандидатуру куратора – директора Московского дома фотографии Ольгу Свиблову. Официальное назначение еще не произошло, однако господин Заволокин сказал, что возражений у ФАКК не будет, ведь госпожа Свиблова – "личность, несомненно, масштабная". Сам проект экспозиции должен быть предложен на рассмотрение к 10-11 декабря. Ольга Свиблова сообщила Ъ, что, хотя разговоры о ее возможном кураторстве ведутся еще с лета, пока никакого официального предложения ей не сделали, она не считает возможным комментировать свои планы в связи с Венецией. Также она отметила, что вообще-то куратора хорошо бы назначать по крайней мере за год и уже сейчас времени остается очень мало. Василий Церетели сообщил Ъ, что первое, что он собирается сделать в связи со своим новым назначением,– это отправиться в Венецию и разобраться с состоянием самого павильона, который, как он предполагает, нуждается в ремонте. Он сказал, что ему нравятся выставки, которые делает Ольга Свиблова: "Она способна придумать для биеннале по-настоящему сильную экспозицию". Впрочем, по словам Василия Церетели, собственно выставочные проекты они пока еще не обсуждали и ни о каких конкретных художниках не говорили. Новый комиссар российского павильона хочет увидеть в нем прежде всего работу с пространством и считает, что уместнее всего там будет проект, связанный с фото и видео. |

|
<<Музей американского искусства Whitney расширяется. Железнодорожная ветка High Line демонтируется, и новое здание Whitney появится в ее начале. Руководство музея, похоже, обыграло Dia Foundation, планировавшего строительство на этом же месте. Уже есть договоренность с архитектором Renzo Piano о проектировании нового здания и стеклянных мостов, которые соединят его с нынешним, построенным в 1966 году по проекту Marcel Breuer'а. Ключевой персонаж в этом решении - глава Правления музея, коллекционер и миллиардер Леонард Лаудер, хотя новый проект обязательно пройдет через публичное обсуждение> |

|
<<Flash
Art № 251 за ноябрь-декабрь 2006. В фокусе
Румыния и тема номера "Периферия и Центр".
Арт критики, кураторы и художники отвечают
на простой вопрос: проигрывает ли
художник живущий вдали от таких центров
как Нью-Йорк, Лондон, Москва, Пекин, Лос-Анжелес?
Кроме того - 2-я часть путешествия "Косово
- Калининград", по арт пространствам
Болгарии, Украины, Эстонии, России и Польши> <Flash Art на русском языке - #1 - 1989 год> |

|
<<6 выпуск Art Review: Digital доступен онлайн в полном объеме. Надо только зарегистрироваться. Так выглядит реклама дуэта Виноградов-Дубосарский и московской галереи XL, погламурней глянцевых журналов...> |

|
<<На ноябрьских торгах "Импрессионизм и модерн" Кристи установлен очередной рекорд, $491 миллион. Почти на полмиллиардную сумму были проданы 84 лота. Предыдущий рекорд $269 миллионов был установлен в мае 1990 года> |
| <<CTHEORY - Julian Jonker "Ремикс с Юга и Реквием по бесчисленным предкам". О книге Paul D. Miller, Rhythm Science, Cambridge: The MIT Press, 2004> |

|
<<Artforum - ноябрь 2006. Интервью с Аленом Бадью. И не про что-нибудь, а про фундаментальный труд Бадью 1988 года "Бытие и событие" (кстати, по сей день не переведенный на русский язык; на Amazon $20 в твердом переплете) и новейшую книгу "Логика миров". Из беседы можно узнать о взглядах Бадью на искусство, в том числе современное, которое, как известно, он относит к одной из 4 родовых процедур философии, "поэме"; наряду с матемой (то бишь наукой), политикой (исключительно - изобретенной) и любовью (в лакановском понимании)> |

|

|
<<24-25 ноября 2006 года предстоит коллоквиум по книге Alain Badiou "Logiques des Mondes" - в Американском университете Парижа> |

|
<<9
выпуск "Синего дивана".
Редактор Елена Петровская. Институт "Русская
антропологическая школа". Предисловие
редактора и содержание> Этот номер назван «специальным» – «спецвыпуском», как принято говорить на журналистском языке. Это так, ибо посвящен он от начала до конца одному-единственному человеку, который в этом году отмечает свой юбилей. Заглянувший в оглавление сразу же поймет, что речь идет о Валерии Подороге> |
|
<<9
выпуск "Синего дивана".
Редактор Елена Петровская. Институт "Русская
антропологическая школа". Предисловие
редактора и содержание> Этот номер назван «специальным» – «спецвыпуском», как принято говорить на журналистском языке. Это так, ибо посвящен он от начала до конца одному-единственному человеку, который в этом году отмечает свой юбилей. Заглянувший в оглавление сразу же поймет, что речь идет о Валерии Подороге> |
|
<<12 - 15 октября прошла лондонская ярмарка современного искусства Frieze Art Fair, в рамках которой также состоялись Frieze Commissions, Frieze Talks и Cartier Award. Frieze Commissions - некоммерческие проекты и программа Artists Cinema. Первый обладатель Cartier Award Mika Rottenberg представит видео инсталляцию. Frieze Talks - лекции, дискуссии, осуждения. Темы: вкус, перформанс, критичность, архитектура и атмосферность> |
|
<Московская галерея XL - стенд Е13. Новые работы О. Кулика, Виноградова
& Дубосарского, Чернышева&Шульгина, Кориной, Монро и И. Макаревича.
Работа из серии "Подводный мир"
Виноградова, Дубосарского куплена
голландским музеем за 65000$. В первый же день
были проданы 2 работы Михаила Косолапова.
Проданы все бывшие в наличии 15 экземляров
"Медиа-зеркала" Алексея Шульгина и "Фото-видео"
Аристарха Чернышева. На FIAC нечего везти.
Проданы 3 "Фрагмента" и другие работы
Олега Кулика, одна - Влада Монро> |
|
<"Запатентованный
скандал". "Время
Новостей". 19 октября 2006 года. |

|

|
<<250 номер журнала Flash Art, октябрь 2006 года. Тема - Лондон. Биеннале в Сиднее и Санта Фе. Художники - TOP 100. Два отдельных голосования: арт критиков и кураторов + галеристов. |

|
<<Artforum
- октябрь 2006. Обстоятельная беседа с Крисом
Офили (Chris
Ofili) "Живописцы и
Живопись": о старомодной живописи,
абстракция и фигуратив etc. <"The Upper Room" Офили с 13.10.2005 до 1.01.2007 в Tate Modern. Другие работы в коллекции Tate> <АРТикуляция #55 о выставке "The Upper Room": Слоновий навоз с подсветкой. Обезьяний легион. Психоделический формат Криса Офили> |

|
| <<Culturetv обзавелось новостным блогом. Среди сообщений конца сентября Documenta 12, коммерческие успехи молодежи, гламур и Пикассо etc. Стоит изредка заглядывать> |
 
|
<<Академия
художеств в Лейпциге, похоже, становится
туристической меккой. Еще 2-3 года назад
казавшееся чопорным, если не мертвым,
академическое изобразительное искусство,
становится более, чем востребованным. Чуть
ли не ежедневно к студиям
восточногерманской Академии
прибывают туристические автобусы с
желающими если не купить или застолбить
какую-либо работу, то хотя бы увидеть.
Америка побогаче, поэтому оттуда ехать не
обязательно. По городам США двинулась
выставка "Жизнь и Смерть: Новая
лейпцигская живопись", в которую
включены работы 7 художников, выпускников
Академии. В Вашингтоне выставка произвела
столь сильное впечатление, что газета
Cristian Scienсe Monitor называет ее "первым
неподдельным феноменом искусства XXI
века" (!). Столичную публику очаровали
"угрюмые пейзажи, городские сцены,
безлюдные интерьеры, чувствительность
позаимствованная из нуар-кино" мастерски
исполненные учениками Neo Rauch. До Вашингтона
выставка была показана в Кливленде.
Инициаторы турне коллекционеры: Дон и Мира
Рубель из Майями и Майкл Овитц из Лос-Анжелеса,
собирающие работы из Лейпцига уже с 2003 года.
Недавно к ним присоединился
небезызвестный Чарльз Саатчи. Так что,
по всей видимости, дело пойдет. Во всяком
случае, вопреки совершеннейшей
поперечности трендам современного
искусства, скорее, именно благодаря ей, а
также славной истории "святого места
фигуративного искусства", игнорирующий
концептуализм, new media art и инсталляции
Лейпциг уже оказывается в фокусе медийного
и коллекционерского внимания. Cправка о делах профессора Rauch. Лейпцигский галерист заявил, что очередь на работы мэтра составляет 600-700 человек. А последняя продажа на Sotheby's в 2006 году достигла $844,444> <Пара работ выставки "Жизнь и Смерть: Новая лейпцигская живопись"> |

|
<<Давненько не ссылались на
Джерри Зальца.
Исправляемся. 21.09.2006
в Village Voice он анализирует женское
присутствие в арт институциях Нью-Йорка.
Выясняется, что из 125 хорошо известных
галерей Манхеттена 42% принадлежат женщинам.
Либо единолично, либо на паях. С выставками
похуже. Из 297 персональных выставок
современных художников за период с
прошлого 31 декабря только в 23 процентах
выставок солировали женщины. С 2000 года в
музее Гугенхайм только 19 % персональных
выставок - женщин художников. Подзаголовок статьи достаточно резкий - "Art and apartheid: The prime real estate is still a men's club"> <Ссылка с портрета на материалы двух чатов с Зальцем 2004 года. Небезинтересно> |

|
<<Интервью
Чарльза Саатчи Гардиан. Самый ненасытный
коллекционер современного искусства,
сделавший целое поколение молодых
британских художников брендом YBA. Теперь он
открывает новый
амбициозный веб сайт, шоу
в Королевской Академии и галерею в Челси.
Саатчи возвращается - так начинает
интервьюер Гардиан Стюарт Джефрис. Как
многие сетует на то, что Саатчи трудный
интервьюируемый. Если уж коллекционер не
ходит на открытия своих выставок, объясняя
это тем, что "я не хожу на чужие открытия,
поэтому сделал тоже самое по отношению к
самому себе", что уж говорить об интервью.
"Я не даю интервью, потому что получаюсь в
них скользким типом". Кому ж такое
нравится. Но на этот раз 3 очень важных
события вынудили его на интервью. |
|
На своем новом
сайте он планирует (прямо как www.artinfo.ru
в 1996 году :) демонстрировать работы более,
чем 10000 художников. "Моя маленькая мечта
сделать из этой затеи сообщество
художников, чтобы художникам не надо было
платить дилерам 50%". О как заговорил!
Повторюсь, прямо нашими словами 96 года :) Сам-то
просто скупал выставки "на корню",
пугая одних и радуя других. Часть других
радовалась не зря: именно ненасытное
внимание Саатчи сделало Дамиена Херста,
Трейси Эмин, братьев Чэпменов богатыми и
знаменитыми. Судя по обещанию Саатчи ничего
не покупать на собственном сайте, подобная
участь онлайновым фигурантам не грозит. Однако, переключился на британскую молодежь Саатчи только в 90-е. Переключился с не меньшим пылом и удачливостью, чем в пиар компанию Маргарет Тетчер, которой рулил с братом (Saatchi&Saatchi). В итоге - знаменитая выставка 97 года Sensation в Королевской Академии (и здесь), закрепившая YBA как бренд. Теперь все знают имена YBA, а вот тем, чьи работы купленные чохом, потом распродавал по дешевке, он бесповоротно сломал карьеры. Впрочем, это вполне в духе тетчеризма. Начинал Саатчи с того, что в 1985 открыл галерею в St John's Wood и показывал британцам Энди Уорхола, Сола Ле Витта, Брюса Наумана, Ричарда Серра и Джефа Кунса. Вот и теперь, наигравшись в игрушки YBA, он переключился на живопись. В интервью он много рассуждает на эту тему. Однако две выставки "Триумф живописи" в его лондонском County Hall не были приняты арт критиками. В основном резюме такое: тема - welcome, но подбор художников никуда не годится. Кто-то даже резюмировал: сформировать вкус у Саатчи получилось, а вот следовать вкусу - нет. Теперь Саатчи не видит "внятных" молодых британских художников, винит художественное образование, которое за последние 6 лет совсем ослабло. И принялся покупать в США, считая, что сейчас ситуация в тамошнем искусстве напоминает английскую начала 90-х (?). С 6 октября 2006 года Королевская Академия покажет выставку "USA Today", составленную из последних приобретений Саатчи. Такой интерес к нынешнему американскому искусству подтолкнул его обзавестись галерей в Челси. Она будет готова в июне 2007 года. Однако начать там он планирует с китайского искусства. Его лондонская галерея ни у публики, ни, тем более, у критиков не пользуется особой симпатией. Саатчи сердится: "арт сообщество повернуто на идее галереи как "белого куба", и когда они видят деревянные панели стен, это уже не галерея". Но упрямо планирует очередную выставку "Триумф живописи", с 12 сентября по 12 апреля 2007 года. Не знаю, получился ли в моей выжимке из интервью "скользкий тип". Специальной цели сделать это не было, уверяю. Ю. П.> |

|
<<В "Триумфе
живописи" #6 в лондонской галерее Саатчи с
12 сентября 2006 по 12 апреля 2007 года участвуют 2
работы дуэта Дубосарский& Виноградов> |

|
<<Подборки Гардиан: о
галерее Саатчи, коллекция
Саатчи>
<<Избранные
(в изрядном количестве) работы Бориса
Михайлова на сайте Саатчи. В приведенном перечне
линков на материалы о Борисе Михайлове ни
одного российского> |
|
<<Иосиф Бакштейн: Участь
современного искусства - заметки на полях. Интервью
для газеты "Время Новостей" 5
сентября 2006 года. "Со стороны
Кузнецкого моста <к ЦУМу> пристраивается
новое здание. Так совпало по времени, что
перед биеннале окончатся строительные
работы, но еще не начнутся работы по
оформлению интерьеров. Благодаря компании
Mercury это здание нам предоставят. Для
искусства будет идеальный вариант: бетон,
опоры, -- такой стильный и модный
индустриальный минимализм. Биеннале займет
два этажа. Площадь каждого - 3-3,5 тыс. кв.
метров". Полностью> <<К кураторам прошлой биеннале добавились Гуннар Кваран и Фулия Эрдемчи. Подробнее о 1-й пресс-конференции> |

|
<<101 номер журнала Frieze Тема номера - образование. Прямо в пандан московской конференции. В героях номера также Джонатан Меезе, недавно побывавший с выставкой в московской Риджине> |

|
<<Power 100 от ArtREview
в ноябрьском выпуске. Появится в продаже с 14
октября. А пока TOP10 2005: 1. Damien Hirst, artist, Uk (фото слева) 2. Larry Gagosian, dealer/ gallerist US 3. Francois Pinault, owner of Christie's /collector, France 4. Sir Nicholas Serota, Tate director, Uk 5. Glenn D Lowry, MoMA director, US 6. Eli Broad, collector/ philanthropist, US 7. Sam Keller, Art Basel director, Switzerland 8. Iwan Wirth, dealer/ gallerist, Hayser and Wirth, Switzerland 9. Bruce Nauman, artist, US 10. David Zwirner, dealer/ gallerist, US> |
| <<Художники - блоггеры полны новых надежд на демократизацию искусства и даже на избавление от давления дилеров и галерей. Как это знакомо по 96 - 97 годам:) Когда мы в artinfo тоже были полны надежд, что наш онлайновый инструмент радикально поможет художникам. Некоторую роль блоги конечно сыграют. Причем не только для художников, но для активных и артикулированных фигурантов, в той или иной степени заинтересованных в том, чтобы стать известными в определенной культурной страте. В нашем случае - современного искусства. Если в 90-е надо было приехать в Москву и тусоваться в нужных местах, то теперь такими местами становятся блоги. Модную тенденцию можно отслеживать по Марату Гельману, galerist' у в lj. Это как раз к вопросу о том, кто в большей степени может выйграть в блогах. О некоторых удачливых художниках - блоггерах - USAtoday> |
| <<Лондонская Times приводит некоторую информацию о российском арт рынке. В первую очередь - об успехах недавно открытого московского представительства Sotheby’s, общий объем продаж которого за 6 месяцев составил почти 60 миллионов фунтов стерлнигов. В то время как продажи русского искусства на Sotheby’s не превышают 4 миллионов фунтов за все 2000 годы. Объяснение приводится простое. Олигархическая прослойка уже накупила домов и яхт и теперь взялась за статусное потребление искусства. Автор статьи находит в этом немало сходств с поведением американских богатеев начала ХХ века. Подробнее> |
 
|
<<Спустя более, чем 40 лет после
прекращения строительства церкви по
проекту Ле Карбюзье, здание все-таки
достроено. Вверху фото недостроенного
объекта, внизу - нынешнее. Статья в NYTimes> |
|
<<8
выпуск "Синего дивана".
Редактор Елена Петровская. Институт "Русская
антропологическая школа". Предисловие
редактора> * Алексей Пензин Общим в концепциях Вирно и Негри–Хардта является сложная разработка основного понятия, которая развивается, по крайней мере, в трех измерениях. Оно имеет классовый аспект и дополняет традиционное понятие рабочего класса, охватывая весь спектр труда – от традиционного индустриального и аграрного до сервисного, коммуникативного, интеллектуального и даже «аффективного». В политическом плане множества противопоставляются концепции народа-суверена как легитимирующей основы новоевропейских национальных государств. Наконец, в социальном плане это понятие отличается от понятия масс как проявления уходящего в прошлое стандартизированного «фордистского» общества с его конвейером и машинным производством. <Паоло Вирно - Тексты, интервью, полный английский текст "A Grammar of the Multitude"> * Денис Скопин "Vita post mortem, или О двух последних книгах Делёза ". Французских читателей Делёза можно условно поделить на категории. Первая включает в себя несколько «подгрупп». Во-первых, это всевозможные философские «дилетанты», любовно окрестившие мэтра « notre Gilles »: молодежь, которую привлекает неакадемический тон и «антиинституциональная» направленность его книг, а равно внешний вид Делёза – типичного представителя парижской богемы, более похожего на SDF*, чем на профессора, каковым он в принципе никогда не переставал быть, обладая, впрочем – в отличие от чересчур академичных коллег, – безупречным чувством конъюнктуры своего времени; это различная «цветная» публика, почему-то считающая его «своим» – к примеру, «черные», смотрящие «Азбуку Жиля Делёза» в центре Помпиду и составляющие отныне большинство студентов родного для Делёза университета Париж-8. Ко второй категории относятся «университарии», более солидные и искушенные люди, занимающиеся философией Делёза большей частью в силу того, что она пересекается с областью их профессиональных интересов, например, киноведением, литературоведением или искусствоведением. Сама философия Делёза давным-давно перестала для них быть чем-то заслуживающим внимания в силу своей новизны, и любой занимающийся ею, напротив, вызывает легкое раздражение и рискует попасть в поле их снобизма либо как безнадежный интеллектуальный провинциал (наподобие корейцев или поляков, едущих во французские университеты, чтобы писать свои диссертации), либо как несерьезный «любитель», прельщенный цветистым словарем Делёза с его «анархизмом желания» и «машинами войны». Наконец, есть сравнительно немногочисленный круг философских профессионалов, занимающихся Делёзом как темой. |

|
<<В июле снова вышел журнал
Art Review. Августовский
номер "Зеленый" - "Enviromental": "Может
ли искусство сохранить планету?". Вот так,
ни много, ни мало. Редактор Mark
Rappolt максималист и в
оценке перспектив журнала - только
лидерство в современном искусстве, никак не
иначе. Помимо основной темы номер содержит арт путеводитель по Амстердаму. |

|
<<249 номер журнала Flash
Art (июль - сентябрь) посвящен современному
французскому искусству. 50 имен, из которых
особое внимание уделено шестерым: Marcelline
Delbecq, Vincent Lamoroux, Loris GrИaud, Guillaume Leblon, Vincent Olinet and
Zoulikha Bouabdellah. |
| <<Империя Гугенхайм никак не уймется в экспансии. Следом за корейскими и латиноамериканскими попытками построить следующий музей Гугенхайм, настал черед стран, где к визуальному, мягко говоря, особое отношение. Все тот же Фрэнк Гери (см Gehry: King of pop architecture) проектирует новый музей для Абу Даби. По плану музей в 30 тысяч квадратных метров будет готов к 2011 году. BBC> |

|
<<Впервые за 24 года церемония Turner
Prize за 2007 год пройдет не в Лондоне, а в
Ливерпуле. Не в Tate
Britain, а в Tate
Liverpool. В поддержку статуса культурной
столицы Европы 2008 года. Guardian> Напомним шорт-лист Turner Prize 2006. Tomma Abts, Phil Collins, Mark Titchner и Rebecca Warren. Выставка номинантов пройдет в Tate Britain с 3 октября по 21 января 2007 года. Gordon’s gin выделил 40000 фунтов, из которых 25 тысяч достанутся победителю, а по 5 - номинантам. Победитель будет объявлен на церемонии 4 декабря, которая, как всегда, будет транслироваться по Channel 4. Жюри этого года выглядит так: Lynn Barber, Observer; Margot Heller, директор South London Gallery; Matthew Higgs, директор и куратор White Columns, New York; Andrew Renton, Goldsmiths College; Nicholas Serota, директор Tate, председатель жюри> <Mark Titchner. If You Can Dream It, You Must Do It, 2003> |
|
<<Art
News опубликовал Top 200 коллекционеров. 122
коллекционера, которые были в списке Art News
1996 года, сейчас отсутствуют. Первая
десятка такова
(расположение внутри десятки по алфавиту): 1. Debra и Leon Black (Нью-Йорк; старые мастера, импрессионизм, китайская скульптура, современное искусство) 2. Edythe и Eli Broad (Лос Анжелес; современное искусство) 3. Steven Cohen (Гринвич, Коннектикут; импрессионизм, модерн и современное искусство) 4. Jo Carole и Ronald Lauder (Нью-Йорк, Палм-Бич, Париж; 19 и 20 век, старые мастера) 5. Summy Ofer (Лондон, Моте-Карло, Тель Авив, Нью-Йорк; модерн и современное искусство) 6. Francois Pinault (Париж, современное искусство) 7. Mitchell Rales (Вашингтон; модерн и современное искусство) 8. Chartles Saatchi (Лондон; современное британское искусство) 9. Abigail и Leslie Wexner (Огайо и Лондон; модерн и современное искусство) 10. Elaine и Stephen Wynn (Невада; импрессионизм, модерн и современное искусство; владелец казино в Лас-Вегасе :) |
|
<<Обозреватель
Гардиан рассуждает о русских
коллекционерах, которые в значительной
степени способствуют росту цен на арт рынке.
Источник для подобных выводов - результаты
торгов Sotheby's 19 июня (импрессионизм и модерн)
- 88.7 млн. фунтов общий объем торгов, полотно
Модильяни продано за 16.3 млн. фунтов; Christie (также
импрессионизм и модерн) 20 июня; Sotheby's 22 июня (современное
искусство) - c рекордными ценами на работы
Дэвида Хокни, Ансельма Кифера и Рейчел
Уайтрид; Christie (также современное искусство)
23 июня. Впрочем, европейский президент
Кристи Jussi Pylkkanen утверждает, что "все
здесь (в Лондоне) говорят о русских". Во
всяком случае главными игроками сегодня он
считает коллекционеров из Азии, Ближнего
Востока и России. Ко-директор лондонской ярмарки Frieze полагает, что если в 80-90-е годы большие деньги тратились на недвижимость, на антиквариат, на то, что можно назвать "вещами предков", то теперь ситуация изменяется. Тон задает поколение "wallpaper" (совсем не годится по-русски - "обои"). Один из руководителей Christie's считает, что трата денег на искусство более изысканна, нежели на вульгарности. А Pylkkanen уверен, что в ближайшей перспективе бум на арт рынке будет продолжаться, так как глобализирующийся рынок пока не предъявляет признаков нестабильности> |
| <<Не только музеи, но и галереи, во всяком случае европейские переживают "кризис приобретений", вызванный небывалой перегретостью арт рынка, в условиях которой цены становятся неприемлемо высокими. Observer. 25 июня 2006> |
| <<"Монсеньор Отто Мауэр дает исторический урок здравомыслия и толерантности. Нашу власть и церковь конечно же надо учить, но как их учить, если наказать их нельзя, а степень их самодовольной и самодостаточной ограниченности такова, что исключает саму возможность безнаказанно обращаться в их сторону, не говоря о возможности диалога." - "Открывая Вену", Александр Евангели на Gif.ru о выставке «Искусство ХХ века. Взгляд из Вены». Из коллекции Монсиньора Отто Мауэра. Которая проходит в ММСИ на Петровке до 30 июня 2006 года> |
<<Инфекция дезертирства
поражает Челси (район сосредоточения
галерей современного искусства в NY).
Добившиеся определенного успеха художники
бросают своих дилеров, уходя в галереи с
лучшими выставочными пространствами,
связями с музеями и, что вероятно наиболее
существенно, - с налаженной
звездоделательной технологией.
Проблема в том, что изначально пестующие
художников дилеры могут оказаться без
достаточных для развития своей
деятельности средств. Арт мир становится
такой же жестокой и неприятной индустрией
как все - сетует Эд Руша (Ed Rusha), приводя в
пример свою ветхозаветную ситуацию. Когда
Гагосьян проявил к нему интерес, то стал
работать с ним в кооперации с прежним
дилером Лео Кастелли. И только после смерти
Кастелли заключил с художником
эксклюзивный договор. Теперь же сеть
Гагосьяна вычерпывает представляющих
коммерческий интерес художников,
исключительно оптимизируя собственные
издержки.  Статья в NYTimes написана Dorothy Spears, работавшей у Лео Кастелли с 86 по 90 годы. В годы, которые теперь видятся ей и многим дилерам как более адекватные развитию искусства> |
|
<<На завершившейся 18 июня
ярмарке ArtBasel-2006
беспрецедентную активность проявили
американские музеи. Из европейских только
частные François Pinault’s Palazzo Grassi, галерея Charles
Saatchi и португальский José Berardo институт
тягались с ними. Например, François Pinault купил Three Heads Fountain
(Three Andrews) Брюса Наумана (2005) за 900000 долларов.
Однако более крупные и знаменитые,
пользующиеся государственной поддержкой
европейские музеи оказались в стороне,
жалуясь на сокращение бюджетов на культуру
в большинстве европейских стран. Подробнее
в ArtNewsPaper> <Karel Funk (Канада), Untitled #19, 2006, купленная Whitney Museum у галереи 303 за 40000 долларов> |
|
<<salnikov_vova
- ЖЖ - Новая экспозиция в ГТГ на Крымском валу,
10/ Владимир Сальников: "...исторической аберрации противостоит экспозиция современного искусства. Здесь явно другой рассказчик – вменяемый. Он не поленился – и классифицировал экспонаты. Разобрал их не только хронологически, но и на течения – кинетизм, научная абстракция, поп-арт, конецептуализм, нью-вейв, тотальная инсталляция... Поместил их названия рядом с произведениями, написал объяснительные тексты. Довел рассказ до сегодняшнего дня. Из экспозиции понятно, из каких предшествующих выставок эта экспозиция происходит. Значит, необходимая научная работа проведена. Другое дело, что можно соглашаться или не соглашаться с концепцией ее авторов, классификацией и терминологией. Ну, так это и есть предмет их авторской ответственности". <<"Музей личной инициативы". 150 лет Третьяковской галерее. - Сергей Хачатуров, "Время Новостей". Интервью с Андреем Ерофеевым, одним из авторов реорганизации постоянной экспозиции искусства XX века, руководителем отдела новейших течений ГТГ: -- Общая ситуация с современным искусством в России вас устраивает? -- У меня такое чувство, будто я сижу в вагоне едущего поезда, и через перрон вижу мчащийся в обратном направлении другой железнодорожный состав. Этот состав -- общая ситуация в стране, тянущая нас в прошлое. А наш поезд (современное искусство) все еще бодро движется вперед. И из-за встречного движения, кажется, что мы едем еще быстрее, еще веселее, чем на самом деле. |
| <<Японский двуязычный журнал современного искусства ART iT взят на дистрибуцию лидером в этой области Ingram Periodicals Inc. То есть теперь он появится во всех подходящих магазинах, арт институциях etc - на всей территории США и Канады> |
| <<Обзор весенних аукционных торгов 2006 года от NYTimes> |
|
<<В Одессе завершились
съёмки нового фильма Киры Муратовой "Ещё
две истории: одна простая, другая сложнее" http://www.arthouse.ru/news.asp?id=2597 |
| <<ArtNewsPaper о галерейном буме во Франции. Опрос 230 из 375 членов профессиональной ассоциации галеристов дал ошеломляющий результат. Что галереи продали в 5 раз больше, чем аукционные дома. 640 млн. евро против 127 млн. евро - за 2004 год. |
| <<"Завтрашние уорхолы - сегодняшняя добыча дилеров", статья в NYTimes о беспрецедентных мерах, принимаемых лучшими арт школами по защите своих студентов от "орд голодных дилеров и коллекционеров". На выставках выпускников таких школ работы продаются по 2-10 тысяч долларов, но коллекционеры и галеристы скупают их, поскольку, если хоть один из добытых авторов становится звездой, затраты окупаются сторицей. С другой стороны растет стоимость обучения. Например, 2-х летняя программа MFA в Колумбийском университете стоит около 70 тысяч долларов. За эти деньги студенты получают студию и возможность работать рядом со звездами, выступающими в роли наставников, в том числе привлекающих критиков для группового обсуждения работ. Однако, декан арт колледжа Yale считает, что ранняя коммерческая ориентация мешает студентам расти и развиваться. С этого года арт колледж Columbia перестает привлекать студентов первого курса к публичным событиям. По мнению преподавателей опасно также соревнование между коллекционерами и дилерами: кто откопает более успешного студента. И те и другие вносят коммерческую доминанту в процесс обучения. |
<<11 апреля NYTimes
отметилась статьей о Берлинской
биеннале. S. Madoff из разговоров с
кураторами Maurizio Cattelan,
Massimiliano Gioni и Ali Subotnick
и из их Гогосьян-мистификации извлек ключ к
пониманию происходящего на Auguststrasse.
Мистификация заключается в том, что "активно
участвующая в биеннале новая галерея
Гагосьян" никакого отношения к
глобальному арт-бренду Gagosian Galleries не имеет.
Используя этот бренд (не спросясь у Ларри
Гагосьяна) в скромных, что называется,
повседневных пространствах Auguststrasse, они
сталкивают его с реальностью локального.
Создают напряжение между глобальным и
локальным. Таково место и роль нынешней биеннале в безмерно разросшемся биеннальном движении. Давно назрел вопрос, по-прежнему обсуждаемый на симпозиумах, конференциях и просто в профессиональных кругах на крупнейших фестивалях: от Венеции до Сан-Пауло, - что промотируют плодящиеся (их уже более 200) фестивали современного искусства? Международное понимание или локальные интересы? Есть и другие, не менее важные вопросы по поводу таких фестивалей. Что в каждом из них превалирует: трибуна для кураторской идеологии или обслуживание арт рынка? Добыча трендов или усиление роли артистических высказываний в социальном диалоге? В опросе, который провел обозреватель, есть такое мнение о результате кураторских усилий здесь, на Auguststrasse: "Они ясно медитируют на тему места как микрокосма глобального пространства взаимопонимания". Говорит это, между прочим, не европейский интеллектуал, а нью-йоркский арт дилер. Напомню мнение о берлинской биеннале Adrian Searl (Guardian): " Разговор с самими собой и друг с другом" <Ю П> 
 Wagon". Robert Kusmirowski "Weight, 2005," видеоинсталляция Michael Borremans.  <И мнение Михаила Молочникова из Берлина. |
| <<4-я Berlin Biennale 2006 с 23 марта по 28 мая. bb4. Кураторы Maurizio Cattelan, Massimiliano Gioni и Ali Subotnick выбрали необычные места для экспозиций, сконцентрированные на Auguststrasse и призванные способствовать проникновению искусства в пространства, где мы обычно работаем, едим, молимся и развлекаемся. Среди 70 художников, участников основного проекта, Виктор Алимпиев. В организации и проведении биеннале активно участвует галерея Gagosian и журнал Zitty> |

|

|
<<вышел апрельский ARTFORUM. О биеннале Whitney и художнике Christopher Williams. Критик и куратор Bennett Simpson рассматривает "тело" фоторабот художника по аналогии с морским животным, не имеющим желудка, рта и к скелета. Только в фотографии это: тема, стиль и техника> |
|
<<В #3 (12)
номере журнала "Арт-менеджер": * Я.Кузьминов НОВАЯ ЭКОНОМИКА – ЭКОНОМИКА ПЕРЕЖИВАНИЙ * ЗАЧЕМ НИИ КУЛЬТУРЕ, А КУЛЬТУРА НИИ? * СТИПЕНДИИ ФРАНЦУЗСКОГО ПРАВИТЕЛЬСТВА * ЕВРОПАЛИЯ 2005 – ГОД РОССИИ * Е.Бедуш КОНЦЕРТНЫЙ РЫНОК РОССИИ * УСЛОВИЯ МУЗЕЙНОГО КОНКУРСА * М. Шмидт ГАЛЕРЕЯ – ЭТО БИЗНЕС ПОКОЛЕНИЙ * ЮРИЙ МАРКОВИЧ: НАШЕМУ ИСКУССТВУ НУЖНЫ КВАЛИФИЦИРОВАННЫЕ МЕНЕДЖЕРЫ, КРИТИКИ И ЭКСПЕРТЫ * В. Урин ЭТОТ НОВЫЙ СТАРЫЙ ТЕАТР * Катя Эйнола, Норманд Тургеон МЕЖДУНАРОДНЫЙ МАРКЕТИНГ ТЕЛЕВИЗИОННЫХ ПРОГРАММ * Л. Кайзер ИТАЛИЯ: КУЛЬТУРНАЯ ПОЛИТИКА, КУЛЬТУРНЫЙ ТУРИЗМ, СОВРЕМЕННОЕ ИСКУССТВО И МЕЖДИСЦИПЛИНАРНЫЕ ПРОЕКТЫ АЗБУКА ФАНДРАЙЗИНГА * К. Твиди БЫТЬ ИЛИ НЕ БЫТЬ ARTS & BUSINESS В РОССИИ? * СТРАХОВАЯ КОМПАНИЯ AIG LIFE * ПРОЕКТЫ HENNESSY: МОСКОВСКИЙ ДОМ ФОТОГРАФИИ * МЕЖДУНАРОДНЫЙ БЛАГОТВОРИТЕЛЬНЫЙ ФОНД «ДЕТИ МИРА» * Ч.Лэндри ОСНОВНОЙ РЕСУРС ГОРОДА – ЛЮДИ * Х.Тудела КУЛЬТУРНЫХ СТОЛИЦ МНОГО НЕ БЫВАЕТ * К.Соколова КУЛЬТУРНЫЕ СТОЛИЦЫ МИРА В МОСКВЕ * А.Прохоров КОММУНАЛКА – ЭТО НАШЕ ВСЕ! * С. Ханна, В. Дель Касино КАРТИРОВАНИЕ ТУРИЗМА * ЗАЧЕМ АТТАШЕ И СОВЕТНИК ПО КУЛЬТУРЕ В ПОСОЛЬСТВЕ? * А. Благая ТВОРЧЕСКИЙ СОЮЗ ИЛИ ПРОФСОЮЗ? * РУКОВОДИТЕЛИ ОРГАНОВ КУЛЬТУРЫ СУБЪЕКТОВ РФ> |

|
<<Высказывание Богдана Мамонова
по поводу более, чем двухлетней дискуссии
Дмитрия Гутова и
Анатолия Осмоловского вокруг абстрактного искусства и, если рассматривать проблему шире, вокруг формы
- Осмоловский VS Институт Лифшица. "Первое, что бросается в глаза человеку, знакомому с ситуацией изнутри, это то, что полемика на самом деле ведется не вокруг, собственно, художественной теории. Цель спора явно другая и в нем довольно ясны скрытые интересы участников. Я полагаю, что все российское актуальное искусство после 90-х находится, говоря футбольным языком, в полупозиции. Конечно, это относится не ко всем. К Кулику например не относится, и к В@Д тоже. Они, что бы мы о них не думали, четко поставили себе цель и ее добились. Другой вопрос, что это за цель, но нам это, в данном случае, и неинтересно. Но среди персонажей московской сцены никто, может быть, не находится в таком сложном положении, как два героя 90-х, два застрельщика сегодняшнего спора "о красоте" - Гутов и Осмоловский. Проблема этих замечательных художников - я имею в виду вас, друзья, в том, что за 12 лет они так и не выработали, на мой взгляд, ясного художественного жеста, их искусство не обрело отчетливой формы, которая стала так востребована в новом десятилетии. Зато, или увы, они обрели очень отчетливый, я бы сказал, монолитный имидж революционеров от искусства, который не может не влиять на их сегодняшнюю позицию. Я имею в виду имидж, а не революционность, которая, возможно, им и впрямь присуща" Полностью> |

|
<<Gagosian открывает новую галерею в Chelsea. Это будет пятая галерея лидера галерейного бизнеса. Вторая в Челси и третья в мекке современного искусства Нью-Йорке. Bloomberg> |
|
<<Как всегда легкий и
ироничный, с рассеянной растерянностью,
едва прикрытой фирменным алексеевским
лукавством, текст, инспирированный выставкой
Зураба Церетели в Манеже, - "Монада
Церетели". РЖ,
Никита Алексеев. "...нередко сравнивают его с Энди Уорхолом, доходя иногда до утверждения, что Церетели у нас ныне то же самое, чем был Уорхол на западе в 70-80-е годы ушедшего века. <...> "Цены на работы Уорхола выше на рынке? Чушь, потому что Церетели давно перерос рынок, вернее, видимо, сразу понял, что международный art market - это дело, не стоящее внимания. Плоды своих усилий он либо дарит, и пойди откажись, либо за них платят налогоплательщики, и Уорхол, не исключаю, кусал бы себе локти, увидь он, как здорово это у Церетели получается. <...> что касается продуктивности, сомневаюсь, что Уорхолу удалось бы набить под завязку такое огромное пространство, как Манеж, причем не тиражными, а в основном штучными вещами, да не за все время творческой деятельности, а в основном за последние десять лет. Если же учесть, что выставка Церетели начинается на подступах к Манежу, от Манежной площади, стационарно заставленной его свершениями (а у входа в Манеж временно водружены очередной Петр и очередной Александр II), то, надеюсь, становится несомненным: Церетели главнее Уорхола. " |

|
<<247 номер Flash Art вышел 1 марта. Главный материал - о приближающейся 4-й Berlin Biennale 2006 (с 23 марта по 28 мая). Dorothy Iannone беседует с одним из кураторов биеннале, художником Maurizio Cattelan'ом. Еще с одним героем номера, художником Anri Sala беседует миланский теоретик Stefano Boeri. Лауреат Illy Prtize 2005 (10 тысяч евро) бельгийский художник Louis De Corbusier (1978)> |

|
<<Одна эра завершена. Кодак
прекращает выпускать фотобумагу для черно-белой
печати. Вместе с тем, это открывает новую
эру - весьма скоро черно-белые отпечатки
станут практически исключительно
прерогативой искусства. Хотя и здесь
большинство недавних ценовых рекордов
установлено при продажах цветных
отпечатков, как правило, гигантских
форматов. Подробнее,
с изобилием примеров, в ArtNews> <Richard Prince, Untitled (Cowboy), 1989 продана на ноябрьском аукционе современного искусства Кристи за 1.2 млн. долларов> |
| <<Bloomberg (6/03) - об учреждении Гильдии арт экспертов в России. Москва стала средоточием богачей. Только миллиардеров в Москве около 50, и многие из них, следуя западной традиции, начали коллекционировать искусство. Общий годовой объем продаж оценивается в 1.5 миллиарда долларов. Однако вместе с его ростом растет и число изощренных подделок и подлогов. Блумберг цитирует Евгения Зяблова, назвавшего ситуацию критической. Директор Art Consulting Денис Лукашин считает, что около 70 процентов произведений приобретенных в коллекции за последние 2 года могут быть подделками. В таких условиях Гильдия планирует взять на себя лицензирование арт экспертов и легальную помощь коллекционерам> |
| <<Рейтинг музейных выставок по посещаемости опубликовала The Artnewspaper. Только pdf-файлом. Даем вырезку из него. Тройка лидеров японская. 1-я колонка - в день, 2-я - общее число посетителей. По этому показателю "Тутанхамон" в Лос-Анжелесе впереди> |
|
<<Cо 2 марта по 28 мая в нью-йоркском
музее Whitney
очередная
Whitney Biennial. Более 100
художников отобранных кураторами Chrissie Iles (Whitney)
и Philippe Vergne (Walker
Art Center, Minneapolis) составили основную
экспозицию. <Каталог> |
| Кроме неё биеннале включает еще несколько выставочных проектов, в которых участвует более 250 художников. 180 художников приняли участие в создании монументальной Peace Tower, прямо перед входом в музей. Финансовая поддержка- Detsche Bank (?). |

|
<<Обозреватель NYTimes Майкл
Киммельман считает, что открытие было
прогнозируемо провокативно для
неподготовленного зрителя. Который ждет от
подобных фестивалей не юношеской
безбашенности и не коммерческой
одержимости. Но всякий раз сталкивается с
инсайдерской герметичностью. Киммельман
хотел бы, чтобы кураторы, наряду с
интеллектуальной целью, не забывали,
например, про блаженство, которое хотелось
бы испытать на таких грандиозных
фестивалях. Первой по этому критерию он
отмечает эффектно инсталлированную
цифровую анимацию Paul Chan (на фото). Подробнее> <<Биеннале олицетворяет кризис идентичности, переживаемый Whitney. Эта ситуация серьезна и, вместе стем смешна - хмыкает М. Стивенс (NY Magazine)> <<Пинает биеннале и Кристофер Найт (Times) - "Кому она нужна? Тусклая и малозначительная"> |

|
<<Джерри
Зальц назвал нынешнюю
биеннале "живейшей и умнейшей" из
всех
Whitney Biennial, которые он
когда-либо видел. Такая похвала Зальца это
нечто экстраординарное. Очень хвалит
кураторов Chrissie Iles и Philippe Vergne за искусство
адекватное времени, когда модернизм уже
стал историей, а постмодернистская
риторика отыграна> <Кураторы Whitney Biennial Chrissie Iles (Whitney) и Philippe Vergne (Walker Art Center> |

|
<Кураторы Биеннале Chrissie Iles и Philippe Vergn выглядят одинокими и очень печальными> |
| <<"Если это место платное, кто его займет? От модернистской к постмодернистской форме критики. Критика - искусство или реклама" - текст Menachem Feuer на CTHEORY. |

|
<<Вышел мартовский ARTFORUM.
Редакция обратилась к 6 ведущим
архитектурным бюро: MVRDV, Huff + Gooden, UN Studio, Morphosis,
West 8 и Hargreaves Associates - с просьбой поделиться
своими представлениями о возрождении
Нового Орлеана после ужасающих разрушений,
вызванных ураганом Катерина. Peace Tower на Whitney Biennial 2006. Изначально башня была задумана и сделана Petlin и di Suvero в 1966 году в знак протеста против вовлечения США во Вьетнамскую войну. Теперь же она центральный объект очередной национальной биеннале, которая всегда демонстрировала мейнстрим современного искусства Штатов>
|

|
<<Зимняя Олимпиада в Турине, в связи с открывшейся в эти же дни выставкой мастеров Возрождения, дала новый импульс дискуссиям, основанным на сомнении, что известный автопортрет Да Винчи действительно автопортрет. По мнению части экспертов не сходятся годы: вероятного рисования сангиной весьма пожилого, почти библейского персонажа и возраст самого Леонардо в это же время...> |

|
<<Жюри
австралийской премии Metro 5 Art Award отдало
приз в 40 тысяч долларов служащему
налоговой инспекции. Мытарю Самуэлю
Личу. За живописную работу Dividendgame. В
интервью лауреат сообщил свое кредо -
совместить традицию голландских
мастеров 17 века и современный контекст. "Застреленная на охоте куропатка это игра," - говорит Лич, - "Когда мы попадаем в корпоративное окружение, мы тоже попадаем в игру". Вот такими вопросами озадачен победитель. Галерея Metro 5, учредившая премию, считается в Австралии галереей "манхеттенского" типа> |
| <<Фотография Эдварда Стайхена "Озеро в лунном свете" ("Pond-Moonlight", 1904) была куплена неизвестным коллекционером на аукционе Sothbey's за рекордную цену 2,928,000 долларов> |
| <<Знаменитая, много обсуждаемая в последнее время статья американского веб-аналитика Тима О'Рэйлли “Веб 2.0” рассматривает новейшие примеры коллективной самоорганизации через интернет – такие, как флэшмоб, блоги, Wikipedia, программирование с открытыми кодами – и на их основании утверждает, что во все большей степени и сам интернет напоминает коллективный разум – то есть, некую новую форму жизни, которой прежде никогда не существовало. О'Рэйлли определяет “элементарную частицу” интернета формулой “Каждый пользователь – это сервер”. Подробнее - ИТ-ГЛОССАРИЙ: КОЛЛЕКТИВНЫЙ РАЗУМ> |
| <<«Тема воображаемой жизни после капитализма вновь удостоилась академического внимания... Следом за первопроходцами типа Фредерика Джеймисона утопическое исследование предпринял Alexander R. Galloway - текст в CTHEORY "Warcraft and Utopia"> |

|
<<Только изощренные
компьютерные технологии анализа
позволяют определить, что половина из
полотен обнаруженных в 2003 году у
потомков друзей Поллока скорее всего
выполнены не им. Не смотря на кажущуюся
хаотичность капельной живописи Поллока,
она демонстрирует удивительно
последовательные фрактальные паттерны:
как в растекании краски, так и в движении
художника по земле вокруг холста. NY Times, со ссылкой на статью доктора Тейлора в журнале Nature, сообщает что, по мнению исследователя, 6 из 24 найденных полотен существенно отличаются от работ Поллока. По обнаруженному им фрактальному критерию. Остается одна "степень свободы", о которой говорит сам ученый - "или это экстремальные отличия, возможные в технике одного художника, или же это разные авторы"> |
|
<<«...наши, разгоняемые
полицией, беспорядки, - это всего лишь
отражение того беспорядка, на котором
держится ваша система организованного
воровства и соблазна». В среде <ситуационистов
60-х> отрабатывалась терминология,
пафос, образный ряд и манера
контркультуры. Они были творческой
лабораторией политических и художественных интеллектуалов. "Новое наступает там, где заканчивается Обмен и начинается Дар." На www.getto.ru появилась рецензия Алексея Цветкова на культовую книгу 60-х РАУЛЬ ВАНЕЙГЕМ: РЕВОЛЮЦИЯ ПОВСЕДНЕВНОЙ ЖИЗНИ. ТРАКТАТ ОБ УМЕНИИ ЖИТЬ ДЛЯ МОЛОДЫХ ПОКОЛЕНИЙ. М., Гилея, 20О5> |

|
<<Муляж Саддама Хусейна со связанными за спиной руками, в аквариуме, один к одному с херстовским - для распиленной акулы, объект чешского художника Дэвида Черны, планировавшийся к показу на фестивале Beaufort 2006, стартующему в бельгийском Middelkerke 1 апреля, исключен из программы. Мэр города воспротивился "спорной, потенциально взрывной вещи". Вместо Beaufort 2006 работа Черны в апреле будет экспонироваться в Музее современного искусства города Oostende. Об этом официально заявил представитель музея> |
| << Правозащитники готовы поссорить Россию с Исламским миром. Директор Сахаровского музея Юрий Самодуров заявил, что музей уже в марте готов организовать выставку карикатурных изображений пророка Магомета опубликованных датской газетой. Дабы показать миру, что Россия с Европой, что свобода важней догм религиозных фанатиков. На открытие планируется пригласить французского философа Глюксмана, который бы прочиталд лекцию об исламском фундаментализме> |
| << В Индии формируется новый способ отмывки грязных денег (black money) - покупка произведений искусства> |
|
<< Thomas
Blackman Associates (TBA),
организующая несколько ярмарок
современного искусства в США, крупнейшая
из которых Art
Chicago состоится 28.04-1.05, не справляется с
собственными амбициозными планами. Только
что была отменена ярмарка
в Сан-Франциско,
планировавшаяся на 13-16 января 2006 года,
Теперь настал черед Art
New York at Pier 94 (94-й пирс у
West SideHighway, набережной Hudson River), в которой 24 - 27
февраля планировали принять участие 150
галерей со всего мира. Почти по нашенски организаторы
заявляют, что им не хватило времени. По
сути же, причина иная. Боязнь провала в
конкуренции с двумя нью-йоркскими
ярмарками: Art
Dealers Association of America, которая откроется 23
февраля (до 27.02, 70 американских галерей), и
стабильно успешной Armory
Show, с 9 по 13 марта. Cтоит упомянуть, что уже 6 лет каждая вечеринка открытия Armory Show (Opening Night Preview Party), на которые собираются более 3000 состоятельных коллекционеров, приносят в Выставочный фонд и без того не бедного МоМА более 600 тысяч долларов. Спонсорский билет стоит 1000$, билет патрона - 500$, билет друга - 250$. Каждая категория гостей имеет свои привилегии и является на открытие к своему времени: спосоры - к 17:00, патроны - к 17:30, друзья - к 19:00> |

|
<<Знаменитый: сначала в узких кругах - головой слепленной из собственной (?) замороженной крови, а затем в более широких - скульптурой безрукой и безногой беременной художницы Alison Lapper на лондонской площади Трафальгар, Марк Куин замахнулся на один из главных архетипов истории искусства, Афродиту. Выбрав в качестве модели Кэйт Мосс. Художник утверждает, что, поскольку изображения Мосс уже повсюду, она уже стала сегодняшней версией Афродиты. Ему остается только довершить дело, зафиксировать архетип, уже сложившийся в коллективном бессознательном. Подробнее> |
|
<<"Гипервирус:
клиническая картина" - текст Тьерри Бардини
на CTHEORY. Всякий знает, что идет Чума, Всякий знает, что здесь уже она. Всякий знает, что голая парочка Всего лишь артефакт вчерашнего дня. Леонард Коэн, "Everybody Knows". "С наступлением четвертой фазы капитализма проснулся гипервирус. Ядовитый паразит, бессмертный, вездесущий и всемогущий" - так начинается этот текст Bardini. После эпиграфов из Коэна и Бодрийяра. На сайте коллег Бардини, радикальных эмпириков, есть еще любопытные тексты. Например "Алкоголизм как проект рационализации"> |
| <<"...я написала о супрематистах: "Лебединая стая опустилась на русскую землю". Да. Я даже говорю там, что они все сами - как птицы, были прекрасны. Это была какая-то чистая струя в искусстве, - прозрачная, светящаяся. И все же ее скрывают. Вот в Третьяковке была выставка "Кубизм", где были все эти художники, в том числе и Ванечка Кудряшов, который уже чистой воды делал супрематические вещи. Их выставляют, как кубизм! подумайте сами, как это? Почему России нельзя быть первой?" - интервью с Лидией Мастерковой, РЖ - "Видите, сейчас нужна какая-то бодяга. Что до Кабакова - такое искусство я просто не признаю. И вообще, это не искусство. Это голый король"> |

|
<<Сегодня 1 февраля в 14.50, по
истечении пятого часа заседания, судья
Пашкевич вынесла решение ОТКАЗАТЬ членам
Московского союза художников в
удовлетворении искового требования о
взыскании с Галереи Марата Гельмана и
Центрального дома художника компенсации
морального вреда в сумме 5 000 000 рублей, а
также отказать в требовании запретить
распространение и публикацию произведений
с выставки "Россия 2". Таким образом,
все обвинения в разжигании межрелигиозной
розни и оскорблении православных верующих
с Галереи Гельмана и |
| <<21 акварель Адольфа Гитлера выcтавлена на провинциальный аукцион Jefferys в Lostwithiel, Англия. Средний эстимейт около 4 тысяч фунтов стерлингов. Вся коллекция оценивается примерно в 100 тысяч фунтов. News24.com> |
| <<"Хокни? Это такая чепуха" - именно так Фрэнсис Бэкон (1909-1992) отзывался о живописи Дэвида Хокни (1937). Подробнее> |
| <<Washington Post на примере автомобильного дилера Валерия Южина, потратившего 5 млн. долларов на фальшаки вместо русских пейзажей, обстоятельно рассказывает о проблемах, с которыми столкнулись новые русские коллекционеры старой русской живописи. Вместо неё им подсовывают скандинавских пейзажистов. Сей скандал высветил два любопытных обстоятельства. Первое заключается в том, что никакой особенной национальной оригинальности ни русские пейзажисты, ни - совсем крамола! - русские пейзажи, не имеют. Второе обстоятельство вовсе обескураживает. Наши эксперты, а это в основном музейные работники, похоже, не подозревали о столь радикальном сходстве пейзажной живописи скандинавских и русских художников. Если же подозревали, то тогда еще хуже. Это означает, что они сознательно помогают морочить олухов. Далее. В скандинавских странах в течение ХХ века избегали катаклизмов. Напротив, последовательно воплощали в жизнь социалистические идеи. И не мало в этом преуспели: приучили народонаселение к жесткой прогрессивной налоговой системе, отучили состоятельных людей бахвалиться накопленным, более того - породили моду выглядеть не броско. В таком контексте рыночная стоимость скандинавской пейзажной живописи ХIХ века, не интересной, к примеру, американским коллекционерам, по сей день остается весьма скромной, а в последние годы оказалась в разы меньшей, чем стоимость работ средней руки русских пейзажистов. База для подлогов готова. Далее не интересно. Ю П> |
| <<Издательство Revolver (Франкфурт), с 1999 года зарекомендовавшее себя как основного публикатора в области молодого современного искусства, сменило владельца и издателя. Christoph Keller на Ann Theobald> |
| <<Неприятные перипетии с московским Музеем кино становятся еще огорчительней, когда узнаешь о планах Американской Академии кино выделить 200 млн. долларов для Музея кино. Своего конечно, не нашего же> |
|
<<Первой обладательницей премии
MaxMara стала 30-летняя американка Margaret
Salmon, живущая и
работающая в Лондоне. Частью премии
является 6 месячная резиденция в Италии, где
Маргарет будет работать над новым проектом.
Она говорит, что "очень благодарна за
возможность поработать в Италии, на родине
неореализма", оказавшего существенное
влияние на ее творчество. Премией для
женщин распорядилось женское жюри:
обладательница Turner Prize Gillian Wearing,
галеристка Victoria Miro, редактор Freez Jennifer Higgie и
директор лондонской Whitechapel Gallery Iwona Blazwick. В шорт лист входили: фотограф Anne Hardy, акварелист Donna Huddleston, скульптор Rachel Kneebone и живописец Anj Smith. Подробнее - Guardian |
| <<В церкви небольшого французского городка Loches, где-то под органом обнаружены две картины Караваджо! |

|
<<Как ни странно, несмотря
на весь тот вал книг о современной живописи,
вышедший в последние годы, классические
работы вроде «Современного европейского
искусства» Алана Боунеса, «Истории
современного искусства» Х. Х. Арнасона и т.
п. до сих пор остаются у нас
непереведенными. Gazeta.ru - об издании на русском языке «Краткой истории современной живописи» Герберта Рида - "...полнота обзора искусства первой половины XX века почти предельная." К упомянутым Нестеровым нельзя не добавить странным образом отсутствующую в русском переводе принципиально важную книгу Дональда Прециози (1941) "Rethinking Art History. Meditations on a Coy Science"/ Издание Йельского университета 1989 года. У меня по этому поводу есть не вполне приличные подозрения. Возникшие от того, что многое из высказанного Прециози так или иначе присутствует в практиках наших теоретиков искусства. И, в свою очередь, некоторые впечатляющие "пробеги мысли" Прециози удивительно совпадают, например, с Фуко, ссылки на которого, однако, американский профессор не дает... И все-таки только подозрения, не более того. Есть же у Прециози совпадения, например, с нашими героями "течения" 30-х годов, которых он почти наверняка не читал. А вот доктор Виктор Арсланов читал и то и это, в чем можно убедиться, полистав его книгу - не помню точно название - об искусствознании ХХ века. 26 января Арсланов примет участие в дебютной дискуссии фонда "Эра"(в Трубниковском переулке, 13. стр.1, левый подъезд; 19 часов). Формалисты против антиформалистов, "стенка на стенку", имитирующие актуальность темы Formalism Forever?> |
| <<Наум Клейман: "Китайцы сейчас отгрохали гигантское четырехэтажное здание Музея кино. Парижская синематека получила огромное здание бывшего американского культурного центра". Наш Московский Музей кино по-прежнему в затягивающейся фазе бездомности. Общество Друзей Музея кино обратилось к представителям власти, культуры и бизнеса с открытым письмом. В ответе из Минкультуры РФ описывается текущая ситуация вокруг Музея кино. В нем сообщается и о предоставлении Роскультурой Музею кино зала на 350 мест в Гнездниковском переулке, и о предварительных договоренностях с руководством научно-исследовательского кинофотоинститута (НИКФИ) по поводу кинозала на 400 мест и помещения для хранения фильмотеки, и о совместных проектах Музея с Государственным центром современного искусства (ГЦСИ) и Московским Музеем Современного Искусства. Однако в итоге авторы письма сами признают, что "все перечисленные меры носят вынужденный, временный характер"> |

|
<<Колумбийская художница Doris
Salcedo (1958 г. р.,
участница 2003
Istanbul Biennial, T1 Triennale в
Турине, 11
Документы) и куратор Ralph Rugoff,
директор California College of the
Arts (CCA) Wattis Institute for
Contemporary Arts, San Francisco, стали
обладателями одной из самых весомых в
денежном отношении премий, Ordway
Prize, учрежденной Penny
McCall Foundation (PMF). Лауреаты получат по 100 000$> <Инсталляция Salcedo на 2003 Istanbul Biennial> |
| <<Место проведения ежегодных художественных ярмарок (в 2006 году Armory Show состоится 10-13 марта), The Seventh Regiment Armory на манхеттенской Park Avenue вскором времени превратится в центр визульного и перформативного искусства. На реконструкцию собрано 50 млн. долларов. Поставлена задача - сохранить одно из исторически значимых сооружений и создать современное арт пространство. Подробнее в Artnewspaper> |
| <<Книга Альмы Бонд "Camille Claudel, a Novel" снова поднимает вопрос о взаимоотношениях Огюста Родена и Камиллы Клодель. Присваивал ли результаты ее труда один из самых известных скульпторов или все-таки утверждения Камиллы можно отнести к паранойи человека, которому путь в большое искусство был заказан. В то время у женщины не было шансов стать большим художником. В течение 30 лет лепить руки и ноги для Родена, даже участвовать в определении поз, жестов? Или же ее вклад в роденовские достижения более весом?> |

|
<<246-й
номер журнала Flash Art.
Главная тема - Лос Анжелес: художники, обзор
"Город Ангелов", "L.A. Street Style".
Кроме того представлены: Eve Sussman, Damián Ortega,
Katarzyna Kozyra. Триеннале в Гуанжоу и Йокогаме,
Арт Базель Майями, "Нью-Йоркские сказки"> |

|

|
<<GIF.ru
подвел итоги 2005 года. Проект - Московская
биеннале (бесспорный лидер, с большим
отрывом). Галереи - XL и Риджина. Художник -
"Синие носы". Куратор - Андрей Ерофеев.
Издание - Коммерсант, Артхроника и GIF (по 2
голоса). Такое ощущение, что участники
опроса никаких изданий не читают;
оценивают по наслышке (разумеется, в
тусовке, не на улице). Единственный еженедельный
обзор московского арт процесса от начала
и до конца 2005 года оказался вне зоны их
внимания, зато "проснувшийся" в
сентябре GIF на месте. Вызывает удивление и
отсутствие упоминаний газеты "Время
новостей", наиболее регулярно и внятно
из сми "общего профиля" освещавшей
художественные события, при том что
критиками (журналистами) года названы
Фаина Балаховская и Сергей Хачатуров.
Вопрос "издание года" конечно не
корректен. Следовало бы уточнить: "периодическое
издание". Тогда в результатах не было бы
"самовыдвижения" Е.Деготь книги "Московский
концептуализм". Дебют года - МЦИ на
Неглинке. <Сергей Хачатуров. Помимо "Времени новостей" обозреватель "Радио культура". Попутно нельзя не отметить, что кроме галереи RuArt "Радио культура" можно так же отнести к разочарованиям года. Невнятно и вяло. Сергея это не касается. Ю П> |
| <<Новый рекорд посещаемости Лувра, 7.3 млн. установлен в 2005 году. По поводу причин - редкое единодушие - пресловутый "Код да Винчи". Выйдет в прокат фильм, будет установлен новый рекорд> |
| <<Впечатляет обнародованный FBI ежегодный объем рынка ворованных произведений искусства, порядка 5 млрд. долларов> |

|
<<Шестилетний Эдвард Симпсон не только стал участником национальной юбилейной 100-й выставки акварелистов, но порадовал 75-летнего дедушку, профессионального художника, который вероятно и приобщил внука к рисованию. Все кошки, собаки, овцы и "дедушки" юного художника были проданы, в среднем по 75 фунтов> |

|
<<Япония.
Итоги 2005 года - "Причины улыбаться после
бедственного периода". Главное
событие конца года - прошедшая с 28 сентября
по 18 декабря триеннале
в Йокогаме. <Гигантская игра Chisino Kurumada и Takahashi> |

|
<<10
московских событий уходящего 2005 года.
Версия В.Дьяконова, РЖ: 1. Московская биеннале современного искусства (28 января - 28 февраля) 2. "Русский поп-арт" (Третьяковская галерея на Крымском Валу, 14 сентября - 13 ноября) 3. Тони Крэгг. "Тяжесть и нежность" (ЦДХ, 22 июня - 17 июля) 4. Кристиан Болтански. "Призраки Одессы" (Музей архитектуры им. Щусева, 28 января - 28 февраля) |

|
5. "Россия!"
(Музей Соломона Р. Гуггенхайма, Нью-Йорк, 16
сентября - 11 января 2006) 6. Константин Батынков. "Бегущие по волнам" (Крокин-галерея, 27 октября - 27 ноября) 7. Джонатан Меезе. "Дракула" (галерея "Риджина", Москва, 26 сентября - 12 ноября) 8. "Doublethink" (Stella Art Gallery, 7 апреля - 15 мая) 9. "ArtПоле" (Рублево-Успенское шоссе, куратор - Айдан Салахова, 10 сентября - 10 октября) 10. "Россия - Италия. Сквозь века. От Джотто до Малевича" (ГМИИ им. Пушкина, 8 февраля - 20 мая) |
| <<О Мехико-сити как об одной из столиц искусства - Los Ageles Times> |

|
<<15 июля 1606 в Лейдене родился
десятый ребенок в семье Harmenszoon,
Rembrandt. В
Нидерландах предполагают,
что в течение 2006 года 20 выставок,
посвященных 400-летию van Rijn'а
посетит от четверти до полумиллиона
голландцев. Это при том, что всего их 15
миллионов (практически Нидерланды равны
Москве с областью - примерно одинаковые
площадь и численность населения)>
<Автопортрет 1629 года> |
| <<Знаменитый обозреватель Village Voice Джерри Зальц о себе и об искусстве. "Искусство - способ мышления, способ познания самого себя". Почти в 40 лет Джерри водил грузовик, правда был при этом очень сильно "себе на уме": книжонки всякие почитывал, в тетрадочки всякую всячину пописывал, по музеям хаживал... Вообще создается впечатление, что лучшие люди в Штатах либо моют посуду, либо водят грузовики, либо - неважно что - зарабатывают на жизнь минимальным касанием конкурентной среды, причем настолько минимальным, чтобы даже при касании голова оставалась свободной, и никакой мудак менеджер не сбивал с мысли. ЮП> |
|
<<Андрей Ковалев, "наблюдатель
за наблюдателями", излагает результаты
своих измерений в
художественной экономике и в общественном
подсознательном. Поводы: ярмарка Арт-Манеж
и "Полвека советского искусства. 1930-1980
гг." в ЦДХ. "Смутные пейзажи на стенах зажиточных горожан, столовский суп харчо, подаваемый в дорогом заведении тетенькой в кружевной наколке, регенерируют СССР более эффективно, чем все коммунистические митинги". Подробнее> |

|
<<The Artnewspaper об открытии "крупнейшей в России частной галереи", Якут-галереи в пространстве бывшего газгольдера на заводской территории примыкающей к Курскому вокзалу (14 октября 2005 года). Ремонт помещения потребовал 300 тысяч долларов и не мог обойтись без помощи Натальи Ивановой, жены московского бизнесмена, в отличие от мужа, предпочитающего живопись XIX века, коллекционирующей современное искусство> |

|
<<Венская башня Arenbergpark Flak Tower, построенная нацистами для военных целей, неспешно, по словам директора венского MAK-центра Peter Noever - лет за 10-15, превратится в Центр современного искусства нового типа. Новизна подхода и определяет неспешность проекта. Будут приглашаться художники, по одному, для реализации масштабных проектов непосредственно на месте, в пространстве башни. Так шаг за шагом будет создаваться коллекция искусства ХХI века. |
| <<"Золотой век" коллекционирования искусства. По данным агентства ArtPrice за прошедший год цены на произведения современного искусства (contemporary art) выросли на 40 процентов. По окончании Art-Basel Miami Beach, ставшей за 3 года одной из главных ярмарок, корреспондент Toronto Star пытается проанализировать ситуацию> |

|
<<В декабрьском
ArtForum'е 11 известных
критиков и кураторов называют 10 событий
года> <Paul McCarthy, "Flowers", 2005. Инсталляция в Haus der Kunst, Munich> |

|
<<Solomon
R. Guggenheim Foundation
анонсировал шорт-лист Hugo
Boss Prize. Премия в
размере 50 тысяч долларов присуждается раз
в два года художнику, чьи работы
представляют собой существенное развитие
современного искусства. 1. Jennifer Allora, 31, Guillermo Calzadilla, 33 - соавторы концептуалисты из Пуэрто Рико. Социальное, политическое искусство. Участники 1-й Московской биеннале. Помните мопед с трубой на выхопе - было такое видео на станции метро "Воробьевы горы"> |
|
2. John
Bock, 39, немецкий перформансист и скульптор.
Участник 1-й Московской
биеннале 3. Tacita Dean, 46, британская художница, известная своими 16-миллиметровыи фильмами, передающими очарование заброшенных и забытых пространств. 4. Damián Ortega, 38, живущий в Мексико-сити и Берлине. Работающий со скульптурой и фотографией с использованием в качестве основного материала предметы повседневной жизни. 5. Aïda Ruilova, 31, нью-йоркская художница, известная своими своими мрачными, мистериальными видео работами. 6. Tino Sehgal, 29, британский перформансист и хореограф, живущий в Берлине. Участник 1-й Московской биеннале> |

|
<<Чувства тревоги и ужаса, а
также иные оттенки дурных предчувствий
характерны для подавляющего большинства
работ, собранных кураторами для Whitney
биеннале 2006. И это при том, что Whitney
биеннале считается политкорректным
официозом в американском искусстве. "Черными
настроениями" преобладающими в
современной культуре объясняют
кураторы столь мрачный месседж
предстоящей биеннале> <<Биеннале откроется 2 марта 2006 года. Главный спонсор - корпорация Altria Group, в стратегические интересы которой входит поддержка инноваций и творчества. Есть сходимость: такого рода компании безусловно ориентированы на демократов. Как известно, республиканцы всегда, а администрация Буша в частности, опираются на ВПК и добывающие отрасли. Так что современное искусство по-прежнему в политике. Altria Group - это, например, Филип Моррис. Отсюда неудержимая тяга кураторов выйти за рамки американского искусства. Впервые они широко привлекают художников из арт столиц: Милана, Лондона, Парижа и Берлина. "Whitney биеннале становится глобальной" - NYTimes. Ю П> |
|
<<"Top
10" краж произведений искусства
обнародовало ФБР: 1. 7 - 10 тысяч артефактов украденных в Ираке в 2003 году, "под шум" американского вторжения. 2. 12 картин из Музея Isabella Stewart Gardner, Бостон, 1990. 3. "2 ренуара" и "1 рембрандт" из Шведского национального музея, 2000 (найдены). 4. "Крик" и "Мадонна" Мунка из Munch Museum в Осло, 2004. 5. Картина Бенвенуто Челлини из Vienna's Kunsthistorisches Museum в 2003 году. 6. "2 караваджо" - Палермо. 1969 год. 7. "2 вангога" из Музея Ван Гога в Амстердаме. 2002. 8. "сезан" - Оксфорд, 1999. 9. "давинчи" - Scotland's Drumlanrig Castle, 2003. |

|
<<"Череп Буратино" - Gazeta.ru. Две выставки в Третьяковке предлагают искушенный концептуализм Макаревича–Елагиной и упражнения русского Уорхола. |
|
Концептуализму самое место в музее. Это
давнее подозрение вновь подтверждается на
выставке дуэта Игорь Макаревич – Елена
Елагина в Третьяковской галерее. Парадокс,
но именно концептуальные опусы с их вроде
бы отвержением надоевших ценностей весьма
выигрывают от музеефикации. В условиях
текущей практики, на скороспелых сборных
выставках, где всё фрагментарно и
несуразно, они обычно не производят
впечатления. То ли дело развернутая
ретроспектива под музейной крышей –
неспешно бродишь по залам, осматриваешь
через лорнетку наиболее примечательные
экспонаты, подолгу читаешь экспликации,
обмениваешься мнением со спутником или
спутницей. Концептуализм требует
зрительского соучастия, вдумчивого
проникновения в свою мифологию – почти в
той же мере, что и погребальная культура
этрусков или традиции каллиграфии. «Контакты с беспредметностью» Игоря Березовского. Ощущается изначальная дизайнерская подоплека этого занятия. Мило, искусно, но не без пресности. У того же Уорхола многое построено на намеренном вызове, на эпатаже, – а здесь добродушный извод. Вероятно, сама поп-артовская эстетика требует фиги в кармане или даже пощечины общественному вкусу, без чего ее каноны дрябнут и мертвеют. Но это лишь домысел, разумеется. |
| <<"Выставка <И. Макаревича и Е. Елагиной в ГТГ> не случайно называется "В пределах Прекрасного": искусство осталось единственной областью реального в мире, давно уже завоеванном симулякрами" - Андрей Ковалев - TimeOut> |
<Совсем
недавно, в последнем
выпуске АРТФона
Оксаны Саркисян
Константин Бохоров посетовал: "то,
что сейчас производится некоторыми
фигурами, трудно причислять к
современному искусству. Поскольку
современное искусство – это борьба
идей, концепций со стоящими за ними
манифестами. Если ты заметишь, вообще
нет ни одного художника, который хочет
себя позиционировать в борьбе идей.
Единственное, что они предъявляют, что
мы, мол, работаем с новыми медиа»". А как же Гор Чахал? Его нынешние попытки визуальной интерпретации "Архитектуры умопостигаемого мира" - пусть не совсем прямое, но следствие развития мировозрения. Причем эти изменения коррелируют со все более решительным проявлением искренности, столь не популярной в постмодернистских дискурсах. Касаясь проблематики, в которой ломают копья адепты евхаристического и рационального взгляда на мироздание, а по поводу искусства - представители соответствующих семиологий, Гор ухитряется оставаться на территории искусства, в его актуальном языке. Вместе с тем, искренне апеллируя к религиозным практикам. Ковалев Андрей обнаружил в последних работах Гора "... сплав беспредельного мракобесия и нечеловеческой святости", <который> "сияет свежим золотом и вообще выглядит очень привлекательно". Вот ведь - мракобесия, но выглядящего привлекательно. Отчего же привлекательно-то? Может от того, что художник играет, лукавит? Одни, мол, "играют в Лифшица", у которого, кстати сказать, многие вменяемые люди тоже находят нечто от мракобесия. Другие - в абстракционизм вместо революции. Третьи - в перманентную революцию, в анархию. А Гор, по логике Андрея Ковалева, - в дуализм святости и мракобесия? Именно по причине категорического несогласия с такой логикой и с таким выводом я и взялся написать эти несколько строк. С оценкой результата последних работ Гора согласен. Выглядят они действительно чрезвычайно привлекательно. И даже если увидевший их человек, что называется, "не в теме", то скорее всего золотистая орнаментальность ему понравится. Ну а если вы в курсе донкихотского в сущности намерения художника свести к единому, по крайней мере визуальному воплощению духовные практики представителей самых разных конфессий, то почти неизбежно ощутите себя на пороге настоящего искусства. Хотя, при чем тут порог? Настоящее искусство ведь тоже соткано из духовных практик, как бы их не укутывали отстранением, иронией и изощренными интеллектуальными оболочками. Поэтому горовы горящие фигуры, исчезающие друг в друге тексты и изображения - еще и про непростые пути искусства. Бесконечно и микроскопически неуловимого. Ю П> |
| "...если в полуабстрактных формах, сложенных из золотых линий, изображение сакральных пейзажей можно разглядеть лишь с большим трудом, то уж автора в смысловых построениях мы узнаем наверняка. Московский художник Гор Чахал вот уже лет пятнадцать в одиночку штурмует эту вершину. Реконструирует реальность в ее, так сказать, докультурном, дочеловеческом виде. Пытается представить себе пропорции той архитектуры, которая оформляла мир до появления всякой материи вообще. Из проекта в проект можно видеть гигантские компьютерные принты, где огненные тела сгорают при сверхтемпературах в пространстве доисторического вакуума. Припомним также недавний его проект – "Имена Бога", где многочисленные надписи, накладываясь друг на друга, сливались в центре в иррациональную темную субстанцию. Одним словом... Именно что одним словом, тем самым, что, как известно, было "в начале", одержим Гор Чахал – и упорно пытается получить его визуальное выражение". "... зрителю стоит учитывать тот простой факт, что хотя он, зритель, придя на выставку, и станет заполнением той самой сюжетной паузы, к нему здесь никто и не собирался апеллировать. И эти золотые линии будут гнуться и переплетаться, сохраняя ритм независимо от изменений, происходящих в реальном мире, – почему-то хочется в это верить" Антон Горленко, Afisha.ru> |
| <CTHEORY - "Интеллект и репрезентабельность". Льюис Арманд> |
| <В творческом багаже художника Ивана Лубенникова, родившегося в Минске, - оформление Театра на Таганке, музея Маяковского в Москве, русского отдела музея Освенцима и другие объекты. Его живописные работы можно увидеть в Третьяковской галерее, в Русском музее, во множестве частных коллекций. Недавно в московском метро открылся новый выход со станции "Маяковская", над украшением которого и работал Иван Леонидович. Подробнее> |

|
<<"Взгляд
пациента и пьедестал художника".
Иностранная пресса об искусстве - Валентин
Дьяконов. "РЖ", 10 ноября. Болезнь Альцгеймера у посетителей музеев и у художников. Недавно опубликованный очередной рейтинг самых влиятельных персон в мире искусства (Art Review). Рисунок Гитлера (слева), похожий на иллюстрацию к "Похождению бравого солдата Швейка" продан за 5 тысяч фунтов стерлингов> |

|
<<CTHEORY уже откликнулся на события во Франции, статьей Тьери Бардини "France Is Burning"> |
| <<Frieze #95 за ноябрь. О фильме Sharon Lockhart. Беседа Christy Lange с Martha Rosler о политике, феминизме, арт сообществе, медиа и религии. Материалы о Стамбульской биеннале> |

|
<<Британская галерея Tate подверглась критике за намерение купить 13 работ Криса Офили, объединенных в инсталляцию The Upper Room, которая только что была представлена в главном музее Британии. Написанные в течение 4 лет работы дилер Офили Виктория Миро планировала продать не менее, чем за миллион фунтов. Этот вариант был возможен при продаже работ по отдельности. Однако художник настоял, чтобы серия продавалась только целиком, и цена была понижена до 750 тысяч фунтов. Когда же сама галерея Tate проявила интерес к закупке Upper Room, Офили настоял на очередном снижении цены, до 600 тысяч фунтов. |

|
Ситуация осложняется тем, что есть конкурент, американский музей МоМА, готовый платить рыночную цену. К слову сказать, в мае этого года некий американский коллекционер уже выложил за единичную работу Офили миллион долларов. Richard Dorment шокирован сложившейся ситуацией, а Офили и Миро считает "достойными медалей за действия не только в собственных интересах, но и на пользу обществу"> |
| <<Характерный для Штатов конфуз случился перед открытием Ливерморской библиотеки. По замыслу городских властей на фасаде библиотеки была сделана фрезка со 175 ключевыми для истории культуры словами. И среди них оказались "Eistein" вместо "Einstein" и "Van Gough" вместо "Van Gogh."> |
|
<<10 августа Bloomberg
опубликовал статью о появлении в России
галерей современного искусства,
поскольку появились реальные
коллекционеры. 5 галерей мирового класса
это: RuArts,
Stella
Art, Gary Tatinsian, Nashi
Hudozhniki и галерея
Марины Гисич.
Татинцян нью-йоркский дилер, 4 хозяйки
других упоминаемых в статье галерей
открыли их на деньги преуспевающих в
бизнесе мужей. Экспертом проводником по
российскому рынку современного
искусства для Bloomberg послужил глава
Европейского представительства
Гугенхайма Ник Ильин. В качестве
коллекционера в статье фигурирует Игорь
Маркин, "38-летний владелец
производства пластмасс", уже 12 лет
коллекционирующий современное
российское искусство, потративший на
коллекцию из 600
работ около 3 млн. долларов и
планирующий вложить еще 2, 5 миллиона в
строительство своего музея
современного искусства. Противоречие между формировавшимися еще в 90-е коллекциями современного искусства и появлением настоящих галерей только в последние 2 года в статье никак не разрешается. Все, что до прихода больших денег, не заслуживает никакого внимания. Есть Маркин, но нет, к примеру, XL-галереи, в которой Маркин покупал работы и которая в этом году первой из российских галерей участвовала в крупнейшей ярмарке Art-Basel> |
| <<Наши com'овские американские тезки еще летом сообщили о новой ярмарке современного искусства в Майями PULSE, которая пройдет в те же дни 1-4 декабря, что и помпезная Art-Basel Miami Beach. 11 августа уже ArtDaily сообщает о том же. Сайт обнаружить пока не удалось> |

|
<<Dia
Foundation - "un-Guggrnheim". В 2006 году
откроется новое помещение музея Dia
на Манхеттене. Так же как Гугенхайм,
Dia
- это сеть музеев и выставочных
пространств, однако более скромных, чем
сверх амбициозные - по мнению многих,
имперские - проекты Guggenheim
Foundation. <Вот так примерно будет выглядеть здание в Челси, около реки Хадсон. Любопытно используются остатки железнодорожной эстакады> |
|
<<Совместный проект GlobalRus
и Фонда "Прагматика
культуры" начался с профузного
самовосхваления и воспевания бизнеса
как главного агента современного
культурного процесса в исполнении
главного культурного прагматика
Александра Долгина.
Почитать не вредно. "Главное, что
привносит экономика символического
обмена, а я такое название предпочитаю
для этой новой парадигмы, это понятие
качества личного времени и способ его
оцифровывания. Она дополняет денежное
измерение полезности и достраивает
экономику культуры, построенную только
на деньгах, до того целого, которое
позволяет адекватно репрезентировать
действительное качество жизни." Или
вот еще "...о целях человека в
культуре. А цель эта простая –
преумножение качественного личностного
времени. Для культуры хорошо, когда в ней
не только денег много или мест культуры,
или посетителей этих мест – всем этим
легко манипулировать. Что лучше – когда
много зрителей, а увиденное им не
понравилось, или когда людей было мало,
но они были в восторге? Действительным
мерилом доброкачественности или
прогресса в культуре является
преумножение качественного личностного
времени. А качественность личностного
времени определяется очень просто – это
время, которое сам человек высоко
оценивает." Но настоящим дебютом проекта бесспорно является омаж Аркадия Ипполитова сказке о голом короле, "Все или Ничто в Королевской Академии". "...король, раздобыв деньги у Союза Европы, объявил международный конкурс на Проект, и все звезды интернационального кураторника приняли в нем участие. Победили, однако, два куратора, предложившие проект «Все и Ничто», лучше которого ничего и представить себе нельзя: кроме необыкновенной глубины и красивой поверхности, Проект еще отличался удивительным свойством – сразу же указывать всякому человеку, насколько он находится в дискурсе или непроходимо глуп." Развитие сюжета понятно всем ? Особенно хорош пассаж про первого эксперта призванного королем для инспекции кураторов - победителей: "Известный Критик была женщина, высокая худая итальянка с короткой стрижкой, прославившаяся своим интеллектуализмом, и тем, что она всегда носила зеленые чулки. Ее интеллектуализм был столь победителен, что ее даже снял журнал Playboy в одних только зеленых чулках."> |
| <<Bloomberg - 3 августа 2005 года анализирует состояние арт рынка. В целом рост цен за 6 месяцев этого года составил 4,1% по сравнению с прошлым. Отмечена тенденция - все большая доля роста цен приходится на современное искусство. Абсолютные рекордсмены Пикассо и Уорхол, однако для тех покупателей, которых произведения искусства интересуют как инвестиционный инструмент, важней то, что в среднем цены на сontemporary art с 1996 года выросли в 3, 8 раза> |
|
<<Александр Раппопорт (обозреватель
ГЦСИ) размышляет
о нынешних особенностях массового и
элитарного художественного потребления.
Поводом послужила любопытная статья
Кита Брадшера о китайских копиях картин,
наводнивших американский и европейский
рынок художественных изделий, – от
мастеров эпохи Ренессанса до Ван-Гога и
Матисса. "Особенно интересно в данном случае то, что китайские копии ориентируются на европейский традиционный стиль, вызывающий доверие у небогатого и малосведущего покупателя. Интересно – каков потенциал этого рынка и когда в нем начнется эффект пресыщения. Тот же вопрос, кстати сказать, возникает и по отношению к рынку авангарда. И там и тут процесс насыщения и возможные изменения интересов будут иметь серьезные экономические и культурные следствия. Искусствоведение, рассматривающее художественные феномены в контексте культурных стереотипов и экономических механизмов, могло бы извлечь из сопоставления этих полюсов художественного рынка немало интересных наблюдений. Тут ведь всплывает на поверхность новая функция художественных традиций как фона потребительского понимания искусства и своего рода массового мифа, равно как и мифа авангарда, считывающегося на этом фоне. Иными словами тут мифология художественных ориентаций прямо влияет на экономические и культурные процессы"> |
|
<<Business
Week "Искусство в сети: вторая волна".
Несколько лет назад интернет был полон
компаниями, пытавшимися продавать
произведения искусства онлайн. Не
смотря на то, что по данным компании
JupiterResearch только в США объем онлайновых
продаж достиг 79 миллиардов долларов в
год, а к 2009 году ожидается удвоение этого
показателя, доля продаж искусства
исчезающе мала. Однако новых
энтузиастов обуревает вторая волна
надежд, в первую очередь связанная с
продажами работ никому не известных
художников. Кому как не нам знать об этом :) Продается только тиражная чепуха, по дешевке. Ю П > |

|
<<Гигантсткие инсталляции Ричарда Серра заняли первый этаж музея Гугенхайм в Бильбао минимум на 25 лет. 8 июня состоялось официальное открытие. Даже если кураторы захотят обновить экспозицию, это будет не просто - за 15 миллионов евро сооружена самая экстравагантная и массивная из музейных инсталляций. Сам художник оценивает нынешнюю работу как самую трудную, но и радостную в жизни.> |
|
<<В следствие разногласий среди
организаторов Пражской биеннале 2003 года,
2-я
биеннале в Праге фактически
представляет собой два фестиваля.
Один, “PragueBiennale2”
до 15 сентября проходит в бывшем
промышленном сооружении за чертой
города, второй, “Prague
International Biennial of Contemporary Art” до 11 сентября
- в Национальной галерее. После
Тиранской биеннале 2001 года знаменитый
куратор и издатель Flash
Art Полити (Giancarlo
Politi) решил больше
не работать с Албанией и взялся за
Пражскую биеннале со своим другом Knizak'
ом. Однако, по словам
Полити, сотрудничества не получилось.
Национальная галерея фактически
саботировала фестиваль. Вплоть до того,
что для копирования материалов или
отправки почты приходилось идти в
интернет кафе. А друг Knizak
сделал выставку трех чешских художниц
вне контекста фестиваля. В итоге Полити
основал Prague Biennale Foundation и сообщил
Национальной галерее, что не будет
сотрудничать с ней в 2005 году. “PragueBiennale2”
оказалась изолирована от всех
выставочных помещений в городе и
обосновалась на пригородном складе. Knizak в каталоге “Prague International Biennial of Contemporary Art” пишет, что государственная институция не может сотрудничать с сомнительными партнерами. Эта биеннале проходит под патронажем президента Чехии, финансируется государством и Панасоником. Помимо чешских художников куратор Lynne Warren (Museum of Contemporary Art, Chicago) пригласила американских и чилийских художников. Полити призвал под свои знамена новых европейских живописцев, например, Лейпцигской школы, политических акционистов из Латинской Америки, организовал раздел Чешского и Словацкого искусства, китайской живописи. Центральная экспозиция состоит из 100 живописных работ, в том числе Дамиена Херста и Маурицио Каттелана. Отметим, что наши "Синие носы" участвуют в “PragueBiennale2”. Основной сайт www.praguebiennale.org принадлежит “PragueBiennale2”. “Prague International Biennial of Contemporary Art” воспользовалась сайтом Национальной галереи. Ю П> |

|
<<Не смотря на успех пятимесячной
выставки 160 живописных работ
международной группы художников Stuckists
в ливерпульском Walker Art Gallery
("Stuckists Punk Victorian",
до 20 февраля 2005 года), Tate
Museum отклонил предложение принять эти
работы свою коллекцию. Директор Tate сэр Nicholas Serota
заявил буквально следующее: "Мы не
чувствуем, что эти работы обладают
достаточным совершенством,
инновационностью или оригинальностью
мысли, для того чтобы хранить их в
национальной коллекции". Ряд
экспертов утверждают, что эти художники
"возвращают одухотворенность и смысл
в искусство, культуру и общество".
Основатель Stuckists Charles Thomson считает
позицию музея снобизмом. Он напомнил,
скольких трудов стоило убедить Tate
принять работы Пикассо в 20-е и Генри Мура
в 30-е годы. При этом среди 160 работ есть
карикатура на директора Tate, выполненная
самим Томсоном. Вообще движение
Stuckism International
строится на противостоянии
концептуализму, на прокламациях о его
смерти> <Одна из работ Томсона "Женщина с длинной рукой"> |

|
<<Кристо и Жан-Клод прошлой зимой оснащавшие нью-йоркский Центральный парк тысячами ворот с оранжевой тканью, 26 июля начали новый раунд переговоров с властями Колорадо о реализации следующего масштабного проекта, укрытия тканью двух с половиной миль реки Арканзас. Властям, с одной стороны, не дает покоя успех нью-йоркского проекта, в первую очередь финансовый, а с другой, оппоненты настаивают на принципиальном отличии природного каньона от Центрального парка. Они не выработали убедительных аргументов для остановки проекта, но твердо уверены, что "драпировка каньона" ничего хорошего природе не принесет. Denver Post> |

|
<<Открывшаяся 16 июля в Art Institute of
Chicago выставка "Тулуз-Лотрек и
Монмартр" неожиданно становится
блокбастером. За неделю ее посетили 27600
человек. Руководство музея недоумевает,
по каким причинам эта выставка выставка
вызвала больший интерес, чем
проходившая год назад "Манэ и Море". Выставка продлится до 10 октября и, похоже, установит рекорд посещаемости для Чикаго> |

|
<<Парижский Лувр получает в подарок 20 млн. долларов от Саудовской правящей династии. В результате появится новое крыло музея Исламского искусства. NYTimes> |

|
<<Виктор Вексельберг,
сравнительно недавно отличившийся
покупкой коллекции яиц Фаберже за 100 млн.
долларов, живущий в Петербурге нефтяной
и угольный миллиардер, чье состояние Forbes
оценил в 6.1 млрд. долларов, организовал
Фонд поддержки российского искусства. ArtNewsPaper
подает материал об этом под таким
названием - "Украинский миллиардер
учреждает новый фонд поддержки
российского искусства">
<ArtNewsPaper о торгах российским искусством ХХ века на аукционе Sotheby's> |
| <<"Брудастые понты" - Андрей Ковалев, РЖ, 9.07.2005. Третьяковка, XL на Арт-Базеле и что осталось от Тимура Великолепного> |
<<VIDEOBRASIL
- 15-ый Международный фестиваль электронных
искусств пройдет 6-11 сентября 2005 года в Сан-Пауло.
На примере этого фестиваля в июльском NYArts
обсуждаются тенденции и пути развития
аудиовизуального искусства> <<В этом же журнале - об итогах ярмарки Art Basel 2005 (15 - 20 июня). Любопытен "хор" составленный из цитат, соревнующихся в пафосе: Basel Art Fair maintains its international leadership - International Herald Tribune Olympics of Art World - New York Times A Modern Art Mecca - Wall Street Journal ...Art Basel, the non plus ultra of fairs - The New York Observer Billed as the biggest and best contemporary art fair in the world - Financial Times, London Europe's most prestigious 20th-century art fair - Wall Street Journal Europe ...firmly established as the leading event in the crowded field of modern and contemporary art fair - The ARTnewspaper, New York Art in Basel is the foremost fair for modern and contemporary art - Art Now Gallery Guide, Clinton/NJ ... annual gathering place for many of contemporary and modern art's heaviest hitters - Art & Antiques, New York La plus belle foire du Monde - Le Monde, Paris Numéro un mondial des foires - Le Figaro, Paris Des collectioneurs du monde entier, des oeuvres de qualité musée: le barométre revé pour connaitre l'état du marché - Les Echos, Paris ...le plus grand musée temporaire - Journal de Gen-ve Kunst in ihrer besten Art - Unangefochten: Die Art in Basel - Frankfurter Allgemeine, Frankfurt Weltweit wichtigste Messe für moderne und zeitgenssische Kunst - Neue Zürcher Zeitung, Zürich ... nach wie vor wichtigste Marktveranstaltung für die Kunst des 20. Jahrhunderts - Finanz und Wirtschaft, Zürich) ... die weltbeste Kunstmesse - Focus Magazin, München ...die wichtigste Messe für die Kunst unseres Jahrhunderts - Süddeutsche Zeitung, München Als wär's ein Moderne-Museum - Frankfurter Allgemeine Zeitung Mostra leader per l'arte del XX secolo - Il Sole 24 Ore, Milano ...la pi- importante mostra-mercato del mondo - Milano Finanza Il pi- bel museo a termine del mondo - Vogue Sin lugar a dudas, la feria principal - El Mundo, Madrid ...la mas importante y profesional del mundo - La Vanguardia, Barcelona ...el centro de todos los intercambios artisticos de Japan, USA y Europa - El Mundo, Madrid Las últimas corrientes artisticas - El Pais Baselmässen tar ut svängarna rejält - Svenska Dagbladet, Stockholm |

|
<<"Брось" (в смысле - наплюй,
"SNAP out of it") - подходящая реакция на
нью-йоркскую арт индустрию после пары
сезонов преобладания прихотливой и
скучной живописи и графики. Похоже, арт
сообщество прислушивается к таким
словам и добавляет в свое диетическое
меню концептуальную начинку. Перед лицом возврата к традиционным ценностям: искренности, красоте и объекту, - вкладу арт истеблишмента в культуру начала XXI века, люди опять начинают спрашивать: почему ирония не может быть искренней? Почему идеи не могут быть красивыми? Ряд галерей Челси отдают свои пространства эфемерным проектам, пытающимся представить искусство скорее как приключение, нежели как напряженные "инсайдерские игры". Из всех летних событий обозреватель NYTimes Holland Cotter отдает предпочтение "Bridge Freezes Before Road" Барбары Глэдстоун (Barbara Gladstone) и ретроспективе романтика минималиста Смитсона в музее Уитни> |

|
<<Мнения ученых по поводу постбиологических перспектив человеческой цивилизации далеко не однозначны. От радикальных надежд на то, что биологические достижения положат конец долгим ожиданиям коренного и сущностного преображения человека, прорыва в духовные измерения к свободе и равенству… До консервативного стремления к запрету пугающих биологических экспериментов. Искусство конечно же не остается в стороне. Антология "BioMediale. Современное общество и геномная культура", изданная усилиями Калининградского филиала ГЦСИ и, в первую очередь, энтузиаста и главного нашего знатока этой проблематики Дмитрия Булатова, впервые в России обращает внимание на стратегии современного искусства в поле культурных рефлексий по поводу развития био- и генных технологий. |

|
Randy Kennedy в NYTimes 3 июля 2005 года: "...био арт репрезентируется как логически следующий шаг в развитии современного искусства... Видео арт в 60-е - 80-е, цифровые технологии и интернет в 90-е и био арт в 2000-е. Однако био арт притязает на более революционный разрыв с традицией..." |

|
<<BBC
News: Новый аукционный рекорд. На сей раз
за 16.8 млн. фунтов продана работа Каналетто.
Рекордная для работ этого художника
цена вдвое превысила эстимейт на
лондонском аукционе Christie> <"The Bucintoro at The Molo, Venice, On Ascension Day". Giovanni Antonio Canal, Il Canaletto (1697-1768)> |

|
<<С 23 июня - 23 октября в музее
Whitney выставка Robert
Smithson. Умерший в
возрасте35 лет (в73 году) Смитсон
остался одной из самых заметных фигур
американского послевоенного искусства.
В первую очередь своими гигантскими "земляными
работами". <Работа 70 года "Spiral Jetty (Rozel Point, Great Salt Lake, Utah)"> <Cтатья в NYTimes о выставке и творчестве Смитсона> <"Роберт Смитсон, последний романтик" - ArtTopia, John Perreault's Art Dairy> |

|
<<ArtNews
опубликовал 15-й список 200 наиболее
активных коллекционеров искусства. В
опросе принимали участие коллекционеры,
дилеры, музейные работники, кураторы и
консультанты из 22 стран. TOP TEN: Debbie и Leon Black, Edithe и Eli Broad, Steven Cohen, Laurence Graff, Marie-Josee и Henry R. Kravitz, Evelyne и Leonard Lauder, Jo Carole и Ronald S. Lauder, Mitchell Rales, Charles Saatchi, Elaine и Stephen A. Wynn> <Debbie Black> |

|
<<"...подсудимый мне сказал,
сушай, я такую личную неприязнь к
потерпевшему испитываю, что даже кюшать
не могу". Бывший и нынешний
руководители российской культуры
выступят в роли истца и ответчика в суде.
Уязвленный публичным обвинением в
повальном увлечении "откатами" в
подведомственном ему ФАККе, Михаил
Швыдкой вчиняет иск своему
непосредственному начальнику
Александру Соколову. Источников море, но
мы традиционно предлагаем gazeta.ru> <1.07.05 - "Нарушив обет молчания, министр Соколов пояснил, зачем он обидел Швыдкого, которому теперь грозит расследование парламентской комиссии" - gazeta.ru> |
|
<<"Волобуев!
вот твой меч!" - Андрей Ковалев,
РЖ, 5.07.2005 О министерской тяжбе, мести Мизиано и о прозорливости исторического материалиста Хачатурова на фоне великолепия художественных обозревателей - по поводу выставки Тони Крэга - "Все эти твердокаменные сопли и керамические всхлипывания были популярны в те же восьмидесятые у менее именитых (на мой взгляд, по причинам сугубо материалистическим) советских художников, оформлявших общественные пространства релаксации трудящихся (скверы, площадки, дворики в театрах)"> |
|
<<"Первая
ярмарка, где я вообще не волнуюсь".
Куратор XL-галереи Елена Селина - "ГАЗЕТЕ".
В один из последних дней работы
грандиозного арт-форума «Арт Базель» с
его участником, куратором московской XL-галереи
Еленой Селиной встретился
корреспондент ГАЗЕТЫ Сергей Сафонов. - Каким оказался итог вашей поездки в Базель? - Я считаю наше участие успешным. Во-первых, нас взяли; я очень этого хотела, но не ожидала. Даже если бы мы отсидели здесь «насухую», это все равно было бы значимо: в Базеле узнали бы русскую галерею. А то, что работы стали так бодро продаваться, - я все-таки это просчитывала. У нас в Москве очень плохо понимают - и художники, и многие галеристы, - что любая западная ярмарка это не только место, где можно купить произведения, но и место, которое играет огромную роль в карьере художника. То есть художник, явленный на стенде галереи, помимо того, что он попадает в ситуацию рынка, попадает еще и в ситуацию некоммерческую. Мы годами ездили на «Арт Форум» в Берлин, после чего оставляли там работы, и многие брали их на выставки - вот почему у XL такая сильная музейная история. Многие художники бывали впервые замечены именно на ярмарочных стендах. ... - Есть ли интерес европейской арт-прессы к ярмарке и участию в ней XL? - Телевидение; анонс в Herald Tribune, написанный с очень большой симпатией. Но я не хотела вот этой брудастости: русские идут. Мне хотелось показать, что мы абсолютно самостоятельная единица, которая не маргинальна и не выпендривается какой-то особенной национальной идентичностью. Contemporary art не имеет границ; другое дело, хороший художник или плохой. Я могла бы накачать все «звездами», но мне это претит. Мне приятно, когда говорят: «Вот это классная галерея. А кстати, откуда она? - Из Москвы». Для меня вот эти понты важнее. |

|
<<Видео арт входит в моду среди коллекционеров. Во всяком случае деньги на приобретение работ известных художников тратятся вполне соизмеримые с ценами на арт объекты. Проблему домашенго экспонирования или инсталляции коллекционеры решают в меру своих возможностей и степени экстравагантности. NYTimes публикует фото гаражной видео инсталляции, а также слайд-шоу с примерами других решений. Полезно познакомить наших потенциальных покупателей :) Ю П> |

|
<Видео инсталляция Билла Виолы в конторе> |

|
<<"Печальное положение современного российского искусства отобразилось в притворной Московской биеннале" - ArtNewsPaper цитирует Виктора Мизиано, - "Биеннале была оплачена правительством в попытке создать западный фасад для новой России... 2 млн. долларов были потрачены на бледную репродукцию западной биеннале. Даже время проведения биеннале обусловлено циничными причинами". Заголовок статьи - "Имитация демократии порождает имитационное искусство"> |
|
<<Лондонская
"Times" отмечает новый тренд
корпоративного коллекционирования
искусства. Собственно, новизна его лишь
в массовости, начало же было положено
относительно давно Дойче
банком, рассматривающим свою коллекцию
не только и не столько как
инвестиционный инструмент, но как
способ изменения облика своих
отделений и даже рабочих мест служащих. Любопытны направления коллекционирования, выбранные различными компаниями. По московской выставке, представлявшей коллекцию Дойче банка, мы знаем, что в ней представлено исключительно искусство Германии, в основном относительно недорогая графика. Компания Hiscox, следуя вкусам Robert Hiscox'а, собирает русский авангард, в первую очередь конструктивизм. Не известно, в каком из помещений компании висят работы Малевича, но в коллекции они есть. В Лондоне, в музее Power устроена первая выставка, собранная из таких корпоративных коллекций> |

|
<<Никак не
удается согласовать проект нового
небоскреба, который планируется
построить на месте рухнувших башен-близнецов
на Манхеттене. Даниелю Либескинду
скорее нужен талант общения с
бюрократами и политиками, нежели
собственно архитектурные достижения. <Об этом же NYDailyNews> <Фотогалерея, дающая представление о состоянии проекта> |

|
<<Пол Маккарти (McCarthy) перестал быть "художником для художников"... Его грандиозная выставка LalaLand parodie paradies, работающая до конца августа в мюнхенском Haus der Kunst (заложенном самим фюрером немецкой нации), условно говоря, "перпендикулярно всему": |
|
"Это кошка, это мышка, это лагерь,
это вышка..." Я не уверен, что тут
уместно было вспоминать о том, что Уолт
Дисней был горячим поклонником Адольфа
Гитлера. И - еще смешнее - деятельно
сотрудничал вот именно с комиссией
Маккарти в архиважном деле - выявлении в
среде своих работников
коммунистических настроений, почему-то
в основном у лиц еврейской
национальности..." (эта и далее -
цитаты из текста Александра Мильштейна
"Фарсификатор"). "В общем, терем-теремок. А кто в этом теремочке живет... Разве не ясно? Для непонятливых было отснято специальное видео, оно снималось параллельно со строительством терема... Вокруг проложены рельсы, по которым, очевидно, ездила камера во время съемок... Видео можно теперь лицезреть сразу на десяти экранах, вставленных в деревянную стену теремка, причем - это тоже было сказано во вводной речи - Пол Маккарти недолго думая просто отдал камеру актерам, и они сами себя снимали... Шесть или семь довольно известных немецких актеров одновременно - благодаря множеству экранов - хлещут пиво "аугустинер", ссут, маршируют в синих кителях, но без брюк и без трусов вокруг Haus der Kunst, купаются голые в Айсбахе, демонстрируют на полянке самые разные свои мускулы и еще черт знает чем занимаются". |

|
<<С 23 июня - 23 октября в музее
Whitney выставка Robert
Smithson. Умерший в
возрасте35 лет (в73 году) Смитсон
остался одной из самых заметных фигур
американского послевоенного искусства.
В первую очередь своими гигантскими "земляными
работами". <Работа 70 года "Spiral Jetty (Rozel Point, Great Salt Lake, Utah)"> <Cтатья в NYTimes о выставке и творчестве Смитсона> <"Роберт Смитсон, последний романтик" - ArtTopia, John Perreault's Art Dairy> |
| <<"...неоакадемизм как проект Тимура Новикова был гораздо более критичен по отношению к обществу, нежели громогласное левачество Осмоловского и Бренера. Устроенная Новиковым бесконечная клоунада под названием "неоакадемизм" жестко и бескомпромиссно вскрывала пороки общественного устройства" (Андрей Ковалев, "Перезагрузка матрицы", "Московские новости"/ 24.06.) По поводу выставки "Художники круга Тимура Новикова" в галерее RuArts> |

|
<<Высказывание министра
культуры Бразилии Гильберто Гиля:
«Конечно, мы все за свободный софт, но дело в
том, что компьютеров бы вообще не возникло,
если бы контркультурщики в 1960-е годы не ели
так много ЛСД»> <<+ В Нью-Йорке вышла книга колумниста New York Times Джона Маркоффа «What the Dormouse Said… How the 60s Counterculture Shaped the Personal Computer Industry» («Что сказала Соня? Как контркультура 1960-х сформировала индустрию персональных компьютеров»). Информация www.getto.ru> |

|
<<Недавно завершилась
крупнейшая ярмарка
Арт-Базель, но
коллекционерам нет покоя. На этой неделе
несколько аукционов, среди которых на
двух лондонских будет современное
искусство: 22-23
июня Сотбис (New Bond
Street) и 23-24
июня Кристи (King Street,
St. James's). Блумберг
об аукционах и NYTimes
об итогах аукционов> Лот 32 23.06 - Jean-Michel Basquiat (1960-1988) -
Untitled, 1982.
Estimate: £1,000,000-1,500,000. |

|
|
<<Скрежет, бульканье, жужжание, которые слышат пассажиры железных дорог, составили основу звуковой скульптуры купленной в муниципальную коллекцию графства Йоркшир. "Звуковой художник" (sound artist) - американец Bill Fontana> |
|
<<3000 студентов приняли участие в конкурсе живописцев в индийском штате Кашмир с 20 по 26 июня> |
|
<<До 10 июля трехнедельный 9-й Фестиваль классического искусства в Цюрихе: опера, концерты, театр, балет и выставки. 70000 посетителей для Цюриха - превосходный результат> |
|
<<21.06 Сотбис провел весьма удачный аукцион импрессионизма и модерна. На 84 млн. долларов> |
|
<<20 июня торги аукциона Bonhams вызвали изрядный конфуз - за £14,400, в 20 раз выше эстимейта была продана живописная работа шимпанзе (CBS об этом же)> |

|
<<Мексиканская художница и
фенистка Фрида Кало
(1907-1954) достаточно популярна среди нынешних
женщин звезд поп-культуры. Мадонна покупает
картины Кало, Сельма Хайек сыграла ее в
голливудском фильме 2002 года "Frida".
Можно пожалуй назвать ее нынешней
феминистской иконой. Все требуемые
атрибуты на лицо: пылкая
революционность с еще более бурной личной
жизнью в постреволюционной Мексике. Выставка
в Tate Modern (с 9 июня до 9
октября) обещает стать летним музейным
блокбастером. Слова специалистов, вроде
того, что "изобретательность Кало много
лучше чем то, как она реализовывала
собственные идеи" вряд ли сыграют хоть
какую-нибудь роль в гарантированном успехе
выставки. Уж слишком убедителен набор
качеств: женщина, мексиканка, бисексуалка и
инвалид - вряд ли арт критикам под силу
отделить "ее жизнь" от "ее искусства".
Публика против. Подробнее
в Int. Herald Tribune> <"Автопортрет с обезьянкой", 1938. Albright-Knox Art Gallery, Buffalo NY Bequest of A. Conger Goodyear, 1966. |
| <<Выпуск ArtNewsPaper Daily - "Крен на Китай" - о приезде на ярмарку АртБазель большой делегации китайских художников, коллекционеров, кураторов, архитекторов и бизнесменов. Причем по специальному приглашению руководства ярмарки. Вся эта команда из Базеля переместилась в Венецию> |
|
<<Выпуск
ArtNewsPaper Daily о ярмарке Арт-Базель
(весьма, кстати, критический) можно скачать (pdf)
и, распечатав на цветном принтере, иметь
бесплатно. Хороший пример для других
связанных с арт сценой изданий. Не трудно заметить, что согласно диаграмме российские художники составляют 2% от участвующих в 2005 году. Американцы - 24%, немцы - 14%, французы - 7%, итальянцы и швейцарцы - по 5%, далее - 3-2-1%> |
| <<Россия готова вернуть Нидерландам коллекцию рисунков и картин, вывезенную из Германии, хранящуюся в Пушкинском музее, которая может быть российской частью известной коллекции Кенигса (другая часть этой коллекции ранее находилась в собственности Украины, которая уже вернула ее Нидерландам)> |
|
<<Jerry Saltz на первый взгляд
чрезмерно резок в отношении аукционов
современного искусства, которые по его
мнению "диковинная комбинация
невольничьего рынка, театра и борделя".
"Когда консьюмеризм обретает сакральность,
искусство начинает играть роль жертвенного
нимба". "Аукционы весьма похожи на
стриптиз: они опираются на людей,
соблазненных возможностями своих денег".
Особую неприязнь Джерри вызывают
аукционисты, "гнусно напевающие свои
математические песни: у меня есть 4 миллиона,
услышу ли я 5 миллионов?". Само собой,
Зальц считает опасным быстрый скачек цен. К
примеру, фотография Метью Барни, одна из
тиража в 10 экземпляров, продана за 200 000
долларов, а еще год назад пачку таких же
можно было видеть в студии Барни. Нельзя избежать монетаристской стороны искусства, поскольку всегда в избытке люди, для которых главное купля-продажа. Зальца раздражают другие, богатые коллекционеры и их "отродье", которые вместо того, чтобы дарить лучшие работы музеям или, в случае особых житейских ситуаций, продавать некоторые работы, выставляют на аукционы целые коллекции. Эта публика понятия не имеет о том, что значит собственно искусство. Равно как и аукционные дома, их интересуют лишь деньги и паблисити. Жадность и тупость большинства людей покупающих и продающих на аукционах породила то, что Джерри Зальц называет "параллельным рынком". Аукционные цены зачастую очень далеки от цен на работы того же художника в галереях. Их вздувают "трейдеры", ориентированные на профанов, готовых потратить 500 тысяч на то, что можно купить за 50. Зальц заявляет, что озвучил то, о чем думают практически все, работающие в системе современного искусства. Все жалуются на заоблачные аукционные цены и в приватных беседах говорят, что ненавидят аукционы. Однако слишком многие уже запачканы этими шальными деньгами, и потому "рот на замке". Порочный круг. Аукционы всегда были и будут коммерческими. Однако Зальц считает, что после неизбежного окончания нынешнего "периода перегрева" очень многим придется извиняться, а наиболее ловким открещиваться, доказывать, что ни коим образом не были замешаны в этих "мерзких вещах". The Village Voice/ May, 26/ 2005> |

|
| <<92-й номер Freez. Специальный SMS-сервис: 3-4 sms-ки в день, начиная с открытия Венецианской биеннале. Что, где - новости и рекомендации. Подписаться можно, отправив письмо на адрес admin@frieze.com с указанием номера телефона (с кодом страны). Интересна также беседа Francesco Bonami и Charles Esche о биеннальном движении> |

|
<<Арт
сообщество испытало шок от объявления номинантов
нынешнего Turner Prize.
Живописец Gillian Carnegie среди номинантов. Вот, к
примеру, один из ее натюрмортов. Cаатчи
с недавних пор перешел на живопись, не так
ли? Победитель будет объявлен 5 декабря> |
|
<<Российский суд над
организаторами выставки
"Осторожно, религия!" не уникален. В
Греции к суду привлечен куратор Christos Ioakimidis,
организатор выставки современного
искусства в рамках Олимпийских игр.
Обвинение требует 5-летнего наказания за
"cоединение христианской и сексуальной
символики" в работе бельгийского
художника Thierry de
Cordier (участника
Венецианской биеннале 1997 года), входившей
в состав выставки. Подробнее
BBC> С октября 2004 года по 31 января 2005 выставка Cordier была в Центре Помпиду> |
| <<Мерилин Монро заткнула за пояс многих художников. Если оперировать аукционными ценами. Нарисованная ею в 62 году для Джона Кеннеди (но так и не подаренная) розочка ушла за 78000 долларов. Утешает лишь стоимость телефонной книжки, достигшая 90000 долларов :)> |
| <<Французский ответ музею Гугенхайм в Бильбао не состоится. Затевавший строительство музея современного искусства в Париже миллиардер François Pinault изменил свои планы. Хотя есть точка зрения, что ему в конечном счете не дали развернуться, а бывший министр культуры посодействовал в поисках достойной замены. Теперь свою коллекцию современного искусства Pinault разместит в недавно купленном венецианском дворце XVIII века Palazzo Grassi. И это не смотря на 26 млн. долларов, уже потраченные на проект японца Tadao Ando. ArtNewsPaper> |
| <<Несколько последних лет, не без помощи сми, в игровом сознании финансистов сложилось представление о современном искусстве как выгодном инвестиционном инструменте. И они устремились на ярмарки, аукционы и в галереи. Анализ ситуации в ArtNewsPaper> |
| <<Россия вернет Нидерландам коллекцию Franz Koenigs, вывезенную из Роттердама в Дрезден в 1941 году, а затем в саксонский замок Wesenstein. В 45-м 307 работ Рембранта, Рубенса, Дюрера, Ван дейка и других были вывезены в СССР - interfax.com> |

|
<<NYTimes
о проекте Культурного центра для Ground Zero.
Подсвеченные мемориальные бассейны - на
месте оснований разрушенных "Twin Towers"> |

|
<<Вышел майский номер Artforum'а. Материалы о предстоящей 51-й Венецианской биеннале и еще о 50 событиях мировой арт сцены. Герои номера Daniel Buren, Olafur Eliasson, Tino Sehgal, Seth Price, Rudolf Stingel и главный, Robert Gober> |

|
<<NY
Times - о предстоящих аукционах. Еще 10 лет
назад коллекционеры предпочитали
тратиться на импрессионизм. Не то теперь.
Новейшее искусство притягивает "голодных
покупателей" мультимиллионеров. Арт
дилеры, занимающиеся новейшим, потирают
руки - дождались своего часа, когда их
сектор стал самым растущим на арт рынке. Однако, рост ростом, но цены на импрессионистов по-прежнему заоблачные. Достаточно назвать "Boy With a Pipe" Picasso, проданного на Sotheby's за 104.1 млн.$.> <Sotheby's эстимейт на "Self-Portrait With Crystal Ball", Max Beckmann's (3-4 мая, Нью-Йорк) )$10 - $15 миллионов> <Современное искусство на Sotheby's 10 мая, Нью-Йорк> <Современное искусство на Cristie's 11-12 мая, Нью-Йорк> |
| <<"Накатившая на нас эпидемия патриотического воспитания заставила обычно предельно тактичного Сергея Хачатурова разразиться следующим пассажем по поводу начавшихся "победных" выставок. "Уважим, мол, вкусы людей военного поколения и сделаем просто и понятно, реалистично и патриотично, в духе живописи Ефанова и Герасимова. Такая презирающая правду истории и законы адекватного нашему времени художественного языка позиция неприемлема потому, что грешит тем же, что и "альтернативная" ей - сформированная на руинах постмодернистской "тотальной иронии" и субкультурной трэшевой поэтики. В обоих случаях мерзок цинизм. Мерзко бесчувствие. Бестактность" ("Каллиграфия Победы", "Время новостей" от 22.04.)" - "Люди - туда!"/ А. Ковалев, РЖ> |
|
<<Чарльз Саатчи, коллекционер и
арт-магнат, который сам по себе является
национальным культурным достоянием
Великобритании, распродает под шумок
коллекцию классики современного
британского искусства. Сначала он продал акулу в формалине, самую знаменитую работу Дэмиена Херста. «Естественная история» ушла в декабре за 6,25 миллиона фунтов – почти двенадцать миллионов долларов. Голова современного художника Марка Куинна, отлитая из его собственной замороженной крови, продана за $3 млн. Чарльз Саатчи не верит в бритарт. Он считает, что все «великие» британские художники конца ХХ – начала ХХI века «останутся лишь примечанием в истории искусства». Саатчи собирается покупать Китай. Gazeta.ru> |

|
<<Вышел очередной номер журнала INDEX, издатели которого любят, вслед за NYTimes, назвать свое детище "барометром контркультурного шика" (?)> |
| <<«Что движет теми, кто царапает автомобили? Зависть? Ненависть? Месть? В порче машин есть сильный креативный, эмоциональный элемент. При этом есть фактор страха – неотъемлемая часть этого художественного процесса. Порча автомобилей при помощи ключей стала сейчас настоящей эпидемией. Я хочу привлечь к этому внимание, и как знать, может быть, это станет мейнстримом, как когда-то граффити» - заявляет акционист Марк Макгован. Gazeta.ru> |

|
<<В Нью-Йорке начала 90-х граффити с подписью Revs было везде: от Сохо до Нью-Джерси. На примере Revs выросло следующее поколение уличных художников. После ареста за вандализм его постоянного партнера Cost' а Revs уехал на Аляску, а вернувшись, переключился на туннели метро. По его словам, это его миссия, и ему наплевать, сколько человек увидит его работы. Пару лет назад Revs вернулся в публичные пространства. Как вполне легитимный скульптор, работающий с металлическими конструкциями. Улицы East Village, Gowanus Canal и Dumbo стали его галереями. Вместе с тем, в отличие от изменивших "улице", взявшихся за коммерческую карьеру коллег, Revs по-прежнему дистанцируется от конвенционального искусства. Только раз, в 2000 году он делал галерейную выставку в Филадельфии, специально объяснив, что после очередного ареста в метро ему срочно нужны деньги на адвоката. Во всех других случаях он последовательно отказывается продавать свои работы или брать комиссионные от их продажи. "Если за деньги, то это фальшивка" - его ответ корреспонденту NYTimes, обильно пишущему о нем> |
|
<<Гос. деп. США и NEA (National Endowment for
the Arts) подписали соглашение об учреждении
комитета, который будет отбирать
американских художников и кураторов для
участия в важнейших международных
выставках, таких как Venice, São Paulo, Sydney, Cairo,
Cuenca, Istanbul, Dakar, Documenta. Известно, что с прошлого года американцы оказались в сложной ситуации - под сомнение ставилось даже участие в предстоящей 51-й Венецианской биеннале. Причина тривиальна - развал существовавшего более 17 лет специального Фонда в связи с выходом из него двух крупнейших учредителей: Pew Charitable Trusts и Rockefeller Funds. Пришлось обращаться за поддержкой к 4-м музеям: Guggenheim, Hirshhorn, San Francisco Museum of Modern Art и Whitney, которые выбралм Ed Ruscha и пригласили куратором Линду Норден из Гарвардского университета. Подробнее> <<Еще бытует представление о влиятельности арт критики, которая может сделать или разрушить карьеры художников. Однако теперешняя ситуация в системе искусства заставляет усомниться в этом. Например, директор влиятельнейшей ярмарки ArtBasel Samuel Keller считает, что арт критики потеряли ауру могущества, но стали скорее философами, серьезно уступая во влиятельности коллекционерам, дилерам и кураторам. Как следствие арт критики становятся едва ли не беднейшей составляющей арт системы. Такие известные издания как Art Forum, Frieze или Art in America платят не более 100 - 150 долларов за обзор... Подробнее> |
|
<<Никита
Алексеев "Постоянство таяния снега"
(РЖ). О "Коллективных действиях", 1-й 76
года "Появление", 104-й акции 11 апреля 2005
года "Луна-парк": "на рыхлом сером снегу большие листы бумаги с какими-то черно-белыми изображениями и текстами, четыре слева, четыре - справа. Между ними кладет черный лист, ставит на него голубовато-коричневый лунный глобус. Все. Подхожу, смотрю, сразу узнаю. Это - увеличенные страницы одного из номеров 1977 года только-только начавшего тогда выходить журнала FlashArt, живого до сих пор. На страницах - статьи о работах знаменитостей современного искусства Йозефа Бойса, Клауса Ринке, Урса Люти, Руди Шварцкеглера. На одной из страниц - статья о первых акциях "КД", оказавшаяся в журнале благодаря стажировавшейся в Москве итальянской студентке, приятельнице издателя "FlashArt", как-то познакомившейся с нами и переправившей фотографии и тексты в Италию... тридцать лет назад искусство было серьезным, тяжелым, а теперь - легкое, развлекательное"> |
| <<Для ирландской художницы Rita Duffy гигантский айсберг, который она собралась пришвартовать у берега столицы Северной Ирландии Белфаста, является наиболее красноречивой метафорой происходящего в североирландском обществе, чье политическое и эмоциональное состояние, как она считает, является "глубоко замороженным". Она надеется, что таящий на глазах североирландцев айсберг окажет на них очищающее воздействие. Подробнее в Guardian> |

|
<<Британский
графитчик Банкси (Banksy) сразу в 4-х нью-йоркских
музеях: Museum of Modern Art, Metropolitan Museum of Art, Brooklyn
Museum и American Museum of Natural History.
<<Портрет Банкси, который
теперь в Бруклинском музее. <<Сайт Банкси>
|

|
<<"Двое
организаторов выставки "Осторожно,
религия!" признаны виновными в
разжигании религиозной вражды". Оглашая приговор (штраф - 100 тысяч рублей каждому), суд учел смягчающие вину подсудимых обстоятельства, в том числе активное участие Ю. Самодурова и Л. Василовской в общественной жизни и правозащитной деятельности. Суд признал их виновными по статье 282 УК РФ - возбуждение религиозной вражды, при этом исключив состав преступления, касающийся "возбуждения ненависти". Третью обвиняемую - художницу Анну Михальчук, суд оправдал, признав, что в ее действиях нет состава преступления. <<BBC 28 марта> <<"Reason" (статья из Boston Globe, 23.03)> |
|
<<Сегодня
28 марта в Таганском суде будет вынесен
приговор по делу устроителей выставки
"Осторожно, религия!". "Завтра
суд" - А.Ковалев - РЖ, 26.03. |

|
<<Rosalind Krauss, Hal Foster, Yves-Alain Bois и
Benjamin HD Buchloh написали фундаментальную 707-страничную
"A LANDMARK
STUDY IN THE HISTORY OF MODERN ART" (45
фунтов здесь). Здесь
в файле pdf полное оглавление. Завершает
книгу стенограмма круглого стола "The
Predicament Of Contemporary Art", разговор авторов о
затруднениях, имеющих место в современном
искусстве. <В Гардиан недоброжелательная рецензия Джонатана Джонса. <4 апреля в Tate Modern предстоит обсуждение книги и перспектив истории современного искусства как научной дисциплины. |

|
<<Верно говорил
Олива, что в нынешней
системе искусства главный фигурант музей.
Всего несколько дней назад мы сообщали о
расширении Los Angeles County Museum.
И вот вдогонку информация
о реконструкции Seattle Art Museum. В марте
начинается освоение бюджета в 86 млн.
долларов, первой трети от планового
бюджета. До января 2006 года работы не
потребуют закрытия музея, но с января по
весну 2006 музей все-таки временно
закроют. <Архитекторы прельщают, в частности, вот такой картинкой будущего музея> |
|
<<Андрей
Ковалев Вытекающие
достоинства - РЖ, 19.03.2005 "...есть две новости. Одна плохая, другая - еще лучше. На тусовке в Академии государственной службы при президенте РФ собрался Координационный совет по культуре России. На ней, понятное дело, "Более полусотни посланцев-депутатов со всех концов страны вместе с чиновниками Минкульта решали, как уберечь Отечество и его культуру". А министр Соколов огласил печальную весть: "Если ранее на нужды культуры в 2005 году предполагалось выделить из федерального бюджета 3,4 млрд. рублей, то теперь эта сумма сократилась до 1,2 млрд. Остальные "культурные" средства придется добывать на местах" (Михаил Малыхин. "Вся власть совету", "Новые Известия" от 15.03.) "Гособвинитель Кира Гудим на процессе по делу о выставке "Осторожно, религия!" так и сказала "Контекстный характер современного искусства требовал от устроителей выставки учета сложившихся в России традиций, отношения к общественной роли искусства, как нам всем известно, "поэт в России, больше чем поэт"". Оглашение приговора назначено на 28 марта, посему в следующей "Искусственной жизни" придется разбираться с тем, что приговор будет значить для нас всех. Не только постмодернистов и деконструктивистов"> |
| <<Итальянец Renzo Puano, похоже, стал наиболее востребованным мухейным архитектором в Штатах. По его проету будет перестраиваться музей Whitney. Впереди большой лос-анжелесский заказ. На реконструкцию Los Angeles County Museum of Art (LACMA) уже собрано 156 млн. долларов, из которых 130 млн. пойдет только лишь на первую фазу реконструкции. С Нью-Йорком вышло сложнее. Landmarks Preservation Commissio на публичных слушаньях 15 марта отправила нынешний проект реконструкции Whitny на доработку - дабы в новой версии не требовалось ничего рушить вокруг музея> |

|
<<После шумного успеха "Ворот"
Кристо в Центральном
парке в Нью-Йорке, причем в первую
очередь успеха финансового, жители
Колорадо вспомнили о проекте Кристо 92 года,
предполагавшем декорирование более 6 миль
реки Арканзас. Кто-то уже подсчитал, что
если Кристо и Жан-Клод прямо завтра начнут
эксклюзивно работать над проектом "Над
рекой", то реализовать его можно не
раньше 2008 года. Подробнее> |
|
<<Эрик
Булатов - Русское
искусство противостоит глобализации - РЖ, 15
марта 2005 года. Русский Журнал: Как бы вы охарактеризовали современную ситуацию в российском искусстве? Эрик Булатов: Здешнюю ситуацию не надо отрывать от общечеловеческой, от того, что происходит в Европе и Америке. Те же процессы, что идут там, происходят и здесь. О них надо говорить и думать. Самое главное в них - американизация, которую можно считать синонимом глобализации. И выражается она в том, что искусство и бизнес сливаются в единое целое. РЖ: Что это означает конкретно? Э.Б.: Прежде художник должен был располагать минимальными условиями работы - холст, краски, помещение. Нередко где живет, там и работает. После завершения - выставка, продажа. Сейчас все устроено иначе. Художник прежде всего сам должен обеспечить себе финансовые возможности для того, чтобы делать большие проекты. Обеспечить деньги и пространство. Именно с этого художник должен начать. Сначала деньги. Таким образом, выстраивается обратная перспектива: художнику прежде всего сейчас нужны способности бизнесмена-менеджера, а во вторую очередь - просто одаренность. Но талант бизнесмена важнее, потому что удачный поиск спонсора сам по себе уже гарантирует успех. Дальше все срабатывает по цепочке. Тот, кто вложил средства, постарается их оправдать всеми правдами и неправдами. Он выжмет все возможное. Таким образом, получается, что успех заложен изначально, предопределен. РЖ: Но как это происходит на деле? Стихийно? Или как-то организованно, спланированно? Э.Б.: Например, в Америке, сейчас такие вещи "закладывают" еще на стадии обучения. Художник здесь в первую очередь антрепренер, управленец, а если ему понадобятся для осуществления проекта какие-то другие навыки, имеющие отношение к живописи, он наймет ремесленника. Это и есть глобализация, которая проявляется в полном слиянии бизнеса и искусства. РЖ: Соотносится ли то, что получается в результате таких действий, с обычным, "каноническим" поведением автора, когда он занимается только своим делом? Э.Б.: Возникает совершенно другое искусство. Странно, что для работ Мэтью Барни и моих существует одно и то же слово: "искусство". Мы ведь делаем абсолютно разные вещи. Новое искусство агрессивно и полностью отменяет традиционное. Эта агрессия многомерна и проявляется в политике музеев, прессы, управленцев, которые пытаются активно влиять на вкусы, спрос. Правда, мне бы не хотелось, чтоб мои высказывания воспринимались исключительно со знаком "минус". В этом новом искусстве есть немало интересных и сложных вещей. Пятисерийный цикл "Кремастер" того же Барни или восьмичасовая экранизация "Поминок по Финнегану" Джеймса Джойса, предпринятая художниками Микелем Квиумом и Кристианом Леммерцем, - это мультимедийные проекты с многоярусными системами аллегорий и метафор, в которых показ скульптур, инсталляций, рисунков является неотъемлемой частью. РЖ: Если все же вернуться к России... Э.Б.: Русская ситуация старается дублировать Запад. Но она более разорвана. Разброс проявляется в том, что по сей день сосуществуют несколько линий. До сих пор актуальна национальная линия левого МОСХа (Глазунов, Шилов, Церетели - за пределами, разумеется), опирающегося на сезанизм. С другой стороны, активно желание преуспеть на Западе, сделать карьеру там. Но тем не менее может выработаться позиция, которая сумеет противостоять этому натиску и противопоставить что-то реальное. РЖ: Тогда, наверное, вопрос в том, из чего наберется критическая масса? Как она возникнет? Э.Б.: Если русскому искусству суждено обрести конкретную реальную форму, оно должно включить и мосховскую линию как указатель на национальную потребность. Но именно как указатель... Потому что тут возникают большие сомнения: мосховский расплывчатый сезанизм с его невнятными перепевами вряд ли в состоянии даже поставить вопрос. Но это тем не менее симптом. Реальные фигуры в сегодняшнем контексте - Рогинский, Васильев, Инфантэ, Касаткин. Это люди моего поколения. Они близки мне. Конечно, не стоит относиться к этому списку как окончательному. РЖ: Как бы вы прокомментировали московскую биеннале в этой связи? Э.Б.: Я ехал в Москву в настроении довольно скептическом, так как знал, кто организатор. И действительно, неудач вышло много. В Музее Ленина получился полный провал, потому что кураторы вообще не поняли, с каким пространством имеют дело, не учли ни место, ни ситуацию вокруг него. И все материалы, представленные на выставке, были просто уничтожены. Кураторы, проигнорировавшие всю совокупность историко-культурных обстоятельств, просто подписали себе приговор о профнепригодности. Но другие центры достаточно интересны. Хороши выставки в Музее фотографии, выставка Рогинского в Центре современного искусства у Бажанова удачна. Кроме того, чувствуется, как пульсирует энергия в событиях, напрямую не связанных с биеннале. Сейчас в Москве есть ряд выставок, которые стоит смотреть: "Шагал" и "Бубновый валет" в Третьяковке, "От Джотто до Малевича" в Пушкинском. Но конкретно мало что нравится. Сейчас принято считать, что есть несколько столиц. где концентрируются основные процессы, происходящие в мировом искусстве, - Нью-Йорк, Лондон, Берлин. Москва и Париж - это города, где собираются провинциальные силы, которые, может быть, сумеют противостоять этому мейнстриму. РЖ: Не могли бы вы сказать несколько слов о тенденциях такого противостояния? В чем оно? Э.Б.: Внешне кажется, что происходят изменения к лучшему. Нет прежней растерянности. Ощущается почва под ногами, возможность работать. Точки кристаллизации - в общении с художниками. Русское искусство нуждается в зрителе, ориентировано на зрителя, включает его как соавтора, так как зритель должен пережить то, что переживает автор. Попадание внутрь другого пространства традиционно и обязательно для русского искусства. Тот же Кабаков именно с этим и работает, стараясь зрителя затащить в пространство инсталляций. Собственно, такой метод совпадает с тем, что делает Васильев. Но пока это отдельные художники, разрозненные, "штучные" явления. Необходимо объединение внутренних сил русского искусства. И тогда можно будет говорить о противостоянии глобализации> |
|
<<Андрей
Ковалев "Итожить
наработки" - РЖ, 14 марта> "Подозреваю, что эпические обозрения, посвященные биеннале, порядком поднадоели читателю; однако фантомные боли продолжаются. Несмотря на то что празднику искусств посвящено уже два обзора, третий придется начать с того же места"... "...я вместе с Фаиной Балаховской радуюсь, что "после потрясшей художественную Москву биеннале современное искусство вернулось на свое малобюджетное место. Как нас ни пугали, что центр творческой жизни переместится в российскую столицу и не всякий гражданин подобное выдержит, мир в очередной раз не перевернулся" ("Квартальный отчет", "Время новостей" от 02.03.). Но, самое главное, - биеннале показало, что у современного искусства появилась своя аудитория. Вдумчивый Боец Пупкин требует организовать в Музее Ленина нечто вроде "Тейт Модерн", "ибо нигде с момента посещения Тейт Модерн меня так не плющило! Экстраваганза, бэйби!" ("Тейт" на выезде", Kak от 23.02.). Если столь бравых бойцов начинает плющить и колбасить, победа будет за нами, наше дело правое. Можно отправляться на пенсию". Полностью> |
 <<Эта живописная серия "The Devastating Impact of Crack Cocaine" выполнена никем иным, как Дамиеном Хирстом. В нью-йоркской галерее Ларри Гагосьяна до 23 апреля первая выставка его живописных работ - "The Elusive Truth". Подробнее о выставке в АРТикуляции Дмитрия Барабанова. Нью-Йорк Таймс рассказывает о примечательной метаморфозе творчества 39-летнего Хирста. По словам Гагосьяна все 30 работ уже проданы: от 250000$ за небольшие и до 2 млн. $ за крупные холсты. Мастер формальдегида не считает себя живописцем. Зачем? В его студии работают 30 человек - есть кому красить. А вот аэрограф Хирст забраковал - "изображения получаются мертвыми". Параллельно выставке живописи на Park Avenue между 53-й и 54-й улицами установлена бронзовая скульптура Хирста "The Virgin Mother". Но и это еще не весь диапазон неугомонной звезды. После сверхуспешной распродажи сделанных им интерьеров лондонского кафе Pharmacy ($20 млн.), Хирст объявил о своих планах открытия двух ресторанов: рядом с лондонской галерей Гагосьяна и в парижском François Pinault Foundation for Contemporary Art, который откроется на Сене в 2007 году. |

|
<<вышел
мартовский 89-й номер журнала Frieze> |
|
<<"Первый
блин" - "Итоги". Слава богу, что Московская биеннале современного искусства состоялась, но теперь, после ее завершения, надо сделать работу над ошибками, считают эксперты. Закончилась первая Московская биеннале. Оправдала ли она надежды, которые на нее возлагались? Об этом на страницах "Итогов" рассуждают художественный руководитель Государственного центра современного искусства (ГЦСИ) Леонид Бажанов и куратор, главный редактор "Художественного журнала" Виктор Мизиано. В. Мизиано: Если бы я писал рецензию, то назвал бы ее "Первая московская биеннале как зеркало русских либеральных реформ". ...Еще один очень важный момент - антиинтеллектуальность. Не как принцип, а как незапланированный результат. Заявленная тема "Диалектика надежды" не получила развития на выставках. Не было конференции, дебатов, семинаров, которые обыкновенно сопровождают большие проекты. Л. Бажанов: В каком-то смысле модель, соответствующая здешней ситуации, была реализована. Но - вне основного проекта. Биеннале стала интересной благодаря усилиям местных кураторов. Их благосклонно в последнюю минуту включили в общую программу биеннале. На это не дали ни рубля. Проект "Сообщники", показанный в ГТГ, очень интересный. "Квартирные выставки" - хороший проект, просто он сделан поспешно. Интересно было смотреть проекты Свибловой в МКАИ, "Человеческий проект", подготовленный региональными филиалами ГЦСИ... Даже проект Starz в Московском музее современного искусства в Ермолаевском переулке, где, конечно, нужна была кураторская помощь, выглядел достойно. Специальные и параллельные проекты спасли биеннале. Как ни нелепо это звучит, они даже кураторам биеннале уже здесь, в ее рамках, открыли Россию. Слава богу, что биеннале состоялась. Дай бог, чтобы после ее завершения началась работа над ошибками. Но пока, насколько я знаю, организаторы всем довольны. Я предпочел бы, чтобы они учли недостатки. Успех создали не они, а окружение. Говоря об успехе, я имею в виду количество зрителей, радость профессионалов, художников. По жанру получилась скорее не биеннале - фестиваль> |
|
<<"Ренессанс или почвенничество?
Первые итоги биеннале" - Polit.ru. Антон Николаев
(псевдоним) Деидеологизация и гуманизация искусства вывела на передний план также художников, работающих в рамках смеховой культуры (“Синие носы”), и “новую серьезность”, манифестом которой служит выставка “Человеческий проект”. ... К современному искусству пятнадцатилетней давности была идеально применима <> философема Ортеги-и-Гассета. Неподготовленный зритель не мог получить эстетическое наслаждение от произведений, похожих на то, что сопутствует ему в повседневной жизни. Мы имели дело с крайней формой искусства ради искусства. Оно было направлено не на зрителя, а на культурный контекст, со стороны напоминая бормотуна, впавшего в солипсизм ложной рефлексии. Сформировавшееся в противодействии официальному советскому искусству, оно продолжалось “бороться с ним” и после падения советской власти. Будучи антитезисом советской власти, преддверьем синтеза, современному искусству нужно было избавиться от зашоренности, от очевидно избыточного превалирования концептуального над художественным, которое выразилось в формуле нахождения “фигуры критики внутри фигуры художественности”. Избавление от этих шор, очевидно, несет в себе благотворные синтетические возможности. Веселье “Синих носов”, новая серьезность “Человеческого проекта” - и есть цемент этого нового синтеза. Биографии звезд <участников проекта StarZ> – каркас, на котором может держаться эта конструкция и даже стать железобетонной. |
|
<<Последнее
слово Анны Альчук на суде по делу о выставке
«Осторожно, религия!» "...практически все выступавшие со стороны обвинения абсолютно далеки от современного художественного процесса и поэтому совершенно неправильно истолковывают работы. Там, где художники демонстрируют критическое отношение к обществу потребления, к рекламе, ставшей новой религией, они видят кощунственное отношение к символам православия"... "Данное дело показало, что людям, не приспособленным к этому обществу, легко внушить, что все их проблемы возникли благодаря некому Врагу с большой буквы. Теперь объектом травли стали художники, занимающиеся современным искусством и Сахаровский центр. В результате выставка, которую видело не более двадцати человек, помимо присутствовавших на вернисаже художников и критиков, стала, как принято говорить, «пустым означающим»; на нее оказалось возможным списать все страдания людей, никогда выставку не видевших и о современном искусстве услышавших впервые в жизни, все беды России, как это сделали деятели культуры и науки во главе с Никитой Михалковым, Ильей Глазуновым, Вячеславом Клыковым и другими. Остается только удивляться маловерию последних, написавших про выставку: «Это событие как бы бьет в набат. Оно должно стать последней каплей, переполнившей чашу народного терпения… Иначе – конец. Иначе – предательство России, Православия, Христа»"... "Все ссылки обвинения на прецеденты аналогичных процессов, якобы, имевшие место в развитых странах, не имеют под собой никаких оснований. Это первый политически мотивированный уголовный процесс, связанный с искусством, и в этом качестве он при любом исходе войдет в историю. Особенно после требования прокуратуры сжечь изъятые у участников выставки работы!"> |

|
<<Вышел мартовский
номер Artforum'а> <<Кстати - музеи на сайте Artforum. Картина крайне невеселая... Только Эрмитаж, Третьяковская галерея и Русский музей, почему-то приписанный к Москве :) Вот такая о нем информация: THE STATE RUSSIAN MUSEUM St.-Petersburg, Inzhenernaya str., 4 191011 Moscow +7 314 4153 http://www.rusmuseum.ru/eng Интересно, кто-нибудь в Русском музее знает о сайте Artforum?> |
|
<<"Перекошенные
лица молодых танцовщиц, дверные ручки для
одиноких дам, Тарковский как клипмейкер: в
Государственном центре современного
искусства открылась выставка «Рефлексия»". "Что из чего следует вычленить, чтобы оправдать заголовок? Не слишком ли тотально распространено это свойство, чтобы выделять одних его носителей и забывать про других? Даже самые архаические формы искусства можно считать образчиками не отсутствия рефлексии, а ее преодоления. Про contemporary art и говорить нечего. Пожалуй, именно здесь коренятся реальные причины его отрыва от массовой аудитории. Художники нередко полагают, что их рефлексии – сплошной эксклюзив, и преподносят продукты своей мыслительной деятельности в качестве прозрений."... "В сумме получается, выражаясь научно, очередной пример критики искусства средствами самого искусства. Все думают о том, как избавить публику от иллюзий, для чего изощряются в придумывании иллюзий все новых и новых. Это занятие становится ремеслом, не так уж часто сопровождаемым мучительными рефлексиями. А вы думали, вам тут глаза откроют?" - В. Мойс - Gazeta.ru> |

|
< <Швейцарский парламент в ходе десятидневных дебатов (!) осудил выставку в Швейцарском культурном центре Парижа (до 30 января), которая жестко критикует состояние демократии в Швейцарии и, по мнению многих депутатов, буквально атакует министра юстиции и полиции. Депутаты потребовали отставки директора Центра, пригласившего на выставку Томаса Хиршхорна, и урезали финансирование Центра. NYTimes - "Препарирование демократии". Хиршхорн, давний противник правых политиков, представил в Париже инсталляцию Swiss-Swiss Democracy и не скрывает своей неприязни к националистам типа министра Christoph Blocher> |
| <<Рекордное число посетителей британских музеев за прошедший 2004 год - более 6 миллионов. Guardian> |
|
<<Обзор
наиболее значительных событий в области
искусства за 2004 года (NYTimes, разумеется, в
США): - открытие реконструированного MoMA; - выставка Shomei Tomatsu в нью-йоркском Japan Society; - смерти Анри Картье-Брессона, Ричарда Аведона; - отмечены две выставки в галереях Челси: Giorgio Morandi в галерее Lucas Schoormans и Howard Hodgkin в галерее Gagosian и волна нового интереса к минимализму, выразившаяся в успешных выставках Дэна Флавина и Дональда Джадда> |

|
<<В Dartmouth College разработан метод
статистического анализа
отсканированных с высоким разрешением
произведений искусства. Уже есть весьма
любопытные результаты. Так, "Мадонна с
младенцем" Перуджино написана
четырьмя живописцами (?) NYTImes> |

|
<Археологи обнаружили, возможно,
древнейший образец лэнд-арта, кусок
песчаника с орнаментом, возраст
которого оценивается в 4000 лет. Подробнее> |
| <<Marla Prather, в недавнем прошлом возглавлявшая отдел послевоенного искусства в нью-йоркском музее Whitney и отдел искусства ХХ века в Национальной галерее Вашингтона, назначена куратором американского искусства музея Tate. Новый куратор останется в Нью-Йорке и оттуда будет заниматься пополнением коллекции Tate> |
| <<Похоже, что очередная попытка строительства филиала музея Гугенхайма, на сей раз на Тайване, потерпела неудачу> |
 |
Русское
издание журнала "Флэш
Арт". №1. 1989 год> <<"... Что-то несомненно изменилось в вас самих, привыкших до недавних времен концентрироваться только на искусстве..." Далее> |

|
<<61-м лауреатом
Золотой медали Американского института
архитектуры (AIA) стал Сантьяго Калатрава (Santiago
Calatrava). 11 февраля в Вашингтоне состоится
награждение. В последние годы Калатрава
безусловно построил впечатляющие
общественные сооружения, например
Олимпийский комплекс в Афинах. Он также
автор проекта транспортного узла на месте
WTC в Нью-Йорке. Подробнее> Слева - Оперный театр на Тенерифе> |
 <<Cтатья в artdaily> |
<<ARCO,
международная ярмарка современного
искусства пройдет в Мадриде 9 - 14 февраля 2005
года. 291 галерея из 35 стран, из которых
только 85 испанских. В сранении с 277
галереями - учасниками прошлой ярмарки -
небольшой рост и одновременно уменьшение
количества испанских галерей с 96 до 85. В
качестве страны - специального гостя на
этот раз предстанет Мексика. Еще одно
новшество предстоящей ярмарки - новое
пространство, Black Box, предназначенное для
аудиовизуальных, мультимедийных проектов и
сетевых проектов. Из Российских галерей участвуют новые московские RuArts (Africa (Sergey Africa Bugaev), Group Escape, Igor Vishnyakov в программе "Новые территории") и Stella Art Gallery (Olga Chernysheva, Eugenia Emets, Alexandra Galkina, Ilya Kabakov, Alex Katz, Diana Machulina, Alexandra Paperno, David Salle, Andy Warhol в основной программе и в программе "Новые территории" - Eugenia Emets, Alexandra Galkina, Diana Machulina)> |
|
<<Андрей
Ковалев "Рыбку
съесть" - РЖ. "...все понемногу возвращается к исходному, добиеннальному состоянию. Только теперь все проявляется в гораздо более обостренной и наглядной форме. Эстетические конфликты лишь скрывают реальную идеологическую борьбу. Вот, например, разумный в принципе молодой человек, делегированный редакцией популярной газеты на выставку художника-патриота вдруг заводится и заявляет следующее: "Работы Рыженко мало отличаются от глумливых карикатур на патриотизм художников-провокаторов, представленных на Московской биеннале. Академиков и авангардистов сегодня объединяет одно - у них потеряна связь с реалиями современной России". "Билеты в Третьяковку стоят всего в три раза меньше, чем в Лувр. Бюджет этих заведений различается в разы. А вот зарплаты парижского куратора и московского музейщика - на порядок. Вот тут и встает неприятный вопрос - куда исчезает разница?". Подробнее> |
|
<<"Диалектика разочарования" Екатерина Деготь, Время Новостей.
16 февраля. 1. Биеннале обязательно должна продолжаться, иначе сама ее идея -- вписать Россию в большой мир хотя бы в артистическом плане -- будет обесценена. 2. Это «вписывание в большой мир» должно носить характер и интеллектуального, а не только товарного обмена. Биеннале явно не хватило большой дискуссии о художественном и идеологическом наследии коммунизма, о либерализме и радикализме в искусстве глобального мира. 3. У биеннале должна быть компактная группа кураторов (или же один куратор с группой международных советников), которая будет располагать временем для работы с художниками. 4. На биеннале нужно приглашать как можно больше иностранных гостей, спрашивать их совета, устраивать с ними дискуссии, лекции и мастер-классы (а не только танцы), причем до потери сознания. 5. Для биеннале должна быть построена собственная площадка, но при этом она не должна монополизировать все художественные инициативы Москвы ни организационно, ни идейно, ни финансово. 6. В своем финансировании биеннале должна сочетать государственные деньги со спонсорскими (для сохранения независимости), и из тех же соображений она должна быть независима от московских галерей и других институций -- в надежде, что дружеские отношения можно удержать от системы блата. 7. Наконец, даже случайная публика не должна чувствовать себя на биеннале некомпетентной и ненужной; для этого существуют и комментарии на стенах, и экскурсии, но -- главным образом -- отношение к искусству как к части общества. А также к обществу России как к части мирового сообщества...> |
|
<<Polit.ru
опубликовал два текста Александра Шабурова.
Как всегда парадоксальных и по особенному
неполиткорректных. Эта шабуровская
особенность в том, что пишет он вроде резко,
но ведь практически никто на него за это не
обижается. Потому что в его ернических
парадоксах не очень спрятано желание
нравиться-таки всем. И в "Синих носах"
очевидно стремление, пусть несколько иными
средствами, но поспеть за Акуниным,
Марининой и другими, пользующимися
вниманием относительно массовой аудитории. "Меня более всего занимают помрачения рассудка, фетиши и жупелы близких мне культурных групп. Сетования моих старших товарищей понятны. Поэтому я заступаюсь за них перед младшими товарищами. Говорю: когда-то их деятельность тоже была значимой, они заслуживают уважения и имеют право заниматься теми формами, какими занимались в дни триумфов. Их последователи — полный отстой, а эти имеют право делать то, что привыкли, всю оставшуюся жизнь. Только не надо абсолютизировать свою возрастную драму." "... вольная или невольная экспозиционная метафора первой Московской биеннале — выкинули Музей Ленина на помойку и в его руинах выставили пригоршню мелкобуржуазных невнятностей — выглядит устарелой. Это было бы уместно в Перестройку. А сейчас интересней было, если бы участвующие в биеннале художники восстановили Музей Ленина в его стенах, любой другой жест кажется мне варварским и аморальным. Если же говорить более серьёзно, то целью Московской биеннале должна быть формулировка новой программы для отечественного современного искусства и популяризация соответствующих ей лучших мировых образцов. Видимо, до этого пока не дозрели"> |
|
<<"Глеб
Смирнов: Хочется, чтобы все немного унялись".
Время новостей. 16 февраля> Историк искусства, философ и литератор Глеб Смирнов без малого десять лет живет в Венеции. Кураторы, художники, комиссары российского павильона Венецианской биеннале, а также приезжающие на старейший в мире артфорум критики после официальных мероприятий по установившейся традиции стараются заглянуть на огонек в дом Глеба. В радушном приеме, хорошем вине, интересном разговоре можно быть уверенными. Сейчас «русский венецианец» приехал в Москву. Амплуа его изменилось. Из старожила Венеции он превратился в гостя российской столицы. О том, насколько Первая Московская биеннале конкурентоспособна с существующей сотню лет венецианской, с Глебом СМИРНОВЫМ беседует обозреватель «Времени новостей» Сергей ХАЧАТУРОВ. "...Россию на Западе не воспринимают так, как Тайвань или Танзанию. Это все-таки не экзотика, а скорее «свое», но только вторичное, провинциальное. Однако Запад по отношению к России пребывает в перманентном ожидании чего-то такого, что сравнимо по масштабам с «Толстоевским» или дягилевскими русскими сезонами. Поэтому даже когда мы «твердим зады» европейской культуры, это воспринимается снисходительно-благожелательно".> <<"Смычка классики и андеграунда. Кулика не трогать! Он теперь медалист" Марина ОВСОВА, Московский Комсомолец. 10 февраля> Беспрецедентное событие случилось в Академии художеств. Ее президент Зураб Церетели наградил медалью “Достойному” организаторов и некоторых заметных участников 1-й Московской биеннале современного искусства. Событие происходило в зале президиума академии на Пречистенке, где встретились две абсолютно разные группы, до сих пор никак не пересекавшиеся: представители старого, традиционного искусства и модные актуальщики. <<"Биеннальских наградили. За инсталляцию "Лев Толстой и куры" Олег Кулик получил от Зураба Церетели медаль "Достойному". Николай Молок, Известия. 11 февраля> Главную награду - золотую медаль Академии - вручили Михаилу Швыдкому, который в бытность свою министром культуры пообещал выделить на биеннале много денег, а став руководителем ФАКК свое обещание сдержал. Медали попроще, но с пафосным названием "Достойному" получили: Майя Кобахидзе (начальник управления современного искусства ФАКК), Евгений Зяблов (комиссар биеннале), Иосиф Бакштейн (куратор-координатор биеннале), кураторы Елена Селина, Ольга Лопухова, Ольга Свиблова, а также художники Владислав Мамышев-Монро, Владимир Дубосарский, Александр Виноградов, Олег Кулик и группа "АЕС+Ф", чья совместная выставка под не менее громким, чем медали, названием Starz проходит в подведомственном Зурабу Церетели Музее современного искусства. <<"Интеллектуальный кунштюк. Роберт Мэпплторп и классическая традиция" Роман Грецкий, Культура. 10 февраля. Странно, но посвятив большую часть сопроводительного текста рисунку, известному под названием "Рука Гольциуса", и сделав сравнение этой гравюры и фотографии Мэпплторпа "Картины. Автопортрет" отправной точкой в построении и развитии всей концепции, куратор не позаботился о том, чтобы саму гравюру, принадлежащую голландскому музею Тайлера, можно было увидеть на выставке. И это, пожалуй, одна из самых больших неудач проекта с точки зрения визуальной, экспозиционной. Помимо этого, много вопросов вызывает и развеска в отдельных залах Московского дома фотографии, ибо в ряде случаев гравюра ну никак не желает вступать в диалог с повешенной рядом фотографией и "разбивать привычные представления об истории искусства". Справедливости ради, стоит отметить, что в каталоге не только присутствует вышеупомянутая гравюра, но и вообще подбор иллюстраций более обширный и упорядоченный. Но это лишь отнимает очки у выставки, подчеркивая искусственный, "бумажный" характер проекта. Получается, что каталог лучше и полнее выставки, а значит, последняя не удалась, а кураторская идея осталась интеллектуальным кунштюком. <<"Звезды исследовали свою природу" Григорий Ревзин, Коммерсантъ-Daily (ссылка на сайт биеннале)> В общем, понятно, почему этих, самых успешных российских художников не стали активно привлекать к основным экспозициям биеннале - для молодой русской художественной революции, отчасти даже с претензией на небольшой пожар мировой, они слишком обуржуазились. <<"КОЛЛЕКТИВНЫЙ ГЛАЗУНОВ. Искусство постмодернистского салона" Михаил Сидлин, Независимая газета. 9 февраля. «Последнее восстание» – это новая «эпохалка» АЕС+Ф. Вместе слиты полуобнаженные подростки и военное снаряжение, «голубые города» будущего и костюмированное насилие. Визуальные клише компьютерных игр соединены с «академическими» постановками фигур в духе Семирадского (влияние недавней эпической выставки салонного искусства в Третьяковской галерее видно невооруженным глазом). Их новой работе мог бы позавидовать Илья Глазунов, потому что в «Последнем восстании» спаяны воедино актуальный сюжет и религиозные аллюзии, приемы исторической живописи и принцип коллажа. Всё, как у Глазунова, только вместо живописных фигур использованы фотографические, а вместо живописных интерьеров – «тридэшные». Единственное, что отличает пока этих художников от Глазунова, – самоирония, отсутствие веры в собственное высокое предназначение. Как-никак на дворе XXI век. ...единственным итогом нынешней биеннале можно считать утверждение статус-кво середины девяностых: Олег Кулик, Владимир Дубоссарский, Владислав Монро и группа АЕС+Ф (все они представлены на выставке в Московском музее современного искусства) стали поп-фигурами. За что боролись – на то и напоролись. Теперь уже эти художники проходят не по разряду «актуального», а по части «селебритиз», то есть знаменитостей. <<"Черные вдовы" современного искусства. " Deutsche Welle" 9 февраля. Политическое искусство представлено здесь под лозунгом "Остановись, надежда" и отображает события, начиная с 1975 года. <<"Возрождение недовольства" Нора Фицджералд, The Financial Times. 9 февраля. Биение пульса фестиваля ощущается скорее на выставке российского 'протестного' искусства - сегодня оно энергично возрождается. Первое поколение художников, выросших в атмосфере свободы, и через 20 лет после начала перестройки ведет себя по-диссидентски. В экспозиции альтернативного искусства 'Россия-2', помимо автобусной остановки Кулика, представлено ошеломляющее утопическое полотно чеченского художника Алексея Калимы, изображающее Грозный в 2069 г., и инсталляция Гоши Острецова 'Сонное правительство' - чиновники в черных резиновых масках, дремлющие, или рисующие каракули в блокнотах. <<Все публикации> |
|
<<Никита
Алексеев - "Поездка в Коломну" (РЖ): "...жалко, что в "Золотую книгу" не включена "Иерархия аэромонаха Сергия. Перевод обсосов Военного ведомства МАНИ (Московского архива нового искусства) на положение резидентуры", составленная в 1986 Андреем Монастырским и Владимиром Сорокиным. Этот провиденциальный документ многое объясняет в подрывной деятельности московских концептуалистов, отчасти повинных в том, что "Россия-2" сейчас угрожает ГБ РФ. Приведу некоторые цитаты. "Маршал Илья Кабаков. Переводится на Краснопрудную 8. Кличка: Топор. Задание: тайный советник в пределах Московской области. С указанием". С Краснопрудной маршал Кабаков, впрочем, скоро перевелся в Нью-Йорк и начал рубить оттуда, указаний не слушая. "Генерал армии Андрей Монастырский. Переводится в Реутово-8. Кличка: Обсос. Задание: тайный попечитель ВДНХ и Московского метрополитена". Что у нас с ВДНХ происходит - видите сами. Сплошные ларьки. А метро? Одна реклама, и скоро пенсионеров перестанут пускать в это подземелье. "Генерал армии Владимир Сорокин. Переводится в Яму. Кличка: Расклин. Задание: тайный наблюдатель околоземных наблюдений со спуском 40". Сорокин расклинился до того, что его богомерзкие сочинения идут вразрез с Достоевским. Наверно, потому что у него спуск с таким масонским градусом. "Генерал армии Никита Алексеев. Переводится в Эльзас-Лотарингию. Кличка: Часы. Задание: женские дела". Я на самом деле вскорости оказался во Франции, где, видимо, прошел стажировку в секретной школе, где готовят Бондов. "Генерал-майор Иосиф Бакштейн. Переводится в Лось-А. Кличка: Шнырь. Задание: низовое распределение платного жидовства с подъемом". Ныне Бакштейн - главный куратор Московской биеннале. Во как, Иисусе, спаси! Подъем - мощнейший... "...на выставке в Коломне <"Что вы наделали, коломенцы?" > можно было увидеть много не менее, а может, и более интересного, чем на основных биеннальных площадках. По-моему, это один из самых умных проектов Биеннале. ...от наделанного коломенцами впору удавиться не только изготовителям концептуальных мощей, помещенных в реликварий "Золотой книги", но и создателям изумительного течения в итальянском искусстве, называвшегося Arte povera ("Бедное искусство"), возникшего в 1960-е годы"> |
|
<<"Воскрешение отцов. Выставка Кристиана Болтанского — лучший иностранный проект Московской биеннале современного искусств". Федор РОМЕР, Время Новостей 7 февраля. ...изощренно играя на чувствах зрителя, Болтанский, как всякий современный художник (а он все-таки является таковым), боится лишнего пафоса. И на первом этаже флигеля под лестницей, ведущей к инсталляции из пальто, колышутся на стене тени от бумажных силуэтов комичных чертиков, скелетов, черепов и прочей детской безобидной нечисти. Эта игрушечная прелюдия переводит метафизические эксперименты этажом выше в разряд безнадежной утопии — даже искусство никогда не вернет бабушку с дедушкой. Воскрешения отцов никогда не будет. Призраки Одессы всего лишь ничтожные химеры сознания. <<«У него на картине — судьба табуретки». Татьяна Невская,
"Газета". 7 февраля. <<"Швыдкой зашел в метро". МАРИЯ МИКЕЛИ, Профиль.
6 февраля. Для интересующихся светской
составляющей биеннале. |

|
<<5
февраля NYTimes отозвалась о Московской
биеннале. Сдержанная позитивная публикация.
Помимо основного проекта внимания
удостоены только квартирные выставки и
гельмановская Россия2. Возможно, это
единственная позитивная публикация о
России за довольно длительное время. Так
что уже одним этим биеннале себя оправдала. "Emphasizing Creativity, Not Collectivity". Steven Lee Myers, New-York Times. 5 February. (для чтения NYTimes требуется однократная регистрация) Перевод - ИноСМИ. <Даниель Бирнбаум, Роза Мартинес, Яра Бубнова, Николя Буррио, Ханс-Ульрих Обрист и Иосиф Бакштейн> |
|
Девиз биеннале — ’Диалектика надежды’, а основной принцип — далекий от разрешения художественный конфликт между Россией и ее советским прошлым. Это напряжение отражает даже выбор музея Ленина для проведения выставки. ...Результаты, как и у большинства подобных событий, неоднозначны, но локальный эффект несомненен. ’Думаю, самое важное — это то, что биеннале существует’, — говорит Софи Шмит (Sophie Schmit), куратор проекта ’Призраки Одессы’ Кристиана Болтански (Christian Boltanski), французского художника, населившего государственный музей архитектуры. ... соглашение об использовании музея Ленина, предмет продолжительных споров между федеральным и городским правительством, было достигнуто только 7 декабря. ’Можете себе представить? — сказал в интервью Иосиф Бакштейн, заместитель директора Государственного музейно-выставочного центра Росизо и координатор шести кураторов биеннале. — У нас было меньше месяца на подготовку всех инсталляций’. ...Биеннале организована российским министерством культуры, которое и выбрало итальянское название, чтобы подчеркнуть вдохновение от Венеции. Оно же выделило 1,5 млн. долларов для бюджета выставки, в общей сложности составившего 4,3 млн. долларов. Часть денег поступила от города и часть от корпоративных, в основном иностранных, спонсоров. ...Девиз биеннале — ’Диалектика надежды’, а основной принцип — далекий от разрешения художественный конфликт между Россией и ее советским прошлым. Это напряжение отражает даже выбор музея Ленина для проведения выставки. ’Мы понимаем, что это место символично, — сказал на открытии Даниэль Бирнбаум (Daniel Brinbaum)...> <<Все публикации> |
|
<<"Фабрика
кадров" (Выставка молодых российских художников «No
comments?»). Вера Щербина, ArtToday. 5 февраля>
<<"Дольше!
Глыбже! Ширше!" Андрей
Ковалев. РЖ, 5 февраля. |
|
<<"Обнуление"
- Андрей Ковалев, "Время
новостей", 3 февраля. "...в шикарном зрелище московскому зрителю было отказано категорически". "И что самое замечательное, эта новая пристойность возникла вовсе не по велению тугодумных московских бюрократов, но как корпоративный проект группы международных кураторов. Людей, известных своей способностью четко и ясно формулировать мысли. Именно они и заявили нам, что эпоха больших дискурсов закончилась, Дерридой уж не прикроешься. Производство новых смыслов в промышленных масштабах, которым занималась мировая худобщественность последние три десятилетия, стало у нас на глазах каким-то дурным тоном." "Одно только печалует - как-то все слишком просто получается. Без всякого шума художники сочли за благо отказаться от вековой борьбы за лучшее будущее человечества. И вплотную заняться приусадебным хозяйством. Хорошо ли это или плохо - вот над чем следует подумать."> <<Никита Алексеев в РЖ Как Ленина домой не пускали - 2 февраля: <после похвал Болтанскому, Ровнер и Мудову, об основном проекте> "Не верю! Это больше всего похоже на курсовой просмотр студентов Суриковского института при советской власти, это столь же бессмысленно и скучно, только сделано при помощи других технологий и при других обстоятельствах". "После открытия выставки выяснилось, что человека в кепке и с бородкой на самом деле пригласили, наняли, он один из ингредиентов инсталляции московско-сибирской группы "Синие носы", хоть отчасти спасающей "Диалектику надежды" от абсолютной безнадежности"> |
|
<<"Новая
серьезность". Егор Одинцов, Максим Гуреев,
«Культура». 3 февраля. Честно говоря, намерение провести экспозицию «Диалектика надежды», представляющую собой основную программу Первой московской биеннале современного искусства в бывшем Музее Ленина, вызывает некоторое недоумение. В том смысле, что уж слишком неизобретательной представляется концепция, поверхностным ход мысли (если она вообще была), и чрезмерно брутально-прямолинейно выглядят намеки. ... в заброшенных и полутемных залах зритель, не находя некоего смыслообразующего приема, хода происходящего, сам по мере своих скромных возможностей начинает моделировать пространство. Например, на автора этих строк неизгладимое впечатление произвела вмурованная в стену медная, до блеска начищенная табличка, на которой было написано следующее: «Кадиевский машзавод. Эскалаторы изготовлены для Центрального музея Ленина коллективом завода коммунистического труда в честь 100-летия со дня рождения В. И. Ленина. Луганская обл., 1969 год». Пожалуй, более знакового экспоната для выставки с пафосным названием «Диалектика надежды» придумать уже невозможно. Если учесть, что юбилейные эскалаторы, разумеется, не работают. Соответственно, при таком подходе к делу совершенно непонятно, зачем вообще посещать данную экспозицию. Вполне достаточно просто подойти к бывшему музею, перед которым зияет огороженная рекламными щитами якобы строительная площадка несуществующей гостиницы «Москва», на ступенях которого по-прежнему разместились продавцы национал-большевистской литературы, а за углом которого «не зарастает народная тропа» в Мавзолей и одновременно в Иверскую часовню. Вот куда более хитроумные инсталляции, и при этом не требующие ни музейных смотрителей, ни милиционеров, ни металлоискателя на входе. |
|
<<"Хроника нехороших квартир. История квартирных выставок в музейном центре РГГУ и на одиннадцати площадках Москвы".
Игорь Чувилин, Газета.ру. 3 февраля. <<"Продлись, мгновенье. Видеоинсталляция Билла Виолы в ГМИИ имени Пушкина". Фаина Балаховская, «Время новостей» 2 февраля. Проект Билла Виолы — украшение Московской биеннале. Современное искусство редко предстает в таком виде: изящный замысел, классически совершенные формы и мощнейшее воздействие на зрителя. <<"Сон в подсобке. «Приветствие» Билла Виолы в ГМИИ имени Пушкина". Григорий Ъ-Ревзин, «Коммерсантъ» 2 февраля (ссылка на стр. сайта биеннале). «Приветствие» Билла Виолы выставлено в маленьком зале на задах греческого дворика музея — там раньше была подсобка, а последние несколько лет Ирина Александровна Антонова пускает туда современное искусство. Там установлен очень хороший экран, прямо домашний кинотеатр, и на нем десять минут показывают произведение Билла. Сняты три женщины (актрисы Бонни Снайдер, Сюзен Петерс и Анжела Блэк). Сначала Бонни и Сюзен стоят и разговаривают между собой. А потом к ним подходит Анжела, причем с Бонни она знакома, а Сюзен не знает. Ну и она подходит, обнимается с Бонни, здоровается, а Сюзен вроде ни при чем. А потом Бонни, видимо, говорит: «Анжела, это Сюзен», Сюзен оживляется, Анжела тоже, они здороваются. Все. ...<представители организаторов биеннале> начали говорить что-то такое чрезвычайно заискивающее. Что вот, как показывает опыт, иногда, в некоторых своих вершинах современное искусство в каком-то смысле может подойти к тем шедеврам, которые хранятся в классических музеях, и мы бесконечно благодарны Ирине Антоновой за то, что она предоставила нам возможность войти в этот музей. И что эта выставка — настоящая кульминация биеннале... <<Человеческое, просто человеческое. «Человеческий проект». Максим Шульц, Arttoday.ru 2 февраля> <<"Всем давали вешаться. «Газета». 2 февраля. Очередным спецпроектом биеннале стала программа, посвященная квартирным выставкам 1956-2005 годов. По городу разбросаны двенадцать экспозиций этой программы; одна из них открылась в Музейном центре РГГУ и рассказывает о «квартирниках», проходивших с 1956 по 1979 год. С куратором проекта Юлией Лебедевой беседовал Игорь Чувилин. |

<<День спустя после нашей АРТикуляции №31 с Дмитрием Барабановым появились первые оценочные публикации: <<"Мэрилин Монро замахнулась на Клеопатру". Николай Молок, «Известия». 31 января. Случилось то, чего много кто ожидал, но во что мало кто верил: на время биеннале Москва стала-таки мировой столицей современного искусства. К нам приехали десятки художников, представители крупнейших западных галерей, директора ведущих мировых ярмарок — парижской FIAC и Art-Basel (последняя представлена советом директоров в полном составе), музейщики, арт-критики и журналисты. По словам одного из редакторов знаменитого английского журнала Frieze, Москва благодаря биеннале стала местом, где нужно быть. От этого наплыва гостей выиграют в первую очередь наши художники и, конечно, наши галеристы, неожиданно получившие новые выходы в арт-свет. <<"На диалектику надежда. Первые впечатления от Первой биеннале Москвы". Сергей Хачатуров, «Время Новостей». 31 января. "...основная выставка биеннале не самая удачная по составу и презентации. Главная, на мой взгляд, проблема экспозиции молодых художников в бывшем Музее Ленина — она недостаточно аттрактивна, чтобы быть понятной широкому кругу любителей искусства, выполнять просветительскую функцию. По жанру это очень драйвовый, очень тонизирующий workshop для заинтересованных профессионалов. Что из увиденного понравилось особенно? Мне, например, объект аргентинца Томаса Сарацено «Соединенное небо». Воздушный шарик с картой Земли крутится под потолком на воздушной подушке. К нему прикреплена камера. То, что она снимает (случайный вихрь архитектурных деталей, лица зрителей, пляшущие абстрактные линии и пятна), сродни сновидению, галлюцинации, жутко реальной (все с тобой и сейчас) и жутко призрачной. Преодоление границ обыденности, собственно, и есть территория искусства. Из видео запомнилась выбранная куратором Розой Мартинес работа испанки Пилар Альбаррасин «Вива, Испания!». Там элегантная художница в модном костюме с модной сумкой и в модных очках ходит по улицам Мадрида, а ее везде преследуют музыканты уличного оркестра. Такой навязанный массовыми, национальными, гендерными стереотипами помимо воли человека праздник разоблачает репрессивный механизм социальной жизни. Наглядно и убедительно. Из российских художников очень понравилась инсталляция Ирины Кориной с огромными, обшитыми дешевым офисным пластиком геометрическими объемами, сложенными наподобие архитектурной модели деконструктивиста школы Фрэнка Гери. Мимикрия элитарного (постконцептуального) в банальное на сенсорном даже уровне позволяет почувствовать подвижную, прозрачную, опять же диалектическую экзистенцию этих понятий". "Ответом главной площадке форума оказалась великолепно и чисто сделанная выставка «Человеческий проект». Ее кураторы — региональные руководители филиалов нашего Центра современного искусства". <<Все публикации> |
|
<<Вчера 1-го февраля я давал информацию
об иске к участникам выставки "Россия2".
Сегодня на Gif.ru
появилась информация, уточняющая, что "Среди людей, против которых подан иск, представляющий обвинение адвокат Михаил Воронин назвал имя не только галериста и политтехнолога Марата Гельмана, но и руководителя Федерального агентства по культуре и кинематографии Михаила Швыдкого. "Вся выставка задумана как провокация тяжелобольных людей. Авангардное искусство должно иметь место, но когда это искусство выдается в форме своих маниакальных внутренних проблем, это не искусство, а патология, достойная Института Сербского, а не ЦДХ"". И "По просьбе "Ъ" господин Воронин заглянул в каталог "России-2" и проанализировал способы, которыми покусились некоторые участники выставки на святое. В числе вызывающих возмущение экспонатов господин Воронин назвал работу группы "Синие носы" "Гори, гори моя свеча" ("Используется святой образ непосредственно Христа в виде эпатажа") и "Мадонну с младенцем" Олега Кулика ("Кощунственный образ, видимо, беременной шахидки на фоне развалившегося памятника"). "Или еще вот есть "Блуждающая пуля" – композиция из трех человек, которые с обнаженными членами мочатся на пленника!" – добавил юрист. На вопрос о том, каким же образом здесь осквернена (и вообще задействована) христианская символика, господин Воронин негодующе ответил, что "речь идет о дискредитации государства и президента в целом"> <<В Московской Патриархии считают, что устроители выставки "Россия-2" пытаются добиться славы путем поругания христианских святынь> |
| <<По словам Любови Сапрыкиной, один из главных проектов, представляющих нашу страну на следующей Венецианской биеннале, подготовят нижегородцы - Галина Мызникова и Сергей Проворов, известные как группа «Провмыза». Ребята показывали свои неожиданные, эпатирующие картины видео-арта почти во всех странах Европы, о чем «КП»-НН» писала неоднократно. Всего на Венецианской биеннале России разрешено представить два проекта - второй будет принадлежать московским художникам из группы Escape. Пока только известно, что проекты будут интерпретировать тему религии. Полностью текст здесь> |

|
<<По мнению неких православных людей,
посетивших выставку "Россия2", работа
Гора Чахала оскорбляет чувства верующих... И
работа Марины Колдобской. Поначалу я эту
информацию Интерфакса воспринял за некий
пиар-ход. Как-никак куратор-организатор
выставки Марат Гельман знатный пиаровец, к
тому же с редким для галериста хобби -
политикой. Но встретившись с ним, узнал. что
все серьезно. И Андрей
Ковалев уже подобрал материалы по этому
зарождающемуся "делу". Советую оскорбленным людям заглянуть на сайт Гора Чахала. Картинки посмотреть, тексты почитать. Если и в этом случае им не покажется, что Гор самый что ни на есть апологет христианства, то это уже клиника. И никакие суды в таких ситуациях не помогут. В иные инстанции надобно обращаться. А работа Марины Колдобской подсказывает вам иной оскорбительный объект. Посмотрите, сколь многие верующие после долгой службы практически без перерыва принимаются за телевизионную жвачку... Ю П> |
|
<<"Михаль Ровнер: Московская биеннале стала для меня стихийным бедствием". Сергей Хачатуров, «Время новостей».
27 января 2005. "Михаль Ровнер — хрупкая женщина, управляющая Вселенной. На Венецианской биеннале 2003 года павильон Израиля с ее инсталляцией «За порядок? Против порядка?» многими экспертами был признан лучшим. На всех стенах павильона показывали видео из тысячи людских фигурок, вовлеченных в некое ритуальное шествие или танец. Они то собирались группами, то вытягивались в цепочки, которые распадались, чтобы в другом месте собраться вновь. Цепочки человечков напоминали молекулы ДНК, или ноты в партитуре, или броуновское движение атомов. На столах стояли микроскопы, в которых «вирус» человечества можно было рассмотреть сквозь линзы. Ровнеровская лаборатория и восхищала, и пугала одновременно. Мы оказывались хоть и вместе, но в каком-то экзистенциальном одиночестве — маленькие, беззащитные, рассыпавшиеся по бескрайнему вселенскому пространству, ни от чего не застрахованные. 15 мая 2005 года в Иерусалиме будет открыт памятник Михаль Ровнер, посвященный жертвам холокоста."
... "— Работы, привезенные в Москву, связаны с Венецианской инсталляцией?
— Московская биеннале стала для меня стихийным бедствием. За сверхкороткое время мне пришлось сделать две работы. Эти работы действительно очень похожи на те, что были на биеннале. В то же время — другое пространство, другой масштаб. В одной видеоинсталляции людские фигурки группируются в странные хороводы или маршируют колоннами. В другой я покажу подобие «чашек Петри» — колбочки, в которых человеческие массы выращиваются наподобие клеточных стенок."...
"— Считаете ли вы себя вовлеченной в индустрию современного искусства?
— Нет, мне ближе роль «иеремита», отшельника. Я очень занята своей работой. Я не презираю современное искусство, не отрицаю его. Но мой диалог с ним — своеобразный. Меня можно сравнить с подводной лодкой. Долгое время плаваю в глубоких водах, в своих образах и темах, в один прекрасный момент всплываю на поверхность. Еду на биеннале, например.
— Кто из мастеров XX века повлиял на ваше творчество?
— Малевич. Знаете, как правило, случается так: иду на какую-нибудь колоссальную выставку, например в Музей Гуггенхайма. Там тыщи работ. И если среди них есть пусть даже крошечная работа Малевича, то она отнимает все внимание на себя." <<"Проекция на камни. Михаль Ровнер задает вечные вопросы с помощью новых технологий". Ольга Кабанова, «Ведомости». 27 января 2005. "Михаль Ровнер давно числилась в списке первых израильских художников, но мировая известность пришла к ней два года назад, после Венецианской биеннале, где ее работа «Остановившееся время» была отмечена среди лучших. Стены израильского павильона были покрыты проекцией движущейся людской толпы, а в залах стояли огромные столы, на которых в лабораторных чашках, через микроскоп, можно было разглядеть хороводы движущихся людей, среди них была сама художница и ее друзья. Ровнер выставлялась в британской Тейт-галерее, в нью-йоркском Музее Уитни. Она занималась балетом, изучала философию, начала художественную карьеру фотографом, для ее видеоинсталляций писал музыку Филип Гласс." <далее интервью. — У вас есть привязанности в новом и старом искусстве? — Меня многое вдохновляет, но сейчас главное — Египет. На своей последней выставке в Нью-Йорке я сделала тексты на камнях, это было похоже на иероглифы, текст состоял из фигурок людей. Но я не сидела над этой работой годы, не долбила камни, а сделала на них проекцию, и еще эти люди-иероглифы у меня двигались. И что же здесь нового, что поменялось с египетских времен?> <<"Вынесли Ленина". Сергей Соловьев, «Новые Известия». 27 января 2005. Роза Мартинес: «Когда мне предложили сделать главный проект в Москве, я ни на минуту не сомневалась, что буду участвовать, — делилась арт-знаменитость с „Новыми Известиями“. — Новые проекты — это новые возможности. И Москва в этом плане — настоящий магнит. Пора уже избавиться от доминант старых центров — от главенства Нью-Йорка, Парижа или Венеции. Я знала, что в Москву надо везти молодых и перспективных художников со всего мира. Тогда это будет прорыв». <<www.e-flux.com дал рассылку о Московской биеннале. Странновато, что только 26-го января, но лучше поздно, чем никогда> <<"Живая колбаса, обвившая Кремль, поруганная Мона Лиза и другие аттракционы превратили фестиваль Art Digital в неожиданно приятное развлечение" - Gazeta.ru> |
|
<<"Будем как дети. В галерее «Айдан» показывают работы Ростана Тавасиева". Фаина Балаховская, «Время Новостей».
26 января 2005. |
|
<<"Ленинские норы". Мария Микели, журнал «Профиль», Москва.
24 января 2005. |
|
<<Николя Буррио: " |
|
<<Любовь Сапрыкина: "Наш
проект оказался роялем в кустах"/
Ирина Кулик. "Коммерсантъ".
24.01.2005.
<<Андрей
Ковалев - Политическая
смерть искусственного (РЖ) 21.01.2005. |
|
<<У нас накаляются
предбиеннальные страсти, а CTHEORY
Артура и Марилуиз Крокер публикует
очередную теоретическую работу, на сей
раз Nicholas Rombes, утверждающего, что в
условиях тотальной дигитализации и
виртуализации реализм становится
авангардом. "Avant-Garde
Realism". Помимо
качества самого текста приятно отметить
возрастание цитируемости нашего
бывшего соотечественника Льва
Мановича. Rombes
ссылается на его "From
DV Realism to a Universal Recording Machine". |
|
19 января 2005. Сергей Хачатуров. Коллективное «доколе?» - Время новостей. Руководитель Федерального агентства по культуре и кинематографии Михаил Швыдкой решил делать свою «Культурную революцию» в формате реалити-шоу и только для випов российского искусства. В понедельник состоялся первый выпуск, посвященный готовящейся Московской биеннале. Сказав вступительное слово, Михаил Ефимович уступил права ведущего куратору-координатору биеннале, директору Института современного искусства Иосифу Бакштейну. В кинозале федерального агентства известных, прослывших новаторами в своей профессии людей собралось действительно много. Театральный продюсер Эдуард Бояков, хореограф Алексей Ратманский, дирижер Александр Ведерников, музыкант Татьяна Гринденко, композитор Владимир Мартынов, художница Айдан Салахова, театральный режиссер Кирилл Серебренников, социолог Даниил Дондурей, писатели Дмитрий А. Пригов, Виктор Ерофеев, кинорежиссер Иван Дыховичный, директор Московского Дома фотографии Ольга Свиблова… Вот далеко не полный перечень участников первого ток-шоу. Пригласили и обозревателей нескольких московских газет. Идея встречи: консолидация творческих людей в поиске территории современного искусства. Той территории, на которой диалог разных видов творчества был бы конструктивным и имел мощный общественный резонанс. Устроенная Михаилом Швыдким встреча почему-то называлась «круглый стол». Выглядел «стол» так: все, включая самого Швыдкого, сидят в креслах кинозала, а на сцене перед экраном — ведущий вечера Бакштейн. Он сам дает и отбирает слово, единственный задает вопросы и приглашает выступающих пройти на сцену к симпатичной деревянной трибуне. Диспозиция вышла, мягко говоря, совсем не демократическая. По иконографии что-то среднее между заседанием партийного съезда и все тем же телевизионным ток-шоу. Другой, принципиальный, на мой взгляд, минус в подготовке встречи — невнятно и рыхло сформулированная задача и цель саммита. Каждый из приглашенных мэтров театра, кино, художественной жизни — сам себе режиссер, человек медийный, привыкший говорить на публику и украшать свою речь правильными, но очень общими и элементарными по сути риторическими фигурами. У каждого из выступавших своя авторская редакция любимого русской интеллигенцией причитания «доколе?». Чтобы этот безответный по определению вопрос не докучал собравшимся на протяжении двух с половиной часов, желательно было бы конкретизировать тему и о территории современного искусства говорить не вообще, а в частности — применительно к тем институциям, которые за эту территорию отвечают. В такой формулировке многое бы конкретизировалось для самих выступавших. Ведь большинство из них (Бояков, Дондурей, Пригов, Свиблова) сетовали как раз на то, что в коммуникации по поводу современного искусства профессиональным сообществом, как и обществом в целом, не выработаны правила игры, отсутствует контекст, конвенциональность — то, что, по словам Даниила Дондурея, «обеспечивает уважение до понимания». Чтобы в обществе появилось «уважение до понимания» contemporary art необходимо приравнять к высшей математике. Но такое может случиться только в том случае, если в стране будут нормально действовать институции с нормальным бюджетом, нормальной программой, обеспечивающие нормальный процесс адаптации contemporary art массовым сознанием, а также нормальный процесс интертекстуального, мультимедийного обмена между отдельными жанрами и видами творчества. Вот об институциональности и можно было бы поговорить, тем более что в одной только Москве находятся несколько институтов, занимающихся проблемами «контемпоральности». А трудности у этих институтов общие, хотя бы потому, что ни один из них пока не перестает быть герметичной эзотерической ячейкой; диалог с российским обществом, пожалуй, лучше всего удается вообще не москвичам, а нижегородскому филиалу Центра современного искусства (почему-то именно его директор Анна Гор так и не получила слово у ведущего «круглого стола» Иосифа Бакштейна). Проблема институций неизбежно актуализирует и другие обозначившиеся в ходе встречи больные вопросы. Прежде всего — вопрос об образовании. Айдан Салахова спросила Михаила Швыдкого наотмашь: «Я преподаю живопись в Суриковском институте. Там до сих пор учат по системе полувековой давности. Готовят не современных художников, а создателей панно на тему „Мир. Труд. Май“ в детских садах и общественных столовых. Когда реформа художественного образования наконец-то начнется?» Ответа пока нет. Образование, в свою очередь, тащит ниточку еще одной проблемы — из года в год уменьшается число адекватных зрителей (слушателей-читателей) произведения современного искусства, организованного по принципу интеллектуального приключения и требующего поэтому далеко не среднего культурного уровня и напряженной работы мысли, сотворчества. Сужение круга единомышленников — следствие того же самого: диалог с искусством вообще и современным в частности не является прерогативой государственной политики, он случаен и маргинален. И снова речь о необходимости институций, тех, что действуют по принципу vincit dum vincit — «побеждает пока связывает». Их эффективный менеджмент, бюджетная структура — отличные темы для конкретного обсуждения с госчиновниками. Есть надежда, что такой разговор впереди. Нам обещано, что «круглые столы» с Михаилом Швыдким будут регулярны. Это радует, ведь когда все друг друга узнают лучше, высокопарной риторике делать будет нечего и коллективное «доколе?» уйдет восвояси. Сергей ХАЧАТУРОВ |
|
<<Андрей Ковалев, "Политические
абстракции и абстрактная политика",
РЖ: |
|
<<Престижную премию, присуждаемую историкам искусства, по итогам 2004 года получили куратор J. Paul Getty Museum Thomas Kren и Scot McKendrick из British Library за работу "Illuminating the Renaissance: The Triumph of Flemish". Подробнее. Авторов у изданной в мае 2003 года книги больше. За 56 долларов можно купить здесь. Рецензия в Гардиан "Cеверный свет". А с одноименной выставкой, состоявшейся 17 июня - 1 сентября 2003 года, можно познакомиться здесь> |
|
<<Обзор состояния лондонского арт рынка. За 30 тысяч фунтов на одной и той же Бонд Стрит можно купить старинный пейзаж или работу современного художника. Структура "класса покупателей" изменилась - теперь это в основном игроки финансового рынка и деятели медиа бизнеса. Среднестатистический английский покупатель также существенно помолодел. Подробнее - Telegraph> |
|
<<Андрей
Ковалев "Не
приехал!" |
|
<<Дурной пример
заразителен. Вслед за англичанами
наши газетчики провели опрос арт-критиков,
галеристов, художников дабы выявить
наиболее влиятельные произведения
российского искусства ХХ века. Хотя
справедливости ради надо отметить, что "наиболее
влиятельные произведения" это формулировка
англичан. "Новые известинцы"
сменили ее на "шедевры". И вот, что получили: 1. «Черный квадрат» Казимира Малевича. 1915 год (100% опрошенных отдали ему 1 место). 2. «Рабочий и колхозница» (скульптура) Веры Мухиной. 1937 год. 3. «Башня Третьего Интернационала» (проект) Владимира Татлина. 1920 год. 4. Альбомы Ильи Кабакова. 1970 год. 5. Перфоманс «Человек-собака» Олега Кулика. 1994 год. |
|
<<Андрей
Ковалев - "Радикалы
за спасение капстроя" "Понятно, зачем Дойчебанк собирает дойчекунст. Он не великую культуру пропагандирует - для этого есть Гете-институт. Немецкие финансисты, как водится, решают сложные внутрироссийские проблемы: помогают "Газпрому" купить немножко "ЮКОСа". В такой важный момент лучше всего, если люди не будут считать деньги в чужих карманах, а задумаются о глубинах германского кунстволлена. Нашим до подобного размаха далеко; вот когда будет планироваться покупка компании Mersedes, тогда и будет смысл открывать банковскую выставку русского искусства в Дюссельдорфе" "банкиры протащили в обитель высокого предметы откровенно подрывные; например, там "нашлось место для произведений левака Йорга Иммендорфа, одно из которых посвящено памяти Мао Цзэдуна, а другое представляет собой эскиз инсталляции-"красного уголка" с алым знаменем" (Ирина Кулик, "Бесценные бумаги", "Коммерсантъ" от 17.11.). Это правильно: единственная функция банковского капитала применительно к искусству состоит в массовой закупке всех и всяческих революционеров в целях сохранения капиталистической системы как таковой"> |
| <<Чарльз Саатчи предложил свою коллекцию из 2500 работ YBA, оцененную в $380 млн. музею Tate Modern, но его предложение не встретило понимания> |
| <<30 ноября - 1 декабря прошли крупнейшие торги русским искусством в Лондоне. Сотбис (1 декабря) и Кристи (30 ноября) выставили в общей сложности около 1000 лотов. |

|
<Иван
Айвазовский (1817-1900), "Исаакиевский
собор в морозный день". Эстимейт 1- 1.5
млн. фунтов. Продана
за 1.125 млн фунтов (здесь же все рузультаты
аукциона Кристи)> На Сотбис за 588 тыс.
фунтов продана "Женщина в высокой
шляпе" Бориса Григорьева (эстимейт 175 -
200 тысяч), "Рыночный день в Нижнем Н."
Верещагина - за 488 тыс., ну и Айвазовский
конечно и здесь в чемпионах - при
эстимейте до 500 тысяч одно из его
караблекрушений ушло за 744 тысячи фунтов.
Все
результаты Сотбис за 1.12.2004> <"Более 90% покупателей составляли новые русские из Москвы" - утверждает эксперт Сотбис Джоанна Викери> |
|
<Лондонская
Telegraph живописует
нашествие мехов и бриллиантов на Бонд
стритт. Среди сверх богатых
коллекционеров, чьи представители
ожидались
на торгах, газета называет лужковскую
жену Елену Батурину. Кроме того ожидался и порученец Путина. Дабы
приобрести "для Кремля" портрет
Николая Первого. <РБК: "Открытый рынок русского искусства существует всего лишь 10-15 лет, поэтому окончательные цены на нем и в России, и за рубежом еще не успели сформироваться. По этой причине сегодня многие склонны считать русское искусство неплохим объектом для долгосрочного инвестирования." |
| <<Похоже, все-таки французы решатся расширить экспозиционные пространства Лувра в относительно бедный регион - Guardian> |
|
<<Амстердамский музей
современного искусства Stedelijk
по угрозой лишиться 14 работ Малевича.
Юридическая зацепка наследников
состоит в том, что человек, продававший
эти работы музею, не имел прав на их
продажу - ART
NEWS online> Попутно - Stedelijk одним из первых музеев обратился к видео арту. До 16 января музей совместно с фестивалем IDFA представляет программу ParaDocs. "Герой" Марины Абрамович - не только в программе, но и первой иллюстрацией на соответствующей странице сайта> |
 |
<<Интервью Чарльза Саатчи - ArtNewsPaper> |
| <<10-летие домена RU было отпраздновано в попсовом формате в Экспоцентре. Все правильно и закономерно, о чем свидетельствует единственный наш представитель на этом шабаше, Константин Преображенский> |
| Уважаемый музей, нацеленный на новое искусство New Museum for Contemporary Art уже изменил свое решение переместиться в Челси - слишком много крупных галерей конкурируют друг с другом в стремлении выглядеть как музеи современного искусства. Дилеры Челси сами считают, что в этом крупнейшем мировом центре современного искусства господствует дилерский драйв ("dealer-driven Chelsea"), тогда как в Сохо 90-х - артистический драйв ("artist-driven SoHo"). Подробнее - полоса в NYTimes> |

|
<<Джерри
Зальц об открытии
реконструированного МоМА.
Вертолет над лестницей второго этажа> <<Newsweek: "Новая МоМА - кафедра ценностей Синих Штатов". В Красных Штатах - церкви, в Синих - музеи современного искусства. И главное, что там увидишь - считает David N. Berkwitz - это секс, смерть, тоска, страдание, боль + хорошее меню в кафе> |

|
| <<Городской совет калифорнийского городка Carmel-by-the-Sea принял решение воспрепятствовать открытию новых галерей. На сегодня их 120, и это при том, что жителей в городке всего 4058 человек. Городок стал жертвой собственного успеха - дом с тремя спальнями даже по калифорнийским меркам стоит запредельно дорого, 2 млн. долларов. Вот ведь до чего доводит искусство :)>> |

|
<<22
ноября в Нью-Йорке состоялась пресс-конференция,
на которой были анонсированы детали проекта
Кристо и Жан-Клод "The
Gates, Central Park, New York City, 1979-2005". 12
- 27 февраля Центральный парк украсит
инсталляция из 7500 ворот. Уникальность проектов этой пары заключается не только в грандиозности упаковок и инсталляций, но и в том, что они никогда не прибегают к спонсорской помощи, а финансируются самими художниками через специально созданную корпорацию C.V.J. Corp, которая торгует эскизами, рисунками и коллажами, литографиями и тому подобными работами, предшествующими и сопутствующими большому проекту. <<NYTimes - 23 мили дорожек Центрального парка на 2 недели превратятся в инсталляцию Кристо> |
|
<<"...на севере штата Нью-Йорк недавно проклюнулось юное дарование именно в сфере живописи. Некая Марла Ольмстед. Ее картины на недавно прошедшей выставке продавались по цене от 6 до 15 тысяч долларов. А ей
всего 4 года... сенсация. Вкруг ее полотен уже возник ажиотаж и сдается, что ее учебе – она посещает начальные классы школы, соответствующие русским детсадам, - живопись может даже повредить, так как писать она пока что практически не умеет и подписывает свои шедевры коряво, ставя центральную R задом наперед. Искусствоведы воспринимают опыты Марлы с болезненным скепсисом. Еще бы – четырехлетний ребенок, ставший в один ряд с Поллоком и Горким (а Марла пишет исключительно абстрактные картины) ставит под сомнение много философских доктрин о природе абстрактного творчества, подсознания и исторической рефлексии. Марла не философ, она не рассчитывает на революцию в искусстве и не подражает абстрактным экспрессионистам. Просто малюет пальчиками – ей нравится розовая краска и бобы в томатном соусе. Они приятны на ощупь, если не на вкус. Пытались проверить – не смогут ли создать нечто подобное ее сверстники. Опыт показал – не смогли. Впрочем, мы не можем судить о результатах опыта по сообщениям в печати. Те, кому опусы Марлы кажутся глубокими и оригинальными, возможно, просто не способны оценить шедевров ее одноклассников. Или само сходство с образцами живописи 20 века и ее работами внушает такой священный трепет – трудно сказать. Кое-кто из ее поклонников говорит даже, что и взгляд у нее какой-то необычный и глубокий. Ее немногословие напоминает сдержанность в высказываниях Пикассо. Ее спросили – трудно ли ей писать картины. Она ответила – что было шоком для окружающих –«Да, но я их делаю»" - Александр Раппопорт> |

|
<<Персонал Национальной галереи в Вашингтоне заболевает. Любопытна причина - светящиеся суммарной мощностью 48600 ватт 44 объекта минималиста Дэна Флавина, составившие ретроспективную выставку, которая продлится до 9 января> |
|
<<Chine
Economic Net - о короткой китайской истории
кураторства как професcии> <<Independent - спец. корр. из Пекина пишет о китайском "арт буме"; именно не об экспортной экспансии, которая тоже имеет место, но о том, что разбогатевшие китайцы, обзаведясь часами с бриллиантами, перешли к искусству> |
| <<20 ноября открывается новое здание МоМА, и Гардиан предупреждает команду Tate Modern, что им предстоит побороться за сохранение позиции мирового лидера, определяющего тренды современного искусства, которую Tate захватил после чрезвычайно успешного открытия нового здания. Теперь ход MoMA> |

|
<<Открытие реконструированного
нью-йоркского МоМА
состоялось 20 ноября, в день 75-летия музея. 630000 тысяч кв. футов на 6 этажах, 3200 работ составляют, возможно, лучшую коллекцию искусства ХХ века. 15 ноября - превью, для которого выбрана работа Дональда Джада.
|

|
<<"Чудо
на 54-й улице" - Guardian, 21 ноября>
<<NYTimes - о предстоящем событии и о потраченных 858 миллионах> <<Алексей Раппопорт на сайте ГЦСИ> <<Artopia - блог> |

|
<<И artnet
дает свою оценку современным
тенденциям арт сцены. "Больше нет
развития искусства - есть развитие рынка"... В качестве одной из иллюстраций фигурирует фотография Терри Ричардсона из недавнего проекта в Deitch Project> |
|
<<Cайт artfacts.net опубликовал результаты экспертных оценок выставочной деятельности 100 известных художников. Впечатляющий прогресс отметчен у Маурицио Каттелана и Билла Виолы> |
|
<<Обзор наиболее интересных выставок, предстоящих в Лондоне в 2005 году> |
<<Андрей
Ковалев подвел
некоторые итоги 2004 года в своей "Искусственной
жизни".
И завершил итоги совершенно верным
решением: "изменить формат "Искусственной
жизни", свести к минимуму обзор
статусно-официальных событий, о которых
преимущественно пишут достойнейшие
коллеги. И отдать свои силы оповещению
читателей "РЖ" о собственно
событиях в собственно искусстве -
примерно так, как это делает
Дмитрий Барабанов на
"Артинфо""> |
|
<<Реакция на кражу "Крика" " Эдварда Мунка - Oslo Munch Museum закрыт на 3 недели для монтажа новой системы наблюдения> |
|
<<1 cентября - миллионный посетитель на сверхуспешной выставке "MoMA in Berlin" в Берлинской национальной галерее. Открывшаяся 20 февраля по сугубо прагматическим соображениям - куда ж было девать коллекцию МоМА не помещающуюся во временное пристанище в Куинсе? - эта выставка превзошла все мыслимые ожидания организаторов. Не смотря на то, что многие европейские специалисты расценили ее как репрезентацию американского культурного колониализма. Уж очень она специфически представляет искусство ХХ века...> |

|
<<"Flash
Art" N 237. |
|
<<22-летняя Карен МакФерсон получила премию Mazda Emerging Artist Award в $10000. Премия разыгрывалась среди учащихся новозеландских художественных колледжей> |
|
<<"Дэн Браун прекрасно уяснил себе, что читатель любит умные книги, но никак не желает чувствовать себя дураком. Поэтому вся интеллектуальная нагрузка в «Коде да Винчи» не выходит за пределы малого джентльменского набора школьного хорошиста". "Брауну нельзя отказать в смелости: он утверждает, что вся известная нам история Иисуса Христа – выдумка, сляпанная церковниками, а на самом деле все было совсем по-другому. После этого истерия вокруг книги стала неизбежной, а судьба и самого автора, и фильма, снимаемого сейчас на «Коламбиа Пикчерс», предрешена" - Об очередном супербестселлере "Код Да Винчи" Дэна Брауна. "...про фильм, который делает команда, снявшая оскароносные «Игры разума» (режиссер Рон Хоуард, сценарист Акива Голдсман, продюсер Брайан Грейзер), с «гладиатором» Расселом Кроу в главной роли, церковники уже отозвались вполне определенно: «Если вы думали, что «Последнее искушение Христа» было взрывом, то «Код да Винчи» – это настоящая термоядерная бомба». В следующем году, когда выйдет картина, шумиха вокруг «Страстей Господних» Мела Гибсона покажется куртуазной беседой"> |
|
<<На
Волхонке открылась галерея
популярного художника Ильи Глазунова.
Давняя любовь москвичей к его
творчеству в советские времена
выражалась в километровой очереди к
Манежу, теперь - в размахе не спонсорских,
но городских затрат, которые, к примеру,
в 10 раз превышают вклад Российского
минкульта в организацию 1-й
Московской биеннале современного
искусства. Московский бюджет потратил
298 млн рублей на обустройство
персональной галереи Ильи Глазунова.
Эта сумма, указанная в отчете Контрольно-счетной
палаты (№2420/1-44), в шесть раз превышает
первоначально запланированную и
утвержденную Мосгордумой стоимость
работ. В ноябре 1999 года на реконструкцию бывшего Дома науки и техники на Волхонке, 13, переданного для галереи Глазунова, было выделено 50 млн рублей, работы планировалось завершить в июле 2000 года. С тех пор проект подорожал: увеличилось число этажей, выросла общая площадь здания. Государственная картинная галерея Ильи Глазунова передается в непосредственное ведение правительства Москвы. Теперь два любимца москвичей, Шилов и Глазунов совсем рядом друг с другом и с Кремлем. Ю П. <"Улица Волхонка в центре столицы превращается в музейную ось: через три года здесь выстроятся в ряд как минимум десяток выставочных залов и центров. Отталкивая друг друга локтями, директора будущих музеев отвоевывают территории. Не так давно все с замиранием сердца следили за схваткой Ирины Антоновой (директор Пушкинского музея) с Александром Шиловым (директор собственной галереи). Расширяясь в глубь квартала, Шилов угрожал административным корпусам Государственного музея изобразительных искусств (ГМИИ): он даже положил рядом трубы. А Пушкинский музей захватил ближайшие дома и усадьбы в Знаменском переулке, надеясь, что через пять лет превратит его в музейный квартал; для этого, правда, потребуется выселить Институт философии и еще сотню офисов. Напротив Пушкинского <Волхонка, 12> уже сверкает лазоревым светом Галерея Ильи Глазунова <Волхонка, 13>, которую покинули строители и окружили стаи вороных джипов" - "Новые Известия" <"...все залы музея оказались выдержаны в стиле новорусского ампира на манер Большого Кремлевского дворца, отреставрированного Глазуновым"... "Глазунов дополняет скудность живописных ракурсов разнообразием отсылок на масскультуру (его последние картины - настоящие коктейли поп-арта со святыми и правителями)"> <"В зале портретов чувствую - что-то меня тревожит. И тут понимаю - все лица в основном с голубыми глазами. И только Антихрист с карими. Огорченно потупляю свой карий взгляд. "Что вы, - смущенно улыбается экскурсовод, - Илья Сергеевич ведь гений и историю имеет право трактовать по-своему" - "МН"> <"Любая произнесенная им языком живописи или просто русским языком мысль оказывается... беспринципным, безобразным монстром-оборотнем. Он защищает христианские ценности и при этом требует вернуть смертную казнь. Он борется за чистоту классической школы, при этом живописует так небрежно-приблизительно-условно, что даже отпетый авангардист вступился бы за поруганный в лице Глазунова реализм" - С.Хачатуров, "Время новостей"> <"Улица Волхонка в центре столицы превращается в музейную ось: через три года здесь выстроятся в ряд как минимум десяток выставочных залов и центров. Отталкивая друг друга локтями, директора будущих музеев отвоевывают территории. Не так давно все с замиранием сердца следили за схваткой Ирины Антоновой (директор Пушкинского музея) с Александром Шиловым (директор собственной галереи). Расширяясь в глубь квартала, Шилов угрожал административным корпусам Государственного музея изобразительных искусств (ГМИИ): он даже положил рядом трубы. А Пушкинский музей захватил ближайшие дома и усадьбы в Знаменском переулке, надеясь, что через пять лет превратит его в музейный квартал; для этого, правда, потребуется выселить Институт философии и еще сотню офисов. Напротив Пушкинского <Волхонка, 12> уже сверкает лазоревым светом Галерея Ильи Глазунова <Волхонка, 13>, которую покинули строители и окружили стаи вороных джипов" - "Новые Известия" <"...все залы музея оказались выдержаны в стиле новорусского ампира на манер Большого Кремлевского дворца, отреставрированного Глазуновым"... "Глазунов дополняет скудность живописных ракурсов разнообразием отсылок на масскультуру (его последние картины - настоящие коктейли поп-арта со святыми и правителями)"> <"В зале портретов чувствую - что-то меня тревожит. И тут понимаю - все лица в основном с голубыми глазами. И только Антихрист с карими. Огорченно потупляю свой карий взгляд. "Что вы, - смущенно улыбается экскурсовод, - Илья Сергеевич ведь гений и историю имеет право трактовать по-своему" - "МН"> <Андрей Ковалев подытожил публикации по поводу открытия музея - "РЖ"> |
|
<<Французское правительство намерено построить "второй лувр" на севере Франции, в одной из обделенных провинций. Многие эксперты считают это решение "любительским и абсурдным, рожденным исключительно политкорректностью"> |
|
<<Что же в конечном счете интересует посетителей галерей? С мая по июль в канадскую Beaverbrook Art Gallery пришло рекордное количество гостей, более 11 тысяч! Причем такой наплыв последовал после придания огласке дискуссии между руководством галереи и Фондом United Kingdom Beaverbrook, предъявившим свои права на произведения искусства стоимостью в миллионы долларов, которые, как считают галеристы, принадлежат галерее> |
|
<<NYTimes о выставке радикального политического искусства Латинской Америки "Inverted Utopias" в Museum of Fine Arts, Houston. От агитпроп-плакатов до абстрактной живописи из 9 стран: Аргентины, Бразилии, Чили, Колумбии, Кубы, Мексики, Пуэрто-Рико, Уругвая и Венесуэллы - все подчинено поискам ответов на вопрос, как изменить, а то и разрушить привычный взгляд на Латинскую Америку> |
| <<В очередной раз музейное искусство выбрасывается уборщиком вместе с мусором, не маркированным как произведение искусства. В лондонском Tate уборщица приняла часть инсталляции Воссоздание первой публичной декларации саморазрушающегося искусства» немецкого художника Gustav Metzger на выставке "Искусство 60-х. Это было завтра" за "настоящий мусор" и прихватила его в измельчитель. "Уборщица делала свою работу, увидела мешок с мусором - она не виновата" - заявил представитель Tate> |

|
<<"Крик" Эдварда Мунка украден
во второй раз. Нагло, среди бела дня из
музея в Осло. В первый раз грабители
требовали выкуп. Что будет на сей раз,
пока не ясно. Хотя то, что картина
появится в чьей-либо коллекции,
маловероятно. Одна из икон модернизма,
пророчество гения, в 1893 году "увидевшего"
грядущий ХХ век, или галлюцинация
неумеренно пьющего художника... - BBC,
NYTimes> CМИ публикуют изображения разных версий "Крика", которых у Мунка было 4. На сайте Музея - та, что справа> |

|
| <<"Мертвый сезон - дело хорошее. Правда, газетно-журнальному народу приходится сильно париться. У меня даже был проект вывести специального такого художника У.Е.Тютькина-Августовского. Чтобы каждый из коллег очертил свой идеал. Сначала Константин Агунович в "Афише" сочинит прочувствованное превью. Юрий Арпишкин, со свойственным ему историческим оптимизмом, за неделю до вернисажа на целую полосу в "МН" обстоятельно опишет выставку. В день вернисажа выйдет восторженная, но предельно объективная и продуманная рецензия Ирины Кулик в "Коммерсанте". Потом Сергей Хачатуров во "Времени новостей" серьезно разберет историко-культурные предпосылки творчества Тютькина-Августовского. И даже Николай Молок выберет малый промежуток в с своем напряженном графике освещения международных форумов и отметит, насколько важно творчество Тютькина в государственном масштабе. Сергей Сафонов в газете "Газета" пропишет о том, как необходимо сохранять лучшие живописные традиции. А затем и Федор Ромер (или Александр Панов) в журнале "Еженедельный журнал" сбацает мимолетный и кристально ясный анализ того места в художественной ситуации, которое занимает наш августовский Тютькин. Не останется в стороне и Михаил Сидлин, недели через две он найдет время поговорить с этим молодым, но подающим надежды мастером, внимательно опишет работы. А там и Ковалев пропишет в "РЖ" что-то такое важное, но маловразумительное. Августовский будет потом Ковалева долго спрашивать: "А что ты, брат, хотел этим сказать? Ты меня похвалил или поругал?" Дело дойдет и до гламурных изданиев - и Августовскому придется ответить Василисе Соловьевой на сложные и замысловатые вопросы о своих кулинарных пристрастиях и любимом фитнес-клубе. В результате всего и высокохудожественный "Художественный журнал" отметит, насколько точно и правильно Августовский владеет международным дискурсом" - А.Ковалев. "А они как ломанули...", РЖ> |
| <<Для Лондонской Королевской Академии искусств этот год ужасен. Как долго приобретаются институциональные репутации и как быстро тают. Раскол в руководстве Академии и последовавшие за этим обвинения в неуправляемости нанесли по ее репутации серьезный удар. Дошло до обсуждения положения дел в NYTimes> |
| <<Holland Cotter анализирует историю и нынешние особенности искусства афро-американцев в статье "Черное обретает множество оттенков". Она утверждает, что современные чернокожие американские художники не чувствуют себя обязанными ссылаться на расовую или этническую историю> |

|
<<"Традиция и актуальность" Анатолий Осмоловский.
"Артхроника",
N2, 2004. Актуальность в искусстве в последнее время стала очевидной ценностью. Под актуальностью, конечно, понимается не политическая или культурная злободневность в стиле агитпропа, а наиболее точное соответствие духу времени. В этом смысле актуальное искусство - это единственно возможное в данный момент искусство и всякие разговоры о плюрализме (мирном сосуществовании) в нынешней "постмодернистской" художественной ситуации можно оставить досужим болтунам. Никакого плюрализма нет (и, к слову сказать, никогда не было), а было и есть несколько конкурирующих между собой моделей искусства. Наличие этих конкурирующих моделей - фактор абсолютно благотворный просто потому, что в искусстве (как и в политике) безальтернативная гегемония одной партии приводит к коррупции и деградации. Однако реальная власть всегда сконцентрирована где-то в одном месте. Актуальность - одно из популярных определений этого места. В то же время если злободневность не является точным описанием нынешней актуальности, то где находится эта жар-птица искусства сейчас? Как рождается актуальная проблематика? Зависит ли она от волюнтаристского усилия харизматического лидера или является общей конвенцией художественного сообщества?> |

|
<<"Билл Виола под академическим микроскопом" - так обозреватель artnet.com назвал 224-страничную книгу, только что вышедшую в издательстве Thames and Hudson. Редактор - лектор Университета Лондона, специалист по медиа арту Крис Таунсенд. Среди авторов профессор философии Хьюстонского университета Синтия Фриленд> |

|
<<Родной Торонто, точнее представители галереи Онтарио (AGO) не в восторге от проекта реконструкции, предложенного земляком, суперзвездой архитектуры Фрэнком Гери> |
| <<Cкоро, предположительно в 2006 году, появится новый "большой" журнал об искусстве. Пока есть только главный редактор James Truman, слоган "Превратим потребителя в знатока" и авторитет издательской группы Сondé Nast Publications. NYTimes особо отмечает именно этот факт. Об этом же - ArtNet 12 августа> |

|
<<Английский художник-партизан Банкси (Banksy) во вторник 3 августа нелегально (?) установил на Clerkenwell Green шестиметровую статую "богини юстиции", являющую под поднятым подолом облачение уличной проститутки. "Банкси-партизанщина" в три с половиной тонны качественной бронзы, включая работу, тянет на 22 тысячи фунтов. Место выбрано не случайно. Здесь Банкси был последний раз арестован. Послужной список его последних партизанских вылазок таков. В апреле он ухитрился на несколько часов выставить мертвых крыс в солнцезащитных очках в Natural History Museum, пока их не заметили служащие. 6 месяце назад исподтишка вывесил свою "картину" в галерее Tate. Еще раньше он изображал в непотребном виде Ее величество и писал спреем "Mind the crap" на ступенях Tate Britain перед церемонией Turner Prize. Последовательный партизан> |

|
<<NYTimes уже сейчас сетует на то, что нет никакой ясности, кто из американских художников будет представлять США на следующей Венецианской биеннале. Распущен Комитет, в чьи обязанности входит выбор кандидатов на участие в престижнейшем мировом фестивале искусства. Два финансовых партнера Госдепартамента, ответственного за представление страны в международных выставках и фестивалях, Pew Charitable Trusts и the Rockefeller Foundation, поддерживавших участие США в Венецианской биеннале в течение 17 лет, еще в декабре отказались от дальнейшей поддержки. Базовый бюджет каждой из экспозиций США в Венеции составляет около 1 млн. долларов, из которых государство и два фонда давали 350000. Остальные добывались музеями и художниками у корпоративных спонсоров. После отказа фондов Годепартамент обратился в Музей Гугенхайм, который владеет американским павильоном, с предложением организовать американскую экспозицию 2005 года. Однако зам. директора Лиза Деннисон ответила фактическим отказом. Директор Walker Art Center Kathy Halbreich предложила оставить павильон пустым и позволить желающим проецировать собственные изображения на его стены. Она считает сложившуюся ситуацию трагической уж сейчас. Цена вопроса 800000 долларов, так как Госдепартамент дает 170000> |
| <<Глава второго по объему выручки в мире рекламного холдинга WPP Group Мартин Соррелл предрекает печатным изданиям трудные времена. Об этом CEO второго по объему выручки в мире рекламного холдинга WPP Group сэр Мартин Соррелл заявил в интервью британской газете Independent, что вскоре печатным газетам и журналам придется столкнуться с острой конкуренцией за деньги рекламодателей со стороны онлайновой прессы> |
| <<Директор лондонского Института современного искусства Филлип Додд считает, что XXI век будет определяться Китаем и Индией, и что он не видит понимания этого факта на современной британской арт сцене. "Последние 10 лет мы провели в самолюбовании, в ощущении себя центром мира". Financial Times за 27 июля> |
| <<Обрело конкретные очертания давно назревшее решение о спасительном перемещении "Моны Лизы" Леонардо из Луврского зала в специальную галерею, в которой по мнению экспертов, удастся приостановить процесс ее разрушения. Спецгалерея стоимостью 2.3 миллиона Евро будет оборудована на деньги японской корпорации Nippon TV - The Art Newspaper 07/26/04> |
|
<<"Лет пятнадцать тому
назад в стремительно разваливающимся
Советском Союзе люди с придыханием
смотрели на Запад. Им казалось, что
социализм безвозвратно уходит в прошлое,
окончательно капитулируя перед "старым
добрым" капитализмом. Но история, как
всегда, посмеялась над поспешными
суждениями. Теперь выясняется, что
современный капитализм, победив советскую
альтернативу, перерождается в нечто иное.
Впрочем, для вдумчивых исследователей того
же Запада, ничего неожиданного не произошло.
Они уже давно ждали появление нового
общества, которое называли
постиндустриальным или информационным.
Можно выдвинуть версию, что оно не способно
быть ничем иным, кроме того, что Николай
Бердяев называл новым феодализмом. Подобно
тому как в недрах феодализма вызревал
капиталистический уклад, так и сегодня
внутри капитализма зреет уклад
неофеодальный" ... "Мануэль Кастельс говорит о возникновении "реальной виртуальности" - системы, в которой "сама реальность (то есть материальное символическое существование людей) всецело захватывается, полностью погружается в обстановку виртуальных образов, в мир воображаемого, в котором изображение не просто возникает на экране, через который передается опыт, а само становится опытом". "Новый класс" исходит из того, что субъект познания бесконечно превосходит его объект. Субъективный образ более реален, чем объективная реальность. Владея образом, можно полностью подчинить себе объект, с которого этот образ "срисован". Причем обладатель образа установит над объектом власть еще более сильную, чем обладатель самого объекта. Ведь последний находится в непосредственной близости от самого объекта, захватывается им, зависит от него, превращает его в фетиш. Но между владельцем образа и объектом существует некий "буфер" - образ. Он делает виртуального "собственника" независимым от объекта. Он - мощное оружие подчинения действительности" - "Весна средневековья", А.Елисеев, "РЖ", 26 июля> |

|
<<Братья Чэпмены приняли решение воссоздать свой "Ад", сгоревший вместе с другими работами из коллекции Саатчи на лондонском складе. Работа над инсталляцией заняла у братьев 2 года, но они уверены в возможности повтора. NYTimes, 22 июля> |
| <<В Сан-Франциско достаточно много современного искусства на улицах. Гигантский символ мира Тони Лабата или гигантская "ступня" Бастера Симпсона вызывают множество публичных протестов. Не без этого. Но каков позитив! Уже более 10 лет в городе 2 процента от КАЖДОГО строительного проекта отчисляется в специальный фонд публичного искусства. Как результат, на эти деньги создано уже 57 работ, включая уникальные временные инсталляции таких художников как Билл Виола и Кейт Харинг. Инициатор Фонда Стенли Гатти прозван "арт царем Сан-Франциско"> |
|
<<"Русское искусство 2004: групповой портрет"
- "Артхроника", N1, 2004. Русский артбум. Подъем артрынка, музейные и галерейные выставки. Сотни. По всему миру - от Японии до США. Всякие - от икон до актуального искусства. Русское искусство наконец-то предстало как единая - и очень большая - художественная школа. "АртХроника" публикует свой рейтинг русских художников. В него вошли те, кто был наиболее активен в прошлом году. Скорее всего, они же будут представлять русское искусство в 2004 году.> |

|
<<Есть художник, взявший на вооружение телефонные фотокамеры. Reichhold сделал огромные, до 90 метров длинной фотоинсталляции на лондонских Tower Bridge и Hungerford Bridge. BBC> |
|
<<CNN
- о процессе над профессором и художником,
лидером Critical Art
Ensemble (CAE) Стивеном Курцем и его коллегами,
обвиняющимися в био-терроризме (?!). Судя по
всему, обвинения в терроризме отпадут, но
неясен вопрос о легальности "генетического
искусства", которым занимаются
радикальные художники CAE> <<В работах CAE используются генетические манипуляции с живыми организмами> |

|
<<Стив Курц, 46 лет, профессор университета Баффало, с адвокатом> |

|
<<Одной из первых икон феминизма, Фриде Кало посвещен материал BBC. В связи с 50-летием со дня смерти. Кало безуспешно пыталась добиться признания равного с лучшими мексиканскими художниками Риверой, Ороско и Сикейросом. Но сейчас ее популярность и интерес к ее творчеству заметно превзошел всех троих, вместе взятых> |

|
<<CTHEORY - 14 июля - статья Кэрол Хамильтон "Джордж Буш как президентский симулякр". Одна из главных претензий Хамильтон к медиа комментаторам заключается в том, что они всерьез и позитивно комментируют высказывания Буша о свободе, демократии и "оси зла", как если бы он действительно владел политической философией и понимал государственную политику> |
| <<По мнению арт дилеров серьезной проблемой становится обилие фальшаков среди русской живописи, продающейся в Европе. Даже на аукционах Сотбис. Гардиан> |

|
<<Почитайте, как Майкл Киммельман пишет о нынешнем состоянии крупнейших нью-йоркских музеев, в том числе музеев современного искусства. "Уитни становится сталинским политбюро" - это еще не самый жесткий вывод. Досталось и Гугенхайму с его филиалом в Лас-Вегасе (с Эрмитажем, кстати) и стремящегося к гигантизму МоМА. Общий диагноз Киммельмана - кризис идентичности, переживаемый крупнейшими музеями. Кто-нибудь у нас в состоянии написать так о московских музеях? Есть ли у нас СМИ такого уровня авторитета и ответственности?> |
|
<<Московская биеннале
современного искусства откроется 18 января 2005 года. Тема
биеннале «Диалектика
надежды». Кураторы: Иосиф
Бакштейн, Николя Буррио, Даниэль
Бирнбаум, Яра Бубнова и Роза Мартинес.
Подробности в интервью Иосифа Бакштейна
газете «Известия»,
точнее Николаю Молоку, не только
журналисту "Известий", но и главному
редактору журнала "Артхроника". |
| <<SFMoMA перестраивает постоянную экспозицию. По словам куратора Madeleine Grynsztejn, побудительным мотивом является неприемлемость деления искусства на модернизм и постмодернизм. Текст в San Francisco Gate подробно объясняет особенности построения новой экспозиции старой коллекции> |

|
<<Один из наиболее влиятельных художников, 72-летний Герхард Рихтер вернулся к военной теме, впечатляюще реализованной им в проекте 88 года о немецкой террористической группе Baader-Meinhof. Теперь материалом его новой работы послужила война в Ираке. Опять в центре внимания двусмысленность ситуации, но, в отличие от черно-белой живописи Baader-Meinhof, здесь Рихтер сделал коллажи из 216 фрагментов собственной работы 87 года "No 648-2" и статей Frankfurter Allgemeine Zeitung за 20 - 21 марта 2003 года. В эти дни начиналась война в Ираке. Абсурдистский исторический "роман" "War Cut" издан Verlag der Buchhandlung Walther König. NYTimes публикует интервью с Герхардом Рихтером> |
| <<Отец небезизвестной Элизабет Тейлор в 63 году купил в семейную коллекцию "Приют в Сен-Реми" Ван Гога на Лондонском аукционе. И Тейлор считает себя законной владелицей картины, украшающей гостиную одного из ее особняков. Иной точки зрения придерживается потомок прежней владелицы, немки, у которой картина была изъята в нацистские времена> |
| <<Продолжение темы НЕОБХОДИМОСТИ ГАЛЕРЕЙ. Со знаком вопроса в Forbs опять публикуют текст ArtNewspaper на эту тему. На примере арт дилера в третьем поколении Сержа Циглера, который, не смотря на успешность своих художников, был вынужден закрыть одну из галерей и не собирается открывать новых. Изменение роли галерейных пространств, происходящее сейчас, рассматривается и на других примерах: от одного из самых успешных галеристов, Ларри Гагозяна до молодой Моник Мелош из Чикаго, предпочитающей показывать работы на складе, а предлагать онлайн. Акцент она сделала на участии в крупнейших ярмарках Art Chicago и Art Basel. И ее бизнес успешен. Статья большая. Резюме автора: "перефокусировка с репрезентации в галерейных пространствах на другие дилерские методы - плохая тенденция для художников, которые по-прежнему нуждаются в персональных выставках"> |

|
<<Художники YBA меняют привычное галерейное пространство на шумные и суматошные торговые площадки, например, Реза Арамеш "выступил" на автомобильном рынке. Как тут не вспомнить «Новую территорию искусства» компании Brainmade в торговом комплексе «Трамплин»> |

|
<<Лондонский ресторан Pharmacy утратил былую популярность, когда почти все знаменитости, попадая в Лондон, старались отметиться в нем. Как же, ведь в 98 году ресторан был оформлен ужасным "фармацевтом" Дамиеном Херстом. Ресторан закрылся, но отделение современного искусства Сотбис намерено выставить его убранство на торги, которые будут приурочены к ярмарке современного искусства Frieze Art Fair 15-18 октября. Диапазон эстимейтов огромен: от бокалов для мартини по 92-128$ за пару и "таблеточных" барных табуретов по 920-1200 за 6 штук до живописных бабочек, украшавших стены, по 550 000$. (сайт ярмарки не доступен... сегодня по крайней мере. ЮП)> |
| <<Делаются очередные закономерные шаги на пути "деньги-товар-деньги" в искусстве. Нью-Йоркский скульптор Sharon Louden собрала необходимые ей для очередного проекта 20 000 долларов продажей акций. Разумеется, она обещает акционерам доход от продажи скульптуры, сделанной на эти деньги. Стоимость акции - 100 долларов. Кое-кто купил на несколько тысяч> |

|
<<Экономика Зимбабве в тяжелейшем состоянии, страна - в числе лидеров эпидемии СПИДа. Как следствие, улицы полны полны бездомных детей. Под эгидой ЮНИСЕФ прошла серия уличных художественных практикумов для таких детей. Работы 10 из них сейчас выставлены в Национальной галерее Хараре> |

|
<<Крупнейшая для Австралии
кража произведений искусства
оборачивается конфузом. Похоже
украденное, оцененное поначалу в 67 млн.
долларов, включая 50 млн. за картину
Сезанна, оказывается
коллекцией подделок и копий. Вот так
вот, наслаждался некто, а ему - бац по
башке - не воры, нет, эксперты - профан вы,
батенька, полный. Но судя по тому, что
фигурант - реставратор, верноятней
другая версия. Мудрейшие обретают
социальный статус по дешевке. К чему
лишние траты, когда результат одинаков?
Вообще тема "Подпаска с огурцом" -
помните такого?, где Караченцев
подделывал Фаберже и вызывал восторги
искусствоведа, а объявил очередную
подделку своей работой и получил от нее (искусствоведа)
снисходительное полуодобрение с
подтекстом: "ну куда ты червячок
лезешь"... Тонкость хода была в том, что
герой Караченцева сделал это от любви-с,
понимал что дама сердца способна
полюбить только "большого художника"...
А признаться в "своих фаберже" не
мог - работал на отца дамы, сбывавшего
фальшак. И вообще оказалось, что
коллекцию свою отец этот нарастил в
блокадном Ленинграде, где был
счастливчиком "при пайках".
Сценаристы Лавровы использовали здесь
блокадные слухи, и касаются они совсем
не безвестных людей. ЮП> Пострадавший, однако, крепок. "В Австралии никто не в состоянии сказать, Сезанн это или нет" - говорит он. "Только Сотбис дадут заключение"> |
|
<<Андрей
Ковалев, Небо
алмазом - "РЖ". Подборка публикаций об открытии нового здания ГЦСИ (Завода). Далее: "Начну всем громко восторгаться, забуду про клеветническое прошлое. Негатив стану выжигать каленым железом. Даже не помыслю о том, что озвучивает Сергей Сафонов: "Современное искусство привлекательно для дилетантов - хотя бы потому, что чаще всего не опирается на универсальные критерии качества, выработанные в течение столетий. Из-за чего во многом загадочным остается механизм попадания в пантеон "лучших современных"; приходится доверять уже имеющимся авторитетам. Смекнув это, создатели Stella Art Gallery, поначалу не помышлявшие заниматься российским актуальным искусством и даже с негодованием отвергавшие предположения о возможности такой эволюции, оборудовали второе выставочное пространство неподалеку от станции метро "Тульская" ("Сыр выпал", "Газета" от 8.11.). Не вижу причин напоминать людям, что они едва-едва с куршавелевской горки свалились. Все движется в верном направле нии. Перемелется - мука будет. Первая выставка в новом помещении на Тульской выглядит шикарно, а патриархи концептуализма Андрей Монастырский и Вадим Захаров оказались художниками не просто буржуазными, а супербуржуазными. Даже включение в "конюшню" самой дорогой галереи революционера Анатолия Осмоловского наряду с Ильей Кабаковым свидетельствует лишь о том, что новый правящий класс начал заботиться о самосохранении и коррумпировать антисистемных интеллектуалов". "Еще один повод для восторгов - премия "Черный квадрат". Ее основала компания "Экспо-парк. Выставочные проекты", та самая, что проводит ярмарки "Арт-Москва". Можно бы заподозрить конфликт интересов, но в данном случае все сделано абсолютно чисто, тем более что "Арт-Москве" еще только предстоит стать коммерческой ярмаркой. Не станем обращать внимания на нелепую клевету, которая несется с BBC: "В отличие от аналогичной британской премии Тернера, лауреаты которой купаются в лучах национальной славы, в России эти художники остаются неизвестными""> |
|
<<Андрей
Ковалев, Болезнь
Истории и история болезни - "РЖ". Недавно имел разговор с Анатолием Осмоловским. Обнаружил, что этот глубоко наивный художник и очень милый человек лелеет надежды на то, что Власть и Деньги обратят наконец свое высокое внимание на современное искусство в целях украшения морды лица на мировой арене. На что мне пришлось ответить, что они сами для себя придумают свое собственное современное искусство. Современное по форме и очень национальное по содержанию. Процесс уже пошел, в связи с чем я порекомендовал товарищу Осмоловскому ознакомиться с моим обзором искусственной жизни, посвященным проекту "Deisis/Предстояние". Должен только прибавить: сей грандиозный проект имеет чисто внешнее сходство с соврискусством, поскольку его создатели категорически вытравили саму возможность аналитического подхода. Явление, которое на птичьем наречии именуется дискурсом современного искусства, все же подразумевает определенный уровень рефлексии над средствами производства и способами выражения. Но рефлексия, которая есть основополагающий фактор стилеобразования, в условиях нашей глянцевой стабилизации попадает под решительный запрет. Точно так же нельзя говорить о том, что проект является инструментом новых поисков идентичности. Следует различать природную адекватность аборигена и сложную и ускользающую самоидентичность Клода Леви-Стросса> |
| <<Китай официально допускает зарубежные аукционы искусства и антиквариата на свой рынок. С 11 декабря Кристи и Сотбис могут начать торги. Однако, не смотря на колоссальный и непрерывно растущий китайский рынок, менеджер Кристи пока осторожен в прогнозах. Он предполагает начать с автомобилей, но не с искусства. К тому же остаются протекционистские рамки - ArtNewsPaper не может назвать точное ограничение возраста предметов продажи: 1911 или 1949 год> |

|
<<В Берлине все-таки
будет
восстановлена часть Стены, в районе
знаменитой Checkpoint Charlie. Не взирая на
достаточно серьезную критику. На снимке
памятники 1065 погибшим при попытке бежать в
Западный Берлин. Об этом же - Гардиан> |

|
<<Абстрактное искусство может стать религиозным искусством XXI века. Во всяком случае, так считает отец Джо Уолш из Белфаста. Подробнее> |

|
<<28 октября опубликован
очередной ART POWER TOP 100 (журнал
Art Review). Вот первые 10 персонажей (источник BBC). 1 Larry Gagosian (dealer/gallerist) 2 Glenn Lowry (museum director) 3 Sir Nicholas Serota (director of Tate galleries) 4 Maurizio Cattelan (artist) 5 Sam Keller (fair director) 6 Dakis Joannou (collector) 7 Bill Ruprecht (auction house) 8 Ronald Lauder (collector) 9 Robert Storr (curator) 10 Takashi Murakami (artist) Саатчи с 6-го места съехал на 17. Среди художников место Герхарда Рихтера занял Маурицио Каттелан, а удержался в 10-ке Мураками. Damien Hirst, не смотря на сверхудачный аукцион Pharmacy уже не 49-й, а 78-й, хотя может быть благодаря аукциону вообще остался в этой сотне. |
|
Прошлогодний
TOP100: 1 Ronald Lauder, US billionaire and collector 2 Francois Pinault, owner of Christie's auctioneers 3 Nicholas Serota, director of Tate galleries 4 Larry Gagosian, US gallery owner 5 Gerhard Richter, German painter 6 Charles Saatchi, art collector and gallery owner 7 Takashi Murakami, Japanese artist and designer 8 Maja Oeri Hoffmann, president of Swiss art foundation 9 Leonard Lauder, art collector 10 Dakis Joannou, Greek art collector (дантист Херста) |
| <<АПН. 25 октября. <нашел лишь на английском> Эксперты MARSH Moscow broker agency оценили наш рынок современного искусства в 5-10 млн. долларов в год. Антикварный - в 1.5 млрд. Одной из главных проблем является фактическое отсутствие системы страхования произведений искусства, что, в свою очередь, определяется господством подделок на антикварном рынке. MARSH уверяет, что таковых 80%. В прошлом году учреждена компания Art Consult, уже признанная Lloyd's of London. |

|
<<В New Museum of Contemporary Art (Челси, NY) - до 13 ноября небольшая выставка "Rules of Crime" британцев Heath Bunting и Kayle Brandon. С большим резонансом. Во всяком случае обозревателя NY Times эта выставка подтолкнула к пространным размышлениям о возрастающем числе художников, осваивающих технологии, по сей день являвшиеся прерогативой правительств и корпораций. |
|
Bunting и Brandon предлагают инструмент, с
помощью которого люди могут поменять
собственную идентичность, тем самым
демонстрируя потенциальную угрозу "артистического
хаоса", который возможен в результате
подмены информации в многочисленных базах
данных, содержащих все большее число
элементов виртуальной идентичности
граждан информационно развитых
стран. Музейный проект выключает модельные,
"артистические базы данных", однако
обозреватель советует художникам
обзаводиться серьезными
квалифицированными адвокатами, которые бы
помогли им балансировать на тонкой грани,
разделяющей артистическую экспрессию и
криминальную деятельность. В приглашении на вернисаж авторы проекта написали: "Наш проект для тех, кто жаждет изменений <идентичности>. Например, бездомный может делать карьеру в банковском менеджменте, а 32-летняя американка может стать пакистанским подростком мужского пола". Искусство со времен Возрождения экспериментировало с ложной и альтернативной идентичностью: Рембрандт - в библейских сюжетах, Синди Шерман - в медийных архетипах. По мнению обозревателя NYTimes британская пара доводит эксперимент до "полного кошмара": "переноса" через национальные границы или проникновения в банковские системы - и это еще слабые примеры в сравнении со сменой идентичности. |
| Как тут не вспомнить проект 5-летней (!) давности героической Намнияз Ашуратовой, безвременно приконченной Андреем Великановым. Тоньше, элегантней, да еще и с игрой не с чьей-либо, но с собственной идентичностью. Но... может быть все это было слишком "впереди паровоза", который в данный момент имеет англо-американскую идентичность :)? ЮП > |
| <<"...Юрий Михайлович вышел на площадку, где ранее находилась гостиница "Москва", и сердце его восхитилось. Согласно сообщению ИТАР-ТАСС, этот душевно тонкий человек сказал, что ему "становится не по себе от красоты". И повелел своим присным не строить на этом месте ничего, ибо "на образовавшемся пустом месте хорошо бы смотрелась величественная площадь. И ее непременно полюбили бы москвичи и гости столицы". Убежден, что сей изощренный подарок москвичам Лужков сделал, находясь под впечатлением от кончины своего интеллектуального наставника Жака Дерриды." - Андрей Ковалев, Себе воздвиг - РЖ - "...людей, которые не прониклись госполитикой реконструктивизма, по правде говоря, еще много осталось. Например, Давид Саркисян в интервью "Новым Известиям" произносит конфуцианскую бессмыслицу: "Можно принять очень хорошие законы, но если контроль за их выполнением будет осуществляться теми же людьми, которые будут продавать памятники к это происходит сейчас в Москве), для архитектуры это означает гибель". Не понимает товарищ, что как раз законы, которые ничего не меняют, и есть высшая цель правителя, придерживающегося принципов недеяния. А гибель архитектуры - вещь просто восхитительная для истинного эстета. Я вот недавно полчаса любовался прекрасными разводами, возникшими на стене одной элитарной постройки, которая являла собой отличный пример доскональной реконструкции с подземной автостоянкой."> |
| <<Cтатья о Еве Хессе в корейской Herald - "Красивая женщина, но художник лучше"> |
|
<<Появились искушенные
инвесторы, для которых "добавить голубых
фишек в инвестиционный портфель"
означает приобрести живопись Джаспера
Джонса или шелкографию Энди Уорхола. И
банки кредитуют таких инвесторов. Однако,
"'очень мудреный вид инвестиций" -
авторитетно заявляет Mary Hoeveler, бывшая
сотрудница Christie's, а теперь возглавляющая Art
Advisory Service, подразделение Citigroup
Inc.'s; - "он совершенно не подходит не
достаточно эрудированным и не вполне
понимающим арт рынок". В последнее время
арт рынок растет, и по мнению Hoeveler бум
последних 3-х лет инспирирован именно искушенными
в искусстве инвесторами. Подробнее
- Boston. Business> <<Investors.com приводит данные Artprice.com об индексе цен на работы современных художников c 1997 по сентябрь 2004: -Gilbert & George +193%, -Warhol Andy +171%, -Wesselmann Tom +259%, -Chagall Marc +56% etc Глобальный индекс цент за этот период - + 48%> |
| <<"Чарльз Саатчи возвращает живопись" - А.Раппапорт, ГЦСИ.В угадайку сыграть, что ли? Кто такой Раппапорт?> |
| <<В солидном журнале Tate Etc статья "Семь лиц арт вандала". Под первым, "Иконоборец" две наших выставки: "Осторожно, религия" в Сахаровском центре и питерская в галерее "S.P.A.S.". В "Радикалах" - поразительно - никого из наших не упоминают. "Буржуа" - самый последний пример - 44-летний борец с инсталляцией Каттелана, отпиливший ветку дерева, на котором была подвешена одна из кукол Каттелана, и рухнувший при этом на землю, прямиком в госпиталь. "Знаток", "Авангардист", "Неудавшийся художник" и "Сумасшедший". Последние с завидной для других категорий вандалов периодичностью атакуют музейные шедевры> |
| <<В издательстве Йельского университета вышла книга Марка Ротко "The Artist's Reality: Philosophies of Art". NYTimes. 17 долларов на Amozon.com> |
| <<"...переформатированное Министерство культуры и массовых коммуникаций строит в официальном докладе свою стратегию отнюдь не на слове "цивилизованность", к примеру, а на слове "патриотизм". Для достижения надлежащего градуса патриотизма нужна, как выясняется, "мобилизация потенциала творческой интеллигенции в целях создания образов положительных героев" и "содействие созданию произведений искусства, воспитывающих патриотизм, нравственность и поддерживающих общественную мораль". Глубоко упакованная в вату линялых слов суть мне не чужда, но достичь желаемого посредством деятельности, облеченной в такие слова, не-воз-мож-но" - Вячеслав Глазычев, De Gustibus, РЖ> |

|
<<Очередной успех BBC - программу Rolf on Art (ведущий Rolf Harris) посмотрели более 7 миллионов зрителей. Британский, а возможно и европейский рекорд для передач об искусстве> |

|
<<С
1 октября по 5 декабря в Севилье
1-я Международная биеннале современного
искусства. Комиссар 1 BIACS Харольд Зееман,
и в этом уже половина победы. Организаторы
даже в разделе сайта Artists указали коротко и
ясно "List of artists and works proposed by
Harlad Szeemann". И все дела. Однако ArtDaily
сообщает о хедлайнере Биеннале "палаче
и членовредителе" Маурицио Каттелане,
перевесившем "своих
мальчиков" из
Италии в Испанию> |

|
<<Каттелан
шокировал испанцев в не меньшей степени, чем
итальянцев. Микаэлла Наварро, одна из
руководителей Андалузии пока выдерживает
прессинг - многие требуют избавить
зрителей от "экcтремального насилия". В
интервью испанскому телевидению она
заявила, что надо уважать право
художника на высказывание. Аэмоциональное лицо мальчика - лицо десятилетнего Маурицио> "Как может общество быть настолько лицемерным, что не приемлет повешенной куклы, тогда как чуть ли не ежедневно видит картины умирающих реальных детей" - вопрошает арт директор Juana de Aizpuru> |
 |
<<В пятницу 8
октября на 75 году жизни в парижском
госпитале скончался философ Жак Деррида. Деррида родился 5 июля 1930 г. в еврейской семье, проживавшей тогда в Эль-Биаре, пригороде г. Алжир. Он приобрел мировую известность, опубликовав в 1967 г. сразу три книги - "О грамматологии", "Голос и феномен", "Письмо и различие", в которых были заложены основы деконструктивизма - одного из самых значительных философских направлений XX века. |
|
<<"Даже тому
факту, что сегодня на многих улицах Парижа
не так просто встретить человека в
европейской одежде и европейской внешности,
французы более всего обязаны именно
Дерриде. Именно он стал интеллектуальным
лидером борьбы за права эмигрантов из Азии
и Африки. Именно он долгие годы доказывал
французам, что европейская культура не
имеет никаких преимуществ перед арабской
или африканской. И, в общем, доказал". "У
нас весь ХХ век состоял из деконструкций. И
недоверие к любой истине в последней
инстанции нашло у наших доморощенных
лагерных философов такую чеканную и
тотальную формулу, что Дерриде и не снилось: "Не верь. Не бойся. Не проси" - Е.Холмогоров. "Жака Дерриду читали, им восхищались, публиковали, и обсуждали во всем мире. Он останется в нашей памяти первооткрывателем и невероятно плодовитым мэтром" - президент Франции Жак Ширак"> <<Он родился в 1930 году в Алжире, преподавал в Сорбонне и американских университетах - Российская газета> <<Смерть - это всего лишь слово - Время новостей> <<Философ Жак Деррида скончался от рака - NewsProm.Ru> <<Умер величайший философ современности - Утро.ru> <<Библиография Jacques Derrida> <<Жак Деррида во Французской библиотеке> <<Жак Деррида в Интернете> |
| <Вторая часть Stella Art откроется в годовщину рождения галереи, 26 октября. Среди первых приглашенных художников-россиян -- мэтры концептуализма Андрей Монастырский, Вадим Захаров, тот же творческий тандем Илья и Эмилия Кабаковы, а также младоконцептуалисты, те, кто пока учится «на старших глядя». |
| <<Британцы, похоже, первыми пробуют практически распутать тупиковую ситуацию с копирайтом. Для любого активно работающего с цифровыми технологиями очевидно, что разрыв между по сей день действующими законами об авторском праве и практическими реалиями растет из года в год. Подавляющее большинство сейчас в той или иной степени нарушают закон. То есть все понимают, что пора уж "в консерватории что-то подправить", однако свойства юристов не исчерпываются казуистичностью, но извечно дополняются тяготением в сторону получателей доходов. Любое правило оттеняют исключения. Профессор права Стенфордского ун-та Лоуренс Лессиг, главный идеолог британской системы Creative Commons - из тех, кто пытается разработать систему лицензирования нового типа. Не так много "игроков" из числа правообладателей уже включились в некоммерческую систему Creative Commons, но профессор уверен, надо двигаться в этом направлении. Исходя из элементарного прагматизма. Очевидно есть некий компромисс между бесперспективными консервативной и анархической крайностями отношения к системе копирайта> |
|
<<Андрей
Ковалев среагировал на
юбилей "Бульдозерной выставки" со
значительным опозданием, 1 октября
опубликовав в "РЖ" один из лучших
своих пресс-миксов с комментариями, "Бульдозер
и мутанты". Цитировать его - полная
глупость, учитывая "органайзерный"
жанр, но никак нельзя не отметить одно
обстоятельство. Личная позиция едва ли не
лучшего нашего арт критика упирается
сегодня в большой знак вопроса - "Официально
заявляю, что мое место - рядом с теми, кто
лезет под бульдозер. Меня не смущает
фатальная бессмысленность и обреченность
такой пиар-технологии. Но все же как-то
криво получается - героизм пятой колонны и
пафос нонконформизма грубо используются
некоей третьей стороной. Что делать?!" ...
"Печальная правда - в том, что любое
сопротивление будет провалено тупыми
Суперменами. В ситуации непрерывной
мутации объекта и субъекта эстетического
жеста потребны мутанты, новые люди X,
которые изменяются быстрее, чем сама
действительность." <<Плакат Беляевской выставки 15 сентября 1974 года - здесь> |
АРТ ПЕРИОДИКА - 3 часть <вернуться к 1-й> <вернуться ко 2-й> <перейти к 4-й> <перейти к 5-й>
e-mail: Пластинин Юрий